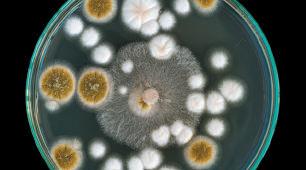
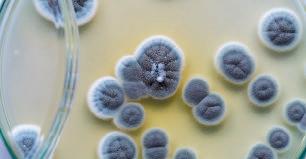

ISBN 978-617-09-4362-0

![]()
ISBN 978-617-09-4362-0

Шановні десятикласники, цього року ви
вивчатимете такі теми біології:
• Біорізноманіття
• Обмін речовин і енергії
• Спадковість і мінливість
• Репродукція та розвиток
Увесь необхідний матеріал ви знайдете у підручнику. Його поділено на чотири розділи відповідно до тем, що будете вивчати.
Підручник побудовано таким чином, щоб вам було зручно з ним працювати. Погортайте сторінки і ознайомтеся з його структурою.
1. Кожний параграф розташований на
одному розвороті. Увесь матеріал одного уроку — перед очима. Крім того, таке розташування полегшить пошук потрібного параграфа.
2. На початку кожного параграфа перелічено теми, які необхідно пригадати, перш ніж вивчати новий матеріал.
3. У деяких параграфах, де це необхідно, наведено практичні роботи,
4. Закінчується кожний параграф двома рубриками:
• «Ключова ідея» — це головна думка, висновок;
• «Запитання та завдання» — компетентнісні завдання.
5. Багато інформації наведено у вигляді схем, таблиць, ілюстрацій. Вони полегшать сприйняття й запам’ятовування нового матеріалу.
6. Кожний розділ закінчується узагальнюючим розворотом, у якому стисло подано інформацію,
підручника ви знайдете:
ник термінів, інформацію
тестові завдання до тем та інші додаткові матеріали.
Як працювати з електронним додатком
1. Зайдіть на сайт interactive.ranok.com.ua
2. Зареєструйтеся.
3. Знайдіть розділ «Підручники».
4. Виберіть назву підручника «Біологія і екологія (профільний рівень). 10 клас».
5. У розділі «Електронні матеріали до підручника» виберіть потрібну тему та натисніть «Розпочати роботу».

Поміркуйте
Як ми зможемо відрізнити живе від неживого?
•
•
•
•
Біологія як наука
Термін «біологія» в його сучасному значенні запропонував французький учений
Жан Батист Ламарк 1802 року. Біологія (від давньогрец. bios — «життя», logos — «учення») — це наука про життя. Як і будь-яка інша наука, біологія має об’єкт, який вона вивчає, і методи, якими вона користується
для його вивчення. Крім того, біологія має власний понятійний апарат — сукупність термінів і понять, які використовують уче-
ні-біологи у своїй роботі. Об’єктом вивчення біології є всі живі організми та різноманітні аспекти їхньої життєдіяльності. Живих організмів на нашій планеті, як і аспектів їхньої життєдіяльності, багато. А ще є вимерлі організми, які також є об’єктами вивчення біології. Тому сучасна біологія стала справжньою системою наук, у якій виділяють багато галузей. Ціла низка галузей
біології вивчають внутрішні процеси в живих організмах. Це, наприклад, фізіологія рослин і фізіологія тварин. Біохімія вивчає перебіг хімічних реакцій у живих організмах. Цитологія досліджує особливості будови клітин, а гістологія — тканин. Генетика досліджує спадковість
сукупності живих організмів, їхні об’єднання, які утворюються в тих чи інших умовах. Це популяційна генетика (вивчає генетичні процеси в популяціях), біогеоценологія (досліджує біогеоценози) та інші.
Екологія як наука
Термін «екологія» запропонував німецький учений Е. Геккель 1866 року. Він походить від грецьких слів eikos, що означає дім, помешкання, місце перебування, та logos — наука. Так Геккель назвав науку, що вивчає організацію та функціонування надорганізмових систем різних рівнів, видів, популяцій, біоценозів і біосфери. Спочатку цей термін застосовували, коли йшлося про вивчення взаємозв’язків між рослинними та тваринними угрупованнями, що входять до складу стійких та організованих систем, які виникли у процесі еволюції
Наявність обміну речовин
розмноження
Здатність до розвитку Усі живі системи протягом індивідуального існування
життя
1.
2.
та вкажіть, які об’єкти вашого дослідження є живими
3.
Згадайте
• Неживі й живі системи
• Приклади живих систем різного рівня організації
Біологічні системи
Система — це ціле, що складається зі
взаємопов’язаних частин (елементів). Біологічними системами називають системи, до складу яких входять живі організми. Властивості системи не зводяться до суми властивостей її складових. Сукупність складових, які утворюють систему, має властивості, не притаманні жодному з її окремих елементів (так званий системний ефект). Наприклад, такі живі системи, як клітини, є живими лише як результат взаємодії їхніх складових (органел, цитоплазми, мембран). А кожний з цих елементів, виділений окремо, живим бути не може.
Окремі біологічні системи можуть об’єднуватися, утворюючи складніші системи. Так, окремі клітини, об’єднавшись, утворюють багатоклітинний організм. А популяції різних видів живих організмів можуть брати участь в утворенні екосистеми. Такі послідовні об’єднання дедалі складніших біологічних систем є основою різнорівневої організації живих організмів. Всі частини біологічних систем
вищі існування й утворюють з
єдине ціле (мал. 2.1). Будь-яка екосистема має два головні компоненти — біотичний і абіотичний. Біотичний компонент екосистеми — це
ється з автотрофних та гетеротрофних

організації. Як ви знаєте, живі організми складаються з багатьох органічних молекул — білків, вуглеводів, жирів, нуклеїнових кислот. Це і є першим рівнем організації
життя — молекулярним. Біологічні
молекули об’єднуються у складніші структури — клітини, які є наступним рівнем організації — клітинним.
Клітини в багатоклітинних
організмах не існують самі по собі. Вони об’єднані в більші структури — тканини й органи.
Це тканинно-органний рівень
організації. А тканини й органи
об’єднуються у складі організму, утворюючи організмовий рівень
організації.
Але і це ще не все! Організми
не живуть самі по собі. У межах
певних територій вони утворюють
групи особин свого виду — популяції, які є складовими частинами
популяційно-видового рівня організації. Популяції ж окремих видів взаємодіють з популяціями інших
живих організмів, які живуть разом з ними. У такий спосіб вони утворюють екосистеми — складові
екосистемного рівня організації.
І, нарешті, всі екосистеми нашої
планети об’єднуються у складі
біосфери, яка є найвищим рівнем
організації живих систем. Слід зауважити, що не всі
живі системи мають однакову кількість рівнів організації. Так, одноклітинні організми не мають тканинно-органного рівня, а у вірусів відсутній ще й клітинний рівень.
Молекулярний
Групи атомів, об’єднаних у молекули Клітинний
Молекули та органели клітин





Тканинноорганний
Організмовий
Клітини, тканини й окремі органи живих організмів
Системи органів живих організмів

Популяційно-видовий
Екосистемний
Особини окремих видів живих організмів

Популяції різних видів живих організмів


Поміркуйте
Різноманіття середовищ існування організмів Частина
існування. У попередніх класах ви вже дізналися, що існують водне, наземне та повітряне середовища існування. Особливими середовищами існування є ґрунт та живі організми
• Внутрішнє середовище організму
• Середовище існування
• Основні види середовищ існування
•

антропогенного походження. Штучні середовища створюються
використані людиною в різноманітних господарських або наукових цілях. До штучних середовищ належать поживні середовища для вирощування мікроорганізмів у
між собою, впливу організмів на стан середовища (наприклад, формування особливих мікрокліматичних умов у лісовому масиві) тощо.
Підтримання гомеостазу на прикладі організму людини
Підтримання гомеостазу організму людини можливо за умов відносної стабільності кількох параметрів його внутрішнього середовища. Параметри внутрішнього середовища організму людини, які є важливими для підтримання гомеостазу:
• кров’яний тиск (у дорослої
людини — 120/80 мм рт. ст.);
• температура тіла (35,5–37 ºС);
• рН крові (7,3–7,45);
• концентрація гормонів;
• концентрація кисню та карбон(ІV)
оксиду в крові;
• концентрація глюкози в крові;
• концентрація солей мінеральних речовин у рідинах організму.
Це забезпечується діяльністю трьох регуляторних систем: нервовою, гуморальною та імунною. Нервова й гуморальна системи регулюють і координують роботу органів, а імунна захищає організм від порушень, які можуть спричинити інші організми або шкідливі речовини.
Нервова регуляція здійснюється за допомогою імпульсів, що передаються по мембранах нервових клітин, тоді як гуморальна система регулює процеси в організмі за допо-
могою спеціальних хімічних речовин — гормонів. Взаємозв’язок двох типів регуляції проявляється в тому, що нервова й гуморальна системи впливають одна на одну. Так, нервова система
Імунна
• Галузі біології
• Наукові теорії в галузі біології та екології
• Внесок учених, які створили ці теорії Згадайте
Наука. Наукові гіпотези та теорії
Наука — це сфера діяльності людини, яка присвячена здобуттю нового знання про
навколишній світ. Основою наукового пізнання є побудова системи достовірного знання, що ґрунтується на фактах. Фактом є спостереження або експеримент, який може
бути відтворений та підтверджений. Проте тлумачити одне й те саме спостереження різні вчені можуть по-різному.
На основі аналізу фактів сформовано гіпотези — обґрунтовані припущення, які
ці факти пояснюють. Якщо нові факти не
підтверджують гіпотезу, то висувають нову
гіпотезу. Якщо ж гіпотеза добре узгоджується з наявними фактами й дозволяє робити прогнози, що згодом підтверджені, то вона
стає основою наукової теорії. Наукова теорія — це система узагальнених знань, яка пояснює наявні факти, формулює загальні закони, яким ці факти підпорядковуються, і дозволяє передбачати невідомі раніше явища (мал. 4.1). Але виникнення наукової теорії не означає, що вона є вічною. Нові дані, отримані в майбутньому, можуть потребувати її корекції. Емпіричні дослідження Для отримання нових фактів та формування гіпотез і теорій сучасна біологія використовує різноманітні наукові методи.
суттєвою перевагою цього методу. Якщо спостереження здійснюють за окремим біологічним об’єктом, то такий тип спостереження називають описовим. Якщо ж під час спостереження працюють одразу з кількома об’єктами, а потім порівнюють результати, то такий тип спостереження називають порівняльним. Перевага описових досліджень полягає в тому, що на об’єкт спостережень ніяк не впливають. Але в цьому випадку важко визначити роль різних факторів у перебігу певних природних процесів.
фактори незмінними. Недоліком такого підходу є те, що штучно створені умови експерименту можуть позначатися на нормальному функціонуванні біологічних об’єктів. В експериментальному методі досліджень зазвичай застосовують контроль (контрольний дослід). Його здійснюють у тих самих умовах, що й експеримент, але виключають дію фактора, який досліджують. Таким чи-
ном, порівнюючи результати контролю й експерименту, можна виокремити дію фактора, який вивчають.
Теоретичні дослідження У разі застосування теоретичних методів з об’єктом дослідження безпосередньо не
працюють, а вивчають його фізичні чи математичні моделі. У теоретичних методах виділяють моделювання, математичну обробку даних (статистичний метод) тощо.
Математичну обробку даних здійснюють після закінчення спостереження або експерименту. Вона дозволяє на основі отриманих даних з’ясувати зв’язки між окремими
параметрами біологічних систем, вивчити вплив окремих факторів на біологічні системи та особливості їхньої взаємодії.
Основою моделювання є створення певної теорії щодо певної біологічної системи, що містить правила, за якими відбуваються зміни в біологічних аналізованих системах. Після створення такої теорії задають
початкові параметри (тобто визначають по-
чатковий стан системи). Потім, зазвичай з використанням потужних комп’ютерів, роблять аналіз — як буде змінюватися система у випадку дії правил висунутої теорії.
Результати зіставляють з реальними факта-
ми для наявних біологічних систем. Якщо
відхилення від природних процесів незначні, то в теорію і модель вносять невеликі прав-
Згадайте
• Науковий метод пізнання
• Експеримент
• Спостереження
• Моніторинг
• Основні методи біологічних досліджень
Планування дослідження
Планування — найважливіший елемент наукових досліджень, що становить низку послідовних етапів роботи. Під плануванням розуміють визначення цілей, завдань і об’єктів досліджень, розробку схеми експерименту, вибір оптимальної структури досліду й ділянки для його проведення.
Структуру планування можна поділити на два етапи.
На першому етапі планування відбувається:
• вибір теми;
• визначення актуальності досліджень;
• формулювання цілей і завдань досліджень;
• вибір об’єкта або об’єктів досліджень;
• збирання й критичний аналіз наявної інформації з досліджуваної проблеми;
• формулювання й висування робочих гіпотез (теоретичних моделей).
На другому етапі планування відбувається розробка програми досліджень.
•
•
Формулювання проблеми, мети і завдань дослідження
Вибираючи тему дослідження, слід керуватися такими критеріями, як актуальність, новизна, перспективність. Проблема, для розв’язання якої здійснюють наукове дослідження, має бути чітко й однозначно визначена. Якщо вона не може бути сформульована, то вона не може бути й розв’язана. Усвідомивши проблему, слід визначити задачі, відповіді
або ефекти, що мають бути оцінені.
час
обмежитися рамками саме того питання, на яке бажано отримати відповідь. Бо витрачання наявних ресурсів і часу на розв’язання інших питань може стати причиною того, що завдання дослідження не будуть виконані.
Визначення об’єкта та предмета дослідження
Об’єктом дослідження є те, на що спрямована пізнавальна діяльність дослідників. У біології та екології об’єктами досліджень є біологічні та екологічні системи. А предметом дослідження


Предмет дослідження
крокодила, кавове дерево або фінікову пальму.
Вивчення наукової літератури є важливим етапом роботи, що дозволяє уникнути непотрібного дублювання. Власне кажучи, формулювання теми, цілей і завдань дослі-
дження та вибір об’єкта й предмета дослі-
дження неможливі без знання наявних у цій сфері наукових даних. Необхідно добре знати, що саме
2.
3.
Практична робота
2.
3.
4. Сформулюйте висновок.
Поміркуйте
Згадайте
• Принципи проведення наукових досліджень
• Методи біологічних та екологічних досліджень
• Відмінності між емпіричними та теоретичними дослідженнями
Принципи аналізу наукових результатів
Аналіз результатів становить головний
науковий сенс будь-якої роботи. Він полягає, власне, в поясненні тих результатів, які були отримані в ході роботи. Часто для пояснення результатів автор висуває якусь гіпотезу.
Основними принципами аналізу результатів дослідження є такі:
— пояснення повинно бути обґрунтованим; — результати експериментального дослідження необхідно статистично обробляти;
— під час проведення аналізу необхідно розглядати можливі альтернативні варіанти пояснення отриманих результатів;
— аналізувати слід усі отримані результати (навіть ті, які не збігаються з гіпотезами автора дослідження).
На основі аналізу результатів роботи необхідно сформулювати висновки, з яких буде видно, чи було досягнуто мети, поставленої на початку роботи.
Крім того, ілюстративні матеріали добре показують розуміння авторами біологічного змісту своїх досліджень. Саме за допомогою ілюстративного матеріалу можна одразу побачити як переваги, так і недоліки певної роботи.
Основні види наукових творів
Наукові твори поділяють на дві основні групи — рецензовані й нерецензовані. Рецензованими є твори, які перед публікацією перевіряють на новизну результатів, об’єктивність проведеного дослідження, відсутність помилок, правильність виконання аналізу отриманих даних, адекватність висновків тощо. Нерецензовані твори в такий спосіб не перевіряються.


Наукометричні бази даних
Наукове дослідження буде мати цін -
ність лише за умови, якщо його результати будуть використовуватися. Найкращим
показником використання результатів ро-
боти є його цитованість. Під час виконання будь-якого дослідження звертаються до робіт ученої спільноти, яка працює у цій
галузі. Публікуючи результати, вказують, результати яких робіт враховували під час планування свого дослідження та аналізу
його результатів. Для цього в кінці будьякого наукового твору міститься список літератури.
Якщо чиясь робота має важливе значення, то на неї посилаються часто (вона має
високий індекс цитування). Для того щоб
зрозуміти, наскільки часто посилаються на
конкретну роботу, створюють спеціальні наукометричні бази даних.
Наукометричні бази даних — це бібліографічні й реферативні бази даних, які мають спеціальні
опубліковано
of Science.
насінин соняшника, кількість зерен у колоску пшениці
2.
3.
Практична робота
2.
3. Визначте їхні недоліки й переваги.
4. Сформулюйте висновок, зазначивши, яке значення у практичній
Поміркуйте
У своєму романі «Мобі Дік» Г. Мелвілл наполягав, що кити є рибами. Ми знаємо, що це не так. А чи можна застосувати інший варіант систематики, щоб Г. Мелвілл виявився правим? Поясніть.
Згадайте
• Тварини • Рід • Царство • Рослини • Вид
Розділи біологічної систематики
Біологічна систематика — це розділ біо-
логії, який формує єдину систему живого світу на основі виділення біологічних таксонів (систематичних одиниць) і відповідних назв, наданих за певними правилами (біологічної номенклатури). Основні систематичні категорії ввів у науку шведський учений Карл Лінней. Біологічна систематика поділяється
на два основні розділи: таксономію та біологічну номенклатуру.
Таксономія займається розробкою пра-
вил групування живих організмів. Це дуже складна проблема, бо часто не зовсім зрозуміло, на основі яких ознак слід об’єднувати
організми у групи. Так, у давнину всіх червів
об’єднували в один тип. Але сучасні дослідження показали, що різні групи червів мають різне походження і не є близькими родичами.
номенклатура розробляє пра-
найменування живих організмів, ство-

ні (формальні) та природні (філогенетичні). Штучними (формальними) називають системи, в яких класифікація видів базується лише на ступені їхньої подібності за вибраними ознаками. При цьому не враховується історична спорідненість організмів, які
ма Карла
(1758 р.), у якій рослини і тварини отримали статус царств (мал. 7.1). Але вже тоді стала зрозуміла значна відмінність грибів, і вони були виділені в окреме царство Отто фон Мюнхгаузеном (1763 р.). Щоправда він об’єднав

Мал. 7.1. Система


У
першій половині XX ст. внаслідок розвитку методів мікроскопії стала зрозумілою різниця між прокаріотами та еукаріотами. У системі Герберт Копленд (1938 р.) було виділено чотири царства: Монери (дроб’янки), Протоктисти (нижчі еукаріоти), Тварини і Рослини.
У 1959–1969 роках американський дослідник Роберт Уайттейкер удосконалив цю систему, виділивши гриби в окреме царство (у системі Г. Копленда їх відносили до царства
Протоктисти) (мал. 7.5). Ця система була найбільш поширеною до 80–90-х років XX століття, поки нові технології в цитології та молекулярній біології не дозволили створити сучасну систему класифікації живих організмів.
Принципи сучасної класифікації організмів Сучасна наукова класифікація повинна
відображати еволюційні зв’язки між живими організмами та вказувати на рівень їхньої спорідненості. Крім того, вона має бути зручною для використання і дозволяти легко
включати нові, нещодавно відкриті види. Основною систематичною категорією є
вид. Видова назва складається з двох латинських слів (бінарна номенклатура), перше з яких є назвою роду, а друге — видовим епітетом. Споріднені види об’єднуються


Практична робота
2.
3.
Не так давно систематики вирізняли дві окремі родини — Люди і Людиноподібні мавпи. Але зараз їх об’єднали в одну родину, врахувавши, що останній спільний предок усіх представників родин жив 15 млн років тому, а останній спільний предок людини і шимпанзе — 8 млн років тому. Чому? Поміркуйте Еволюційна таксономія та кладистика
поширення еволюційної теорії
еволюційної таксономії. Згідно з цією концепцією, система класифікації повинна була відображати хід еволюції живих організмів. Ця точка зору переважає в науці
й зараз. Тому сучасні системи класифікації
мають обов’язково враховувати спорідненість різних груп організмів. Для створення сучасних класифікацій
живих організмів учені частіше використовують принципи кладистики. Кладистика — це
підхід до біологічної класифікації, за якого
організми класифікують згідно з їх порядком
підходу складніше створювати систематику груп в еволюції, у яких мав місце симбіогенез (наприклад, під час утворення хлоропластів в еукаріотів). Складність створення
прикладі класифікації птахів і плазунів (мал. 8.1),
mono — один, poli — багато). Монофілетичні таксони об’єднують нащадків одного предка, а поліфілетичні — різних, довільно обраних нащадків декількох предків. Наприклад, клас Однодольні є монофілетичним таксоном, а царство Рослини, яке було виділено Р. Уайттейкером,— поліфілетичним, бо воно об’єднує декілька неспоріднених груп (бурі водорості, червоні водорості, зелені рослини тощо). Виділяють
а об’єднання всіх інших мавп цього ряду в інфраряд Мавпоподібні утворить монофілетичний таксон. У сучасній систематиці поліфілетичні таксони вважаються неприйнятними. Якщо вдається довести, що група є поліфілетичною, систематики її ліквідовують або ж змінюють
її межі, щоб виключити з неї неспорідне-
ні види. Так, у минулому були ліквідовані такі групи, як Безхребетні й Таємношлюбні, а в останні роки суттєво змінилися межі царств Рослини, Гриби і Тварини.
Таксономічна ієрархія
Таксономічна ієрархія — це розташу-
вання систематичних груп за порядком супідрядності, тобто включення одних груп до складу інших. Порядок ієрархії для основних систематичних категорій є таким:
Домен → Царство → Відділ (Тип) →
→ Клас → Порядок (Ряд) → Родина → Рід → → Вид
Так, вид Людина розумна включається до складу роду Людина разом із видами Людина неандертальська, Людина вміла тощо. Рід
Людина входить до складу родини Гомініди разом з родами Шимпанзе, Горила й Орангутан. Родина Гомініди входить до складу ряду
Примати, який є складовою класу Ссавці.
Дводишні, інфраклас Сумчасті.
Філогенетика
Філогенетика — це одна
матики, яка встановлює
як сучасних, так і вимерлих.
Для дослідження філогенезу
технології. Особливо ефективними є методи галузі молекулярної біології та генетики й мікроскопічних досліджень. Також широко використовують математичне моделювання й побудову філогенетичних дерев. Філогенетичне дерево — це схема, яка відображає еволюційні зв’язки між таксонами, для яких воно будується. Філогенетичні дерева можуть будуватися не тільки для таксонів живих організмів. Їх можна створювати, наприклад, для певних
Клас Ссавці входить до складу типу Хордові, царства Справжні тварини, домену Еукаріоти. У тих випадках, коли систематика групи є складною, основних систематичних категорій може бути недостатньо. У таких випадках використовують так звані вставні категорії. Назви вставних категорій утворюються від назв основних
Згадайте
• Систематична категорія • Рід
• Бінарна номенклатура • Вид
Концепції виду Базовим таксоном сучасна систематика вважає вид. Складність поділу живих істот на види полягає ще й у тому, що саме визначення поняття «вид» є доволі складним. І залежить воно від того, яка з концепцій виду використовується в певному випадку. У більшості випадків для виду використовують таке визначення: вид — це сукупність популяцій особин, подібних між собою за будовою, функціями, місцем в угрупованнях організмів, що населяють певний ареал і вільно схрещуються між собою у природі.




особини виду порівнюються з еталонним зразком. Ця концепція дуже незручна для видів, особини яких можуть сильно відрізнятися за зовнішніми ознаками, наприклад собака домашній, коні (мал. 9.1)
Це група особин, яка визнається формальною класифікацією і становить певний етап розвитку певної еволюційної лінії Ця концепція розглядає вид як чисто теоретичне
і внутрішньої будови організмів одного виду та її відмінність у різних видів У людини більший мозок та інші пропорції частин скелета, шимпанзе має добре розвинений волосяний покрив
Біохімічний: можливість розрізняти види за біохімічними параметрами (будовою білків і нуклеїнових кислот)
Білок FOXP2 людини, який регулює розвиток мозку, легенів і кишечника та забезпечує розвиток мовних навичок, на 2 амінокислоти відрізняється від аналогічного білка шимпанзе
Критерії виду
У природі трапляються види-двійники, які дуже подібні між собою за зовнішньою
будовою. Такі види було виявлено серед комах, риб, птахів, ссавців, рептилій, амфібій тощо. В Україні види-двійники знайшли у зелених ропух, по-
лівок, мишаків. Тому, щоб не
помилитися, для визначення виду використовують не якусь одну ознаку, а цілий комплекс

Генетичний: кількість і структура хромосом виду, тобто його каріотип
2.
Поміркуйте
• Живі організми • Рослини
• Тварини • Гриби
• Біоценози Згадайте
Рівні й типи біологічного різноманіття
Термін «біорізноманіття» почали застосовувати нещодавно. Поняття «біологічне різноманіття» ввів Томас Лавджой (мал. 10.1) 1980 року, а скорочений варіант — «біорізноманіття» — запропонував Едвард Осборн Вілсон 1986 року.
Зараз застосовують кілька різних варіантів значення терміна «біорізноманіття». Одним із найбільш поширених є такий: біорізноманіття — це сукупність генів, видів та екосистем у регіоні. Визначення, прийняте на саміті ООН у Ріо-де-Жанейро (1992), говорить, що біорізноманіття — це мінливості серед живих організмів з будь-яких ареалів, включаючи, зокрема, суходольні, морські та інші водні, та серед екологічних комплексів, частинами яких вони є, що включає мінли-

рівнями можна розглядати біологічне різноманіття на рівні популяції, виду, екосистеми тощо. Розрізняють три основні типи біорізноманіття: альфа-, бета- та гамма-різноманіття. Альфа-різноманіття оцінює різноманіття всередині угруповання, бета-різноманіття — між угрупованнями, а гамма-різноманіття — на рівні ландшафтної зони, яка містить цілу низку угруповань.
забезпечити обмін речовин. Тобто без мінімального біологічного різноманіття екосистема існувати просто не зможе. Теоретично мінімальною умовою існування екосистеми є наявність хоча б двох компонентів — продуцента


різноманіття
шанси популяції на виживання в умовах зміни середовища існування, бо в такому випадку хоч хтось із нащадків може виявитися достатньо пристосованим до нових умов існування. Велике значення має біорізноманіття
і для людини. Людина також є складовою
екосистем. Тому високий рівень біорізнома-
ніття збільшує шанс виживання екосистем узагалі й людини зокрема. Велика кількість
різних видів тварин і рослин може бути джерелом природних сполук і матеріалів, які мо-
жуть використовуватися людиною.
Крім того, високе різноманіття надає лю-
дині переваги і в її господарській діяльності.
Так, перші цивілізації на планеті зароджува-
лися у схожих умовах. Але євразійські цивілізації мали можливість для одомашнення набагато більшої кількості видів тварин, ніж,
наприклад, американські. Одомашнення коней зробило більш ефективним як сільське господарство, так і транспорт, що стало причиною вищої ефективності економіки і швидшого розвитку цивілізації в Євразії.
Систематика і біогеографія Систематика та біогеографія є науками, які складають основу
характерні ознаки кожного фауністичного царства.
3. Визначте головні принципи фауністичного районування. Дайте
Згадайте
• Біологія
• Методи біології
• Експеримент • Спостереження
• Фактори середовища
Методи вивчення біорізноманіття
Методи вивчення біорізноманіття є досить численними. До них належать інвентаризація, моніторинг, оцінка видового різноманіття, оцінка екосистемного різноманіття, біоіндикація.
Дуже важливим є кількісний аспект оцінювання різноманіття.
Оцінювати біорізноманіття можна як усередині якогось угруповання, так і порівнюючи між собою різні угруповання. Під час оцінювання біорізноманіття всередині угруповання не слід плутати його з багатством
екосистеми. Видове багатство визначається кількістю видів, які присутні в екосистемі. А під час оцінювання біорізноманіття враховується також кількісна частка кожного з видів (мал. 11.1).
Інвентаризація і моніторинг
Будь-яка оцінка біорізноманіття починається з його переліку (інвентаризації).
Інвентаризація — це виявлення наявності всіх компонентів біорізноманіття та їх фіксація. Так, під час аналізу генетичного різноманіття виявляють усі існуючі варіанти генів, а під час аналізу видового різноманіття визначають усі види, які є в угрупованні. Інвентаризація є тією основою,
в екосистемах і запобігати негативним тенденціям, які вдається виявити. Залежно від призначення виділяють загальний (стандартний), оперативний (кризовий) та фоновий (науковий) моніторинг. Фоновий моніторинг здійснюється у природних та біосферних заповідниках і на інших територіях, що охороняються. Він є докладним і високоточним, що дозволяє
ний моніторинг не такий докладний. Параметри, за якими


ватися клітини, організми, популяції окремих видів або екологічні угруповання. За допомогою біоіндикації можна оцінювати дію абіотичних, біотичних та антропогенних факторів. Для діагностики стану екосистем використовують види-індикатори, які мають більшу чутливість до дії несприятливого фактору середовища і тому швидше реагують на зміни в дії цього фактору. Для оцінки дії різних факторів використовують різні види-індикатори (мал. 11.2).
Слід відмітити, що універсальних видівіндикаторів не існує. Це пов’язано з тим, що різні живі організми суттєво відрізняються
між собою за стійкістю до дії різних факторів. І якщо, наприклад, певний вид є чутливим до зміни вмісту сполук Арсену у своєму середовищі існування, то це не означає, що
він також буде гарним індикатором для виявлення зміни вмісту сполук Плюмбуму. Для аналізу змін стану екосистеми в цілому застосовують не один вид-індикатор,
а цілий комплекс таких видів. Для того щоб
оцінка стану екосистеми була ефективною, до комплексу видів-індикаторів включають представників основних екологічних груп — продуцентів, консументів і редуцентів.
Екологічне прогнозування — це передбачення можливої поведінки природних систем на основі інформації, яка була отримана
передніх
Практична робота
таблицю, у якій укажіть, які рослини є
ми, голонасінними та вищими споровими, а також які тварини є хребетними, безхребетними.
3. Для кожного з видів оцініть частоту, з якою він трапляється в екосистемі, (висока, середня, низька), та вкажіть її в таблиці.
4. Сформулюйте висновок.
• Клітина • Прокаріоти
• Еукаріоти • Віруси
• Систематичні категорії Згадайте

Тридоменна система живого світу
Карл Воуз (1990 р.), спираючись на аналіз послідовності нуклеотидів рРНК та деякі інші молекулярні характеристики, за -
пропонував новий варіант систематики живих організмів. Згідно з ним організми поділялися на великі систематичні групи —
домени. Домен — це таксон
Мал. 12.2. Новий варіант системи організмів,
Макросистематика і метагеномний
аналіз
Макросистематикою називають розділ систематики живих організмів, який працює із систематичними категоріями найвищих рангів — доменами, субдоменами, групами царств, царствами тощо. Останнім часом у цій галузі
було зроблено чимало відкриттів. Це пов’язано із застосуванням новітніх методів аналізу, у першу чергу молекулярно-генетичних. Зараз уже відома послідовність нуклеоти-
дів ДНК для багатьох важливих генів сотень організмів. А геноми хоч кількох представників основних систематичних груп розшифро-
вані повністю. Це дозволяє ефективно порівнювати організми між собою, встановлюючи
їхні родинні зв’язки. Завдяки таким техноло-
гіям було поставлено питання про об’єднання
архей та еукаріотів в один домен. Зараз воно активно обговорюється.
Виявилося, що таких організмів набагато
ше, ніж передбачалося раніше. Серед них навіть була виділена окрема група «відділівкандидатів» (Candidate Phyla), яких
існування: у дуже гарячих джерелах (наприклад, у гейзерах)
солоним, кислим або лужним середовищем. Але наступні дослідження
• Клітина
та
двошарова, складається з фосфоліпідів
Клітинна стінка Складається
Мембрана може бути двошаровою або одношаровою, складається з етерів гліцеролу та терпенових сполук



(отримують
нення водню) та термотоги (бактерії, які живуть у гарячих джерелах). До терробактерій належать ціанобактерії та збудник туберкульозу, а до гідробактерій — спірохети, хламідії та збудники чуми, холери і сальмонельозу. Систематика архей також є ще недостатньо розробленою. Але вчені
Використовуються у виробництві харчових продуктів
Є основним виробником продукції в біотехнологічному виробництві
сири, хлібобулочні вироби тощо
які виробляють ліки (наприклад, інсулін)
Є складовою частиною бактеріальних добрив Азотфіксуючі бактерії, які суттєво підвищують урожайність багатьох рослин
Є мутуалістичними симбіонтами кишечнику людини
Є збудниками багатьох захворювань як самих людей, так і важливих для них тварин і рослин
паличка
Збудники холери,
Поміркуйте
Які ознаки вказують на те, що амеба є більш близьким родичем людини, ніж інфузорія?
Згадайте
• Домен • Ядро
• Еукаріоти • Мітохондрії
• Археї • Пластиди
• Моно- та поліфілетичні організми
Еволюційні
Еукаріотичні організми утворилися в процесі еволюції з прокаріотичних. Але про те, яка саме з груп прокаріотів була предком еукаріотичних організмів, дискусії тривали
довго. Перші дані про спорідненість еукаріотів з археями з’явилися ще 1984 року. Але тільки після розвитку технологій молекулярно-біологічних досліджень удалося встановити це більш обґрунтовано.
2015 року група під керівництвом Аньї
Спанг (A. Spang) виявила у Північному Льо-
довитому океані сліди ДНК невідомого раніше організму з домену архей, який був
названий Lokіarchaeum і віднесений до са-
мостійного відділу Локіархеї (Lokіarchaeota), що входить до складу надвідділу Асгардархеї (Asgardarchaea) (мал. 14.1). Ця група архей і виявилася найближчим родичем еукаріотів.
Більш того, вона утворила з ними монофілетичну групу. Саме тому зараз розглядають

можливість змінити тридоменну систему органічного світу на дводоменну, бо, за правилами систематики, монофілетичні групи повинні утворювати один таксон.
Поділ еукаріотів на субдомени Нові технології досліджень, які з’являлися в другій половині XX ст., сприяли виділенню
субдоменами еукаріотів є Екскавати, Діафоретики (біконти) та Аморфеї (мал. 14.2). Екскавати є винятково одноклітинними
а серед діафоретиків та аморфеїв трапляються як одноклітинні, так і багатоклітинні форми.
Екскавати Екскавати є найдавнішою групою еукаріотів. До них належать тільки одноклітинні організми. Вони можуть бути вільноживучими, вести паразитичний спосіб життя або ставати симбіонтами багатоклітинних організмів.
До цієї групи належать збудники захворювань, небезпечних для людини. Це, наприклад, трихомонада (збудник трихомонозу), трипаносома (збудник сонної хвороби) і лейшманія (збудник лейшманіозу).
Також до екскаватів належать евглени, типовим представником яких є евглена зелена, і гіпермастигіни

представлено переважно одноклітинними формами. Але є серед них і колоніальні організми. А справжні слизовики здатні утворювати багатоклітинний плазмодій. Представниками амебозоїв є різноманітні амеби та справжні слизовики.
Опістоконти можуть бути одноклітинними, колоніальними або багатоклітинними організмами. До цієї групи належать царства Справжні гриби та Справжні тварини. Справжніми грибами є представники таких груп, як Базидіоміцети (у тому числі шапинкові гриби), Аскоміцети (трюфель, пеніцил тощо) та інші. Царство Справжні тварини об’єднує
всіх багатоклітинних тварин (вони об’єднані
в окреме підцарство), їх безпосередніх предків (хоанофлагелят) та їх близьких родичів. Діафоретики
Діафоретики є дуже різноманітною за складом групою еукаріотів. До цього субдомену відносять кілька надцарств, найбільш значними з яких є Архепластиди та SAR.
Архепластиди об’єднують фотосинтезуючих
дять до його складу (Stramenopiles, Alveolata, Rhizaria). Серед них є одноклітинні, колоніальні й багатоклітинні організми. Багато представників цього надцарства, як і архепластиди, є фотосинтезуючими еукаріотами. Але їхні хлоропласти утворилися завдяки симбіозу з іншими еукаріотами (частіше за все з представниками червоних або зелених водоростей). Найбільш відомими автотрофними представниками SAR є бурі, діатомові та золотисті водорості. Є серед представників SAR і гетеротрофні групи. До таких
• адаптація до життя на суходолі (хоча є і вторинноводні форми);
• живлення зародка (ембріона) рослиною попереднього покоління (саме ця особливість і дала назву групі);
• наявність специфічної структури, у якій утворюються жіночі гамети,— архегонію; • наявність продихів (можуть бути відсутні у деяких печіночників). У життєвому циклі ембріофітів є
такі:
• багатоклітинність;

Мікрофільні
дослідження довели, що всі ці три групи слід розглядати як
окремі відділи. Ці групи відрізняються від
інших ембріофітів тим, що в їхньому життєвому циклі переважає гаметофіт (життєва стадія, на якій утворюються гамети). А спорофіт (життєва стадія, на якій утворюються спори) розвинений гірше.
Для представників цієї групи характер-
ною є також відсутність коренів і поділу (у частини представників) тіла рослини на
органи.
Судинні рослини До судинних рослин належить більша
частина ембріофітів. Характерною ознакою цієї групи є наявність справжніх тканин і поділ тіла рослини на органи. У найперших наземних рослин тіло
переважає спорофіт. Судинні рослини створили
їхнього тіла на органи (корінь і пагін) та появі у них спеціалізованих механічних і провідних тканин. Корінь забезпечив
мінеральне живлення рослини. Через нього
до організму рослини надходять вода і неор-
ганічні речовини, а пагін забезпечив процеси фотосинтезу і дихання. Механічні тканини
дозволили рослинам протидіяти силі земного тяжіння і рости вгору, а провідні тканини забезпечили зв’язок між їхніми органами.
утворення листків. Листки плаунів є мікрофільними
дять
(більше 9000 видів), хвощі (15 видів) і псилоти (92 види). Розквіт цієї групи, як і у плаунів, припав на кінець палеозойської ери — 350–250 млн років тому. Більшість сучасних представників цієї групи — трав’янисті рослини. Але серед папоротей є і деревовидні форми. Листки у папоротей великі й часто можуть бути сильно розгалуженими. На відміну від інших рослин вони ростуть верхівкою, а
Згадайте
• Насіння • Плід
• Квітка • Суцвіття
Насінні рослини
Насінні рослин є найбільшою за кількістю видів групою рослин. Вони поділяються на дві великі групи — голонасінні та покритонасінні. Голонасінні з’явилися в кінці палеозойської ери, а покритонасінні — в кінці мезозойської. За кількістю видів насінні рослини є найбільшою групою серед усіх автотрофних організмів.
Головна відмінність насінних рослин у тому, що вони можуть розмножуватися без наявності рідкої води. Це стало можливо завдяки тому, що спермії під час запліднення рухаються не в зовнішньому середовищі, а всередині пилкової трубки. Після запліднення насінні рослини утворюють насінини, які містять запас поживних речовин і зародок (мал. 16.1).





Голонасінні У голонасінних насінина розвивається незалежно від того, було запилення чи ні, хоча за відсутності запилення зародок не розвивається. Тому частину ресурсів на розмноження вони витрачають задарма, формуючи насінини
зав’язі збільшує можливість її пошкодження. Це
як у
Серед голонасінних немає трав’янистих рослин. Більша частина з них є деревами або кущами, а деякі види — ліанами. До голонасінних рослин належать такі групи,
вторинноводні форми. Квіткові рослини є основою сучасного сільського господарства. Суттєвою перевагою покритонасінних є поява у них подвійного запліднення, квітки і плоду.
Квітка забезпечує більші можливості для запліднення (наприклад, привертаючи увагу комах, які здійснюють запилення). А плід
захищає насінини від зовнішніх впливів і може забезпечити набагато краще їх поширення. Серед квіткових рослин є всі відомі
життєві форми — дерева, кущі, трав’янисті рослини, ліани.
Ще однією перевагою квіткових рослин
виявилася їх тісна взаємодія з комахами. Утворення мутуалістичних зв’язків, коли комахи переносять пилок між квітками, а рослини забезпечують їх нектаром, дозволило різко підвищити ефективність запліднення. Також вигідним надбанням виявилося утворення плоду. Наявність частин плоду, які могли споживати тварини, стало причиною більш ефективного поширення насіння і сприяла освоєнню квітковими рослинами нових місць існування.
Традиційно квіткові рослини залежно
від кількості сім’ядоль у насінині поділяли на дві групи — однодольні та дводольні (мал. 16.3, 16.4). Представниками однодольних є такі рослини, як пшениця, жито,
кукурудза, конвалії, лілії, часник, пальми. Дводольними є горох, соняшник, троянда, яблуня, буряк, дуб, клен, липа. Дослідження останніх років підтвердили те, що однодольні є монофілетичною групою. А от дводольні виявилися групою парафілетичною і містили кілька неспоріднених таксонів. Тому в сучасній систематиці

але вони мають різне походження. Тому зараз різні групи справжніх грибів і грибоподібних організмів
групи еукаріотів. Широко відомими
дріжджі, трюфель (мал. 17.2). А до базидіальних






Мал. 17.4.
гриби) (мал. 17.3). Відрізняються ці групи
грибів особливостями свого статевого роз-
множення. У сумчастих грибів статеві спори утворюються в так званій сумці, а у базидіальних — на спеціальному утворі — базидії.
Такі особливості біології дали цим групам
грибів їхні сучасні назви. Справжні гриби відіграють велику роль у природних екосистемах. Частина їх є паразитами інших живих організмів (у тому числі й інших грибів). Але значна частина належить до сапротрофів — організмів, які переробляють мертву органіку. Саме вони руйнують рештки мертвих організмів до
простих неорганічних речовин і повертають хімічні елементи до геохімічного кругообігу. Люди широко використовують справжні гриби в їжу. Але особливо велике значення вони мають для біотехнологічних виробництв. Приготування хліба, виробництво ряду кисломолочних продуктів і сирів, створення певних сортів вин — в усіх цих процесах задіяні гриби. І, зрозуміло, виробництво
антибіотиків. За допомогою грибів їх відкри-
Ірландія) (мал. 17.4).
Слизовики
Справжні слизовики, як і гриби, є представниками аморфеїв, але належать до іншого царства, ніж справжні гриби. Інші групи слизовиків відносять до екскаватів (несправжні слизовики, або акразії) та діафоретиків (паразитичні слизовики, або плазмодіафориди). Представники різних груп слизовиків здатні утворювати плазмодії (гігантські рухомі багатоядерні клітини) (мал. 17.5) або псевдоплазмодії (скупчення окремих клітин, які можуть рухатися узгоджено) (мал. 17.6). В екосистемах слизовики відіграють роль мікроконсументів, тобто дрібних хижаків, які регулюють чисельність бактерій, водоростей і найпростіших у грунті та органічних рештках.
Систематичне положення тварин Справжні тварини є представниками аморфеїв. Царство Справжні тварини об’єднує багатоклітинних
За кількістю видів справжні
• Систематика • Субдомен
• Аморфеї • Гетеротрофи
• Ембріогенез Згадайте




Джерело харчування
Сільськогосподарські
й дикі тварини
Завдання шкоди продуктам харчування, спорудам та матеріалам Міль, шашіль, хрущак борошняний, терміти тощо
Джерело промислової сировини Отримання шерсті, шкіри, тканини (шовкопряд), воску (бджоли) і сировини для виробництва багатьох видів косметики (кити)
Завдання шкоди культурним рослинам і свійським тваринам Збудники захворювань рослин (попелиці, короїди тощо) і тварин (плоскі та круглі черви, кліщі тощо)
Різноманітність тварин Тварини є найбільшою за чисельністю видів групою живих організмів. Ця група є
монофілетичною, але порядок розходження окремих таксонів та їхні родинні зв’язки все ще активно вивчаються. Не підлягає сумніву походження багатоклітинних тварин від комірцевих джгутиконосців, а взаємовідносини різних груп усередині таксону показано на
мал. 18.2.
Тривалий час учені поділяли тварин на
безхребетних і хребетних. До хребетних відносили ссавців, птахів, рептилій, амфібій і риб, які мали хребет. Усі інші тварини вважалися безхребетними. Та більш докладні дослідження виявили, що хребетні тварини мають близьких родичів, у яких хребет відсутній (ланцетники, асцидії, сальпи тощо), тому їх об’єднали в одну групу і виділили
в окремий тип Хордові, хоча хребетні залишилися у ньому в ранзі підтипу. А безхребетні виявилися дуже різноманітною гру-
пою, окремі підрозділи якої були споріднені між собою менше, ніж із хордовими. Тому сучасна систематика не розглядає безхребетних як окрему систематичну групу. Серед тварин виділяють кілька найбільш примітивних
• Транспортні засоби та засоби зв’язку
Коні, північні олені, верблюди, воли, собаки, віслюки, голуби • Домашні улюбленці Коти, собаки
Завдання шкоди здоров’ю людини Отруйні тварини, виробники алергенів (пилові кліщі, свійські тварини тощо), збудники захворювань (глисти, воші тощо), переносники захворювань (кліщі, комарі тощо), хижі тварини
й жалкі.
тварини представлені організмами з трьома шарами клітин і, переважно, білатеральною симетрією тіла. Тому їх часто називають двобічносиметричними тваринами. Хоча деякі їхні групи і демонструють
тощо), але така будова є новим надбанням, і походять вони від двобічносиметричних предків. Залежно від того, що саме утворюється під час ембріогенезу на місці бластопору (отвору на поверхні гаструли), їх поділяють на первинноротих (якщо утворюється ротовий отвір) та вторинноротих (якщо утворюється анальний отвір).
До первинноротих відносять круглих і кільчастих червів, молюсків, членистоногих, тихоходів, мохуваток, плечоногих (брахіоподів) та інші групи. Представниками вторинноротих є хордові, голкошкірі, напівхордові та щетинкощелепні.
Поміркуйте
Згадайте
• Тварини • Вториннороті
• Онтогенез • Хорда • Хребет
Хордові та їх різноманіття
Хордові є однією з найуспішніших груп тварин. Її представники опанували всі середовища існування (водне, наземне, підземне, повітряне). Ця група тварин є монофілетичною, що було підтверджено за допомогою молекулярно-біологічних досліджень. Найближчими родичами хребетних є голкошкірі (морські зірки, морські їжаки, голотурії, офіури тощо).
Всі представники хордових мають певні риси будови, які є характерними для
групи (мал. 19.1).


стадій онтогенезу, є:
• наявність хорди;
• трубчаста нервова система;
• розташування нервової трубки безпосередньо над хордою;
• вторинна порожнина тіла;
• травна система з ротом і анальним отвором;
• наявність зябрових щілин;
• сегментована мускулатура;
• наявність хвоста з м’язами.
Тип Хордові поділяється на три підтипи: Хребетні (риби, птахи тощо), Головохордові (ланцетники) та Покривники (асцидії, сальпи тощо). Найбільш розвиненою й поширеною
місці хорди розвивається хребет, що може складатися з хрящової або
анамній та амніот.
Анамнії Анамнії — це хордові тварини, у яких у процесі ембріонального розвитку не утворюються зародкові оболонки (амніон, хоріон та алантоїс). До анамній відносять усі первинноводні групи хордових: безщелепних, риб і амфібій (мал. 19.2).
Більша частина анамній постійно живе у воді. Лише певні представники земновод-



Черепаха

Качка
Мал. 19.3. Представники амніот
Запліднення у більшості анамній зовнішнє. Розвиток зародка відбувається в яйці, яке вкрите слизовою оболонкою. Вода надходить до зародка через поверхню яйця. Тому розмноження можливе тільки у водному середовищі. У деяких представників анамній способи розмноження були суттєво вдосконалені.
Так, еволюційний успіх хрящових риб багато
в чому пов’язаний саме з цим. Ця група першою серед хребетних перейшла до внутрішнього запліднення. Яйця, які відкладають
хрящові риби, великі, мають значний запас жовтка і достатньо щільну оболонку. У частини видів спостерігається яйцеживородіння, коли зародок розвивається тільки за рахунок речовин яйця, але саме яйце міститься в організмі матері. А для окремих видів (акула-молот, електричний скат) зафіксовано справжнє живородіння, коли потрібні речовини надходять до зародка прямо з організму матері.
Амніоти
Амніоти — це хордові тварини, у яких у процесі ембріонального розвитку утворюються зародкові оболонки (амніон, хоріон та алантоїс). Амніоти є первинноназемними організмами. Ця група виникла в умовах суходолу, і всі її представники, які перейшли

Гелада
до життя у воді, є вторинноводними організмами. Ця група включає рептилій, птахів і ссавців (мал. 19.3).
тих амніот, яйця яких розвиваються у зовнішньому середовищі, зовнішні покриви яєць щільні й не пропускають воду. Всі потрібні зародку речовини розміщені всередині яйця, і ззовні крізь пори надходить тільки кисень. Така будова робить можливим розвиток зародків у наземному середовищі. Розвиток яєць у зовнішньому середовищі може відбуватися без участі батьків. Прикладом цього може бути розмноження морських черепах, які просто заривають яйця в теплий пісок на березі. Батьки можуть захищати яйця і певним чином регулювати температуру їхнього розвитку, регулюючи товщину шару ґрунту, який їх вкриває.
Різноманіття екосистем Біорізноманіття притаманне всім рівням організації живого. Крім видового різноманіття, дуже важливим є екосистемне різноманіття. Формування цього різноманіття є складним процесом.
• Екосистема • Біосфера • Біорізноманіття • Еволюція Згадайте
Палеотропічне
Неотро-
пічне
Вся територія Африки за винятком регіону, прилеглого до Середземного моря та невеликої області на
півдні континенту, більша частина Аравії, Індостан, південь Китаю й острови
Більша частина Південної
Соснові, Букові, Березові, Розові, Капустяні, Осокові тощо
Родини Пальми, Тутові, Молочайні, Пасльонові, Бананові, Миртові, Ароїдні тощо
неї острови Родини Евкаліптові, Араукарієві, Подокарпові
і в різних природних зонах. Космополітами стають види, які є жителями біотопів, що не сильно відрізняються між со-
бою незалежно від місця проживання. Класичними видами-космополітами є, наприклад, щитні. Ці ракоподібні мешкають у калюжах. Термін їх розвитку дуже корот-
кий, а температурні умови, в яких можуть існувати калюжі, мають достатньо вузькі рамки, тобто калюжі в Америці та Євразії відрізняються не дуже сильно. А яйця щитнів стійкі до зовнішніх впливів і дуже легкі, тому
вітром легко переносяться на сотні кілометрів. Ще одна гарна екологічна ніша для видів-космополітів — синантропна. Синантроп-
ні види пристосовуються до життя поряд
з людиною. А людина створює схожі умови
для існування, перебудовуючи навколишнє середовище під свої звичні потреби. Такими синантропними видами-космополітами стали
всі свійські тварини, для яких людина спеці-
ально створює підходящі умови проживання.
Але багато видів поширилися разом з людиною без її згоди (таргани, пацюки тощо).
Ендеміки
Ендеміки — це види, які мають дуже обмежений ареал (наприклад, щілинозуб на Кубі, фоса на Мадагаскарі, ківі у Новій Зеландії). Зазвичай це види з вузькою спеціа-
лізацією й унікальною екологічною нішею. Найбільша кількість ендеміків зосереджена у відносно ізольованих екосистемах. Це острови (особливо ті, які розташовані далеко від найближчої суші), озера, печери тощо. Велика кількість ендеміків є на Гавайських та Галапагоських островах. Так, ендеміками Галапагосів є гігантська галапагось-
ка черепаха, галапагоська сухопутна ігуана, 13 видів галапагоських в’юрків тощо. В озері Байкал нараховують
таргана (Blatta orientalis), чисельність якого з того часу різко зменшилася.
Порівняльна характеристика флористичних областей даної місцевості
1. Виберіть три флористичні області Євразії (наприклад, Ірано-Туранську, Східно-Азіатську, Середземноморську).
2. Складіть порівняльну таблицю
Згадайте
• Біорізноманіття • Ареал
• Конкуренція • Екологічна ніша
Інтродукції та їхні причини й наслідки
Інтродукція — це цілеспрямоване переселення людиною одного з видів живих організмів за межі його ареалу в нові умови існування. Вид, який потрапив в екосистему шляхом інтродукції, називають інтродукова-
ним, або чужорідним видом. Процес адаптації інтродукованого виду до нових умов існування називають акліматизацією. Найчастіше причиною інтродукції є потреба в певній продукції, джерелом якої є
живі організми. Це продукти харчування, сировина для виробництва одягу, будівельні
матеріали тощо. Часто інтродукція проводиться з естетичних потреб (наприклад, для створення парків з екзотичними для певної
місцевості рослинами). У деяких випадках інтродукція може вирішувати транспортні проблеми (коні, верблюди, віслюки, собаки). Інтродукція нових видів людиною може мати різні наслідки. У деяких випадках інтродуковані види не здатні вижити без підтримки людини. Тоді вони залишаються в новому регіоні
у кіз не було природних ворогів, і вони починали безконтрольно розмножуватися, знищуючи місцеву рослинність і викликаючи екологічну катастрофу. Так, дуже сильно постраждали від таких дій Галапагоські острови.
Прикладами інтродукованих видів для України є кукурудза, пшениця, біла акація, клен ясенелистий, дуб червоний, кавун, товстолоб, білий амур, кішка, коза, шовковичний шовкопряд.
екосистеми. У такому випадку вони теж стають інвазійними.
випадкові інвазії
часто
зводили до катастрофічних наслідків. І не тільки для місцевих екосистем, але й для самої людини. Характерними прикладами є
потрапляння непарного шовкопряда в Північну Америку, а колорадського жука і виноградної філоксери — в Європу. В Україну шляхом випадкової інвазії
потрапило багато видів. Так, суттєвої шко-
ди екосистемі Чорного моря завдав молюск рапана, якого в кінці 40-х років ХХ століття випадково завезли з Далекого Сходу. Він
фактично знищив великі колонії двостулко-
вих молюсків (особливо постраждали устриці), що різко погіршило фільтрацію морської води. Катастрофічною була і поява в Чорному морі реброплава мнеміопсиса 1982 року.
Цей вид потрапив у Чорне море з баластними водами кораблів від узбережжя Флориди
що підірвало кормову базу багатьох промислових риб
не
мають катастрофічний характер. Австралійський гриб квітохвістник Арчера був випадково завезений у Європу в першій половині ХХ століття. Він
цілком нормально ввійшов до складу лісових біоценозів і поширився територією Європи,
досягнувши й України.
Біорізноманіття як ресурс і основа
збереження життя на Землі
Біорізноманіття є одним із основних ресурсів нашої планети, який забезпечує її існування. Різноманіття
інтродукція. Реінтродукція
Практична робота
3.
Критерії
Екологофізіологічні Тип живлення, місце в екосистемі
Цитологобіохімічні Будова та хімічний склад клітини
Молекулярнофілогенетичні
Спорідненість,
грип,
віспа, гепатит, ебола, кір, краснуха, вірусний паротит, ящур
(1758), Мюнхгаузен (1763), Неккер (1783), Геккель (1866), Копленд (1938), Уайттейкер (1965), Маргуліс (1971), «Шкільна» чотирицарствова класифікація 1980–1990-х рр.
Сучасні системи: Едл та ін. (2012), Буркі (2016), Браун та ін. (2018)
Веретеноподібність бульб картоплі, карликовість хризантем та томатів
Куру, скрепі, хвороба Крейтцфельдта — Якоба, фатальне родинне безсоння
Прокаріотичні організми Бактерії Археї
Ознаки:
• Одноклітинні, колоніальні або
• Клітинна стінка з муреїну • Мембрана завжди двошарова
• Геном не містить гістонів Ознаки:
ціанобактерії, протеобактерії, грампозитивні бактерії, актиноміцети, ріккетсії, хламідії, спірохети, планктоміцети
S-білків тощо
Екскавати
Ознаки:
• одноклітинні
• джгутиків переважно 4, 6, 8; зрідка 1-2 передні
• мітохондрії часто редуковані, або з дископодібними кристами
• статевий процес відсутній
• гетеротрофні (за винятком деяких евглен)
Представники: евглени, трихомонади, трипаносоми, лямблії, акразієві слизовики
Ознаки:
• одноклітинні, колоніальні або багатоклітинні
• джгутиків переважно 2, передні або бічні
• мітохондрії
пластинчастими кристами
• автотрофні та гетеротрофні
Представники: бурі, діатомові, червоні, зелені водорості, вищі рослини, несправжні гриби, інфузорії, споровики-апікомплекси, радіолярії, форамініфери, сонцевики

Ознаки:
• одноклітинні, колоніальні або багатоклітинні
• джгутик переважно 1, задній
• мітохондрії з трубчастими або пластинчастими кристами
• гетеротрофні
Представники: типові амеби, справжні слизовики, справжні гриби, комірчасті джгутиконосці, багатоклітинні тварини, у т. ч. людина



Поміркуйте
Нестача елементів в організмі рослин, яких міститься зазвичай відносно багато (C, O, H, N), погано позначається на їхньому стані. Чи позначиться на їхньому стані нестача тих елементів, яких в організмі рослини набагато менше, наприклад S або K?
Згадайте
• Органічні й неорганічні речовини в клітині
• Мономери, полімери, біополімери
Органічні речовини клітин живих
організмів
Головними компонентами живих організмів є органічні речовини. З них будуються
всі клітини, структура й склад яких сильно
відрізняються від тіл неживої природи. Саме органічні речовини забезпечують виконання тих специфічних функцій, що визначають загальні властивості живого (сталість складу, самовідтворення, спадковість, мінливість тощо).
Як ви вже знаєте, органічні сполуки складаються переважно з біогенних хімічних елементів — C, H, O, N, які становлять
до 98 % сухої маси живої клітини. Великі
органічні молекули (з масою понад 1000 Да), які входять до складу живих організмів, називають макромолекулами, або біополімера-
ми. Вони складаються з мономерів.
Органічні речовини, що містяться в живих організмах, поділяють на чотири основні групи: білки, вуглеводи, ліпіди й нуклеїнові кислоти.
Білки є біополімерами, молекули яких складаються з великої кількості
функції: каталітичну (ферменти), структурну (колаген, еластин), захисну (імуноглобуліни) тощо.

Вуглеводи беруть участь у процесах обміну речовин (глюкоза, фруктоза) і зберіганні спадкової інформації (рибоза, дезоксирибоза), виконують структурну (целюлоза, хітин) і запасаючу (крохмаль, глікоген) функції. До складу молекул вуглеводів входять кілька функціональних груп: гідроксильна (–OH), карбоксильна (–COOH) або карбонільна (–COH). Загальна формула
тивостями. Вони всі є нерозчинними у
маслянистими або жирними речовинами. Найбільш поширеними ліпідами є жири, олії, фосфоліпіди, воски та стероїди. Основними функціями ліпідів у живих організмах є структурна (фосфоліпіди, гліколіпіди), резервна й енергетична (жири, олії), регуляторна (стероїдні гормони, жиророзчинні вітаміни), захисна і терморегуляторна (воски, жири). Нуклеїнові кислоти (ДНК, РНК) є великими біополімерами, мономерами яких є нуклеотиди. Функція нуклеїнових кислот — збереження й відтворення генетичної інформації. Неорганічні речовини клітин живих організмів
Функціонування клітин живих організмів було б неможливим без участі



фотосинтезу,
терморегуляції (потовиділення, гутація), забезпечує транспірацію, бере участь у транспорті речовин
Катіони Гідрогену (H+) Забезпечують кислотно-лужний баланс
Бікарбонати і фосфати Натрію і Калію Утворюють буферну систему тканин і крові, підтримуючи їхній pH на постійному рівні
Катіони та аніони розчинних солей (Na+, K+, Cl–)
Створюють різницю потенціалів між умістом клітини й навколишнім середовищем, забезпечуючи роботу транспортних білків мембран та проведення нервового імпульсу
Слабкорозчинні солі Кальцію і Фосфору Містяться у складі
безпечують їхню міцність Йони металічних
Фосфор
розміру; нижні листки скручуються; урожай не дозріває
Листки тонкі; їхні верхівки і краї «вигоряють»; нижні листки скручуються, з плямами; урожайність знижується
Сульфур Скорочуються терміни розвитку рослини; кінчики і краї листків знебарвлюються
Калій Нові листки тонкі; верхівки і краї листків
нижні листки скручуються, на них утворюються
Сповільнений ріст; листки жовтіють, маленького розміру; нижні листки скручуються й опадають; урожай знижується
Ріст уповільнюється; листки синювато-зелені; на нижніх листках темні плями; нижні листки скручуються й опадають
Розвиток листків уповільнюється; кінчики листків темніють
продукту. Її вимірюють у кілокалоріях або в кілоджоулях (1 ккал = 4,1868 кДж). Енергетична цінність добового раціону харчування має відповідати енергетичним витратам організму. За добу на різні види діяльності людина витрачає від 2000 до 4500 ккал. Добова норма
• Білки • Жири
• Вуглеводи • Амінокислоти
Здорове харчування
Речовини та енергію ми отримуємо з їжі.
Для нашої життєдіяльності нам необхідні
білки, вуглеводи, ліпіди, а також вода, невеликі кількості мікроелементів і вітамінів.
Збалансоване харчування — це харчування, за якого в організм з харчовими продуктами надходять усі поживні речовини в кількості, необхідній для нормальної життєдіяльності.
Харчовий раціон — це набір продуктів, який людина споживає протягом певного часу. Правильно підібраний харчовий раціон є основою раціонального харчування.
Харчова та енергетична цінність продуктів харчування Енергетична цінність, або калорійність, продукту харчування — це кількість енергії, яку одержує організм від споживання цього
залежить від того, які компоненти і в яких співвідношеннях містяться у складі харчового продукту. Розроблені орієнтовні норми споживання різних компонентів їжі. Якщо дотримуватися цих норм, раціон буде збалансованим (мал. 23.1). Оптимально добовий раціон дорослої людини має містити:
• 80–120 г білків (25–35 %);
• 60–150 г жирів (15–20 %); • 450–550 г вуглеводів (50–60 %).
Біологічна цінність продуктів харчування
Крім загальної кількості білків, жирів і вуглеводів, важливим також є їхній склад. Тільки з їжею ми отримуємо незамінні речовини, які необхідні для нормальної життєдіяльності, але не синтезуються нашим організмом.
Незамінними для людини є вітаміни, деякі
амінокислоти та ненасичені жирні кислоти. До
незамінних амінокислот належать ізолейцин, лізин, лейцин, метіонін, феніл-
аланін, треонін, триптофан, валін (також
гістидин і аргінін для дітей). Білки їжі, що містять необхідний набір амінокислот, називають повноцінними. До них належать пере-
важно тваринні білки. Найбільш високу біо-
логічну цінність мають білки, що містяться
в яйцях, м’ясі, молоці, рибі.
Зростаючий організм дитини потребує
додаткової кількості білків, які забезпечують ріст і формування тіла. Особливо важливим є надходження всіх незамінних амінокислот. Їхня відсутність у їжі призводить до затримки росту, виснаження і нервових розладів.
Вітаміни потрібні організму в
неможлива.
Порушення обміну мінеральних речовин Мінеральні речовини також не синтезуються в організмі людини і є одними з основ-
них незамінних компонентів харчування.
Їхня нестача або надлишок викликає порушення, що призводять до захворювань.
Причинами порушення обміну мінеральних речовин можуть бути:
• недостатнє або надмірне надходження мінеральних речовин в організм;
• деякі захворювання (гормональні, спадкові тощо);
•
•
ви вже знаєте, спожиті
їжею речовини зазнають у
складних хімічних перетворень. У процесі травлення високомолекулярні сполуки їжі розщеплюються відповідними
Практична робота
3.
4.
•
забезпечують його речовинами та енергією, необхідними для життєдіяльності.
Матеріалом для обмінних процесів є субстрати метаболізму — сполуки, що надходять
з їжею. Серед них виділяють основні харчові речовини (білки, вуглеводи, ліпіди) і мінорні харчові речовини — ті, що надходять у малих кількостях (вітаміни, мінеральні речовини).
В обміні речовин виділяють два етапи:
I — підготовчий (хімічні перетворення речовин у травній системі);
II — власне метаболізм (хімічні перетворення сполук усередині клітин).
Усі процеси клітинного метаболізму можна умовно розділити на дві фази:
• катаболізм (дисиміляція, енергетичний обмін) — процес розкладу складних речовин на простіші; при цьому вивільняється енергія;
• анаболізм (асиміляція, пластичний обмін) — синтез складних сполук із більш простих; при цьому енергія витрачається.
Катаболічні та анаболічні процеси в клітині тісно взаємопов’язані. Енергія, що вивільняється в ході катаболічних процесів, витрачається на утворення макромолекул у процесі анаболізму. Основним акумулятором і переносником енергії є аденозинтрифосфатна кислота (АТФ). У свою чергу,
і парасимпатичною). Гуморальну регуляцію здійснюють ендокринні залози (залози внутрішньої секреції), які є виробниками гормонів. Гормони (інсулін, адреналін, тироксин) переносяться різними рідинами організму (кров, лімфа, тканинна рідина) і керують діяльністю ферментних систем у клітинах.
Нервова й гуморальна системи тісно взаємодіють одна з одною (мал. 24.1). Особливе значення в регуляції обміну речовин має відділ
проміжного мозку — гіпоталамус. Гіпоталамус регулює діяльність найважливішої залози внутрішньої секреції — гіпофіза, який контролює роботу всіх інших залоз внутрішньої секреції.
Деякі фактори, що впливають
на метаболізм у людини
Існує ряд факторів, що впливають на швидкість метаболізму.
Спадковість. Унаслідок спадково зумов-
лених чинників швидкість обмінних процесів у різних людей може відрізнятися на 10 %.
Статура. Чим більше і важче тіло, тим
більше витрачається енергії для підтримки життєдіяльності. М’язовій масі потрібно більше калорій, ніж жировій тканині.
Стать. У чоловіків обмін речовин від-
бувається швидше, ніж у жінок. Це зумовлено більшими розмірами тіла та більшою м’язовою масою.
Спосіб життя. У разі пасивного способу
життя відбувається уповільнення процесів метаболізму, і, навпаки, під час значного фізичного навантаження обмін речовин прискорюється. Стреси, депресії, недосипання й голодування призводять до уповільнення обміну речовин. Харчування невеликими порціями 4–5 разів на день, білкова їжа прискорюють метаболізм.
Обмін речовин в автотрофних і гетеротрофних організмів
За способом одержання органічних речовин (сполук Карбону) живі організми поділяють на автотрофів і гетеротрофів.
тварини,
на фототрофів і хемотрофів. Фототрофи використовують
хімічних реакцій, що відбуваються в їхніх організмах. До хемотрофів належать тварини, гриби, бактерії. Усі зелені рослини є фотоавтотрофами — вони синтезують органічні речовини з неорганічних у процесі фотосинтезу, використовуючи енергію Сонця. Усі тварини й гриби є хемогетеротрофами — вони живляться готовими органічними речовинами і використовують для своєї життєдіяльності енергію хімічних реакцій. Невелика
дієнта концентрації,
• Будова клітинних мембран • Ендоцитоз
• Мембранні білки Згадайте
Активний і пасивний транспорт речовин
Клітина постійно розщеплює і синтезує
хімічних речовин. Одні речовини пере-
міщуються в клітині між органелами, інші виводяться крізь мембрану назовні, тоді як деякі проникають усередину.
Клітинна мембрана пропускає одні речо-
вини і не пропускає інші. Ця найважливіша
властивість біологічної мембрани називається вибірковою проникністю. Вона має велике значення для саморегуляції і підтримки сталого складу клітини.
Транспортування речовин крізь клітинну
мембрану здійснюється за допомогою різних механізмів (мал. 25.1).
Пасивний транспорт — це рух речовин крізь клітинну мембрану без витрат енергії за
градієнтом концентрації (від ділянки з високою до ділянки з низькою концентрацією). Пасивний транспорт здійснюється шляхом простої

шляхом екзо- або ендоцитозу, а також шляхом
називають полегшеною
.
дифузія відбувається через спеціальні канали, розташовані всередині великих білкових молекул. Так транспортуються невеликі органічні молекули (глюкоза, деякі амінокислоти, моносахариди тощо).
Транспортування молекул води крізь мембрани здійснюють спеціальні мембранні білки аквапорини.
Білки-транспортери (активний транспорт)
Одним із видів активного транспорту речовин крізь клітинну

євий йонний насос (йонні насоси — це транспортери йонів). Уніпорт здійснює транспорт тільки однієї речовини.
Робота натрій-калієвого насоса
У цитоплазмі та позаклітинному середо-
вищі підтримується певне співвідношення
йонів Na+ і K+ (вміст K+ більше у клітині, а Na+ — поза клітиною). Викачування
йонів Na+ із клітини і перенесення йонів K+
у клітину здійснюється мембранним білком.
Для цього процесу використовується енергія АТФ (мал. 25.2).
За один цикл роботи насос викачує з клітини три йони Na+ і закачує два йони K+.
Тому на зовнішньому боці мембрани накопичується надлишок позитивних йонів. Цю різницю потенціалів між зовнішньою і внутріш-
ньою поверхнями мембрани використовують
як джерело енергії багато інших білкових
комплексів для перенесення різних речовин крізь мембрану.
Ендоцитоз і екзоцитоз (активний транспорт)
Перенесення великих молекул (білків, полісахаридів, нуклеїнових кислот) і час-
Вантаж
«Хвости»
Кінезин
«Стебло»
«Голівка»

тинок (фрагменти клітин) через клітинну мембрану відбувається з утворенням
мікротрубочки, що є складовими цитоскелета. Транспортування на поверхні мікротрубочок здійснюють моторні білки: динеїни і кінезини (мал. 25.3). Динеїни
Згадайте
• Будова кореня • Кореневі волоски
• Жилкування
Рух речовин у вищих рослин
Як вам відомо, рослини поглинають із
навколишнього середовища воду й розчинені
в ній неорганічні (мінеральні) речовини.
Поглинання вищими рослинами мінера-
лів з ґрунту здійснюється особливою зоною
кореня — зоною всмоктування, де покривні
клітини мають вирости — кореневі волоски.
Крізь мембрани кореневих волосків проникає
вода і розчинені в ній солі.
Від покривних клітин кореневих волос-
ків водний розчин далі пересувається паренхимною тканиною до центру кореня.
Тут розміщено елементи провідної системи рослин (ксилема й флоема). Ними водний розчин мінералів піднімається вгору до стебла й листків, а синтезовані рослиною органічні речовини розподіляються між усіма частинами організму.
Поглинання води кореневими волосками. Осмос і тургор
Надходження розчинених речовин крізь мембрани клітин кореневих волосків здійснюється шляхом дифузії й активного транспорту.
Вода надходить у рослину в основному завдяки
тиском — тиском, який потрібно докласти, щоб запобігти осмотичному надходженню води в розчин. У наземних рослин поглинання води з грунту шляхом осмосу здійснюється
клітинні мембрани кореневих волосків та інших


Мал. 26.2. Роль осмотичного й тургорного тиску в пружності тканин рослин: а — зростання тургорного тиску спричинює відкриття замикаючих клітин продихів, а втрата тургору — їх закривання; б — коли води у вазі не залишається, осмос
Апопластичний та симпластичний
шляхи транспорту води й мінеральних речовин
Вода з розчиненими мінеральними речовинами, що потрапили з ґрунту в корінь, рухається до його центру, а точніше — до судин ксилеми. Це переміщення називають
радіальним (або близьким) транспортом води в корені. Швидкість руху води в корені дуже незначна — близько 1 мм/год.
Радіальний (близький) транспорт води в корені здійснюється кількома способами (мал. 26.3).
• Симпластичний шлях: речовини транспортуються з цитоплазми однієї клітини в цитоплазму іншої крізь плазмодесми —
цитоплазматичні містки. Цитоплазма всіх клітин, з’єднана плазмодесмами, називається симпластом. Симпласт слугує для транспортування мінеральних і органічних речовин.

• Апопластичний шлях: речовини транспортуються по апопласту — взаємозв’язаній системі клітинних стінок і міжклітинних просторів. Апопласт необхідний для транспортування води й мінеральних сполук.
вакуолей.
Переміщення води в листку
Вода з клітин паренхіми кореня надходить у судини ксилеми. По ксилемі мінеральні речовини поширюються по всій рослині. Основними споживачами цих речовин є частини рослини, що ростуть. Потрапляючи
й мінеральні речовини розподіляються через розгалужену мережу провідних пучків по клітинах. Завдяки рясному розгалуженню
Згадайте
• Будова стебла • Провідні пучки
• Ксилема • Флоема
• Транспірація
Провідні тканини рослин
Транспортування речовин у вертикальному напрямку у вищих рослин здійснюють про-
відні тканини — ксилема (деревина) і флоема (луб). По ксилемі проходить висхідний (від кореня до пагонів) рух води з розчиненими в ній мінеральними солями. Речовини, що утворюються в результаті фотосинтезу, переміщуються по флоемі від листків до інших частин рослини (стебла, кореня, квітки). Ксилема й флоема розташовані поряд і утворюють про-
відні пучки (мал. 27.1).
Будова ксилеми
Ксилема складається з власне провідних елементів, а також клітин основної (паренхіма) та механічної (волокна деревини) тканин. Провідні елементи ксилеми представлені трахеїдами і судинами. Обидва типи провідних елементів є витягнутими клітинами зі здерев’янілими оболонками. Ці клітини є

мертвими і не містять протопластів, що значно полегшує транспорт речовин. Трахеїди — це дуже довгі, розташовані у ряд клітини, у стінках яких є пори. Пересування води з клітини в клітину здійснюється крізь ці пори.
Клітинна
супутниця

Ситоподібна
Клітиначленик
пластинка Тонкий шар цитоплазми (ядро відсутнє)
Ситоподібна
пластинка
Мал. 27.2. Будова ситоподібної трубки
Ситоподібні клітини, на відміну від трахеїд ксилеми, є живими. Вони мають видовжену форму і пронизані наскрізними отворами, крізь які транспортуються речовини.
Ситоподібні трубки складаються з безлічі клітин-члеників. Наскрізні отвори двох сусідніх клітин утворюють ситоподібні пластинки, крізь які переміщуються розчини. Ці клітини живі, але в них немає ядер. Поруч з клітинами-члениками розташовані клітини-супутниці, які мають ядра і цитоплазму з органелами. Клітини-супутниці підтримують обмін речовин у клітинах-члениках ситоподібних трубок.
Переміщення речовин по флоемі
На відміну від ксилеми, органічні речовини можуть транспортуватися по флоемі й угору, і вниз. Майже 90 % усіх речовин, що переносяться, становить сахароза. Швидкість руху сахарози становить 20–100 см/год; за день по стовбуру великого дерева може
переміститися кілька кілограмів цього вуглеводу.
Практична робота
висновок.
• Функції кровоносної системи
• Типи і будова кровоносних судин
Метаболічні процеси, що перебігають у клітинах тіла тварин, вимагають безперервного припливу поживних речовин і кисню, а також видалення продуктів обміну. Всі організми тим чи іншим шляхом здійснюють пере-
несення речовин з однієї частини тіла в іншу. В одноклітинних організмів перенесення речовин відбувається шляхом дифузії молекул, переміщенням яких сприяє рух цито-
плазми. У великих тварин існує спеціальна система внутрішнього транспорту.
Найпростіші із сучасних тварин, у яких є спеціальна транспортна система,— це немертини. У них є одна спинна і дві бічні кровоносні судини, з’єднані поперечними судинами. У більших і складно організованих тварин система кровообігу складається зазвичай із кровоносних судин і серця.
Транспорт речовин у кишковопорожнинних, губок, плоских і круглих червів
губки, плоскі чер-
туються тканинною рідиною між
мезодерми. Дифузія полегшується сплощеною формою тіла і численними розгалуженнями кишечника. У круглих червів речовини переносяться рідиною первинної порожнини тіла.
Кровоносна система У більшості тварин для транспортування поживних речовин по організму тільки дифузії недостатньо. Це зумовлює виникнення кровоносної системи. Основними компонентами кровоносної системи є:
• рідина, яка циркулює (кров, лімфа, гемолімфа);
• судини, якими циркулює рідина (артерії, вени, капіляри);
• пульсуючий орган, що забезпечує рух рідини (серце, кровоносна судина).
Гемолімфа — рідка тканина, що циркулює в судинах і міжклітинних порожнинах багатьох безхребетних тварин (членистоногі, молюски) з незамкненою системою кровообігу. Складається з води, неорганічних і органічних сполук. Кров — рідка сполучна тканина, що складається з плазми і клітин (формених елементів) — лейкоцитів, еритроцитів
кровоносних судин.
У незамкненій кровоносній системі
го дихання до легеневого: у земноводних з’являється друге коло кровообігу (мале, або легеневе) і, як наслідок, ускладнюється будова серця (формуються два передсердя) (мал. 28.1). Далі еволюція йде шляхом збільшення вмісту кисню в крові, що надходить до органів: у плазунів виникає неповна перегородка в шлуночку, а у птахів і ссавців формується чотирикамерне серце. У птахів і ссавців до органів надходить тільки артеріальна кров; завдяки кращому забезпеченню киснем у тканинах підтримується високий рівень обміну речовин, що зумовлює теплокровність.
Спинна кровоносна судина

Несправжні серця Черевна кровоносна судина
(передсердя і шлуночок).
У серці — венозна кров
Амфібії Два кола кровообігу. Трикамерне
серце (два передсердя і шлуночок).
Кров у шлуночку серця змішана
Рептилії Два кола кровообігу. Серце трика-
мерне з неповною перегородкою
в шлуночку. Кров у шлуночку
не повністю Птахи і ссавці
Два кола кровообігу. Серце чотирикамерне. Артеріальна та венозна кров не змішуються



Згадайте
• Склад крові • Функції крові
• Плазма крові
Транспортна функція крові
Кров транспортує поживні речовини — білки, жири, вуглеводи, вітаміни, а також йони мікро- і макроелементів від травної системи до всіх клітин тіла.
З транспортом пов’язана екскреторна функція крові — виділення з організму кінцевих продуктів обміну речовин (сечовини, сечової кислоти тощо) або надлишкових речовин (солей, води).
Завдяки транспорту здійснюється й дихальна функція крові: від органів дихання до тканин та інших органів тіла кров транспортує кисень, а назад забирає вуглекислий газ.
Кров переносить також гормони, за допомогою яких здійснюється гуморальна регуляція роботи організму. Завдяки регуляторній функції крові підтримується сталість внутрішнього середовища організму, регулюються водний і сольовий баланс тканин, температура тіла, контролюються обмінні процеси і фізіологічні функції.
Також кров переносить імуноглобуліни — білки-антитіла імунної системи. Транспортна функція крові здійснюється як плазмою, так і форменими елементами (клітинами) крові.
До органічних речовин плазми крові належать:
• білки плазми (альбуміни, глобуліни, фібриноген) — 7,8 %;
• глюкоза — 0,12 %;
• ліпіди — 0,8–1 %;
• нітрогеновмісні сполуки, що екскретуються (сечовина, сечова кислота тощо) — 0,05 %;
• біологічно активні речовини (ферменти, гормони, вітаміни).
До неорганічних речовин плазми крові належать:
• катіони (Nа+, Ca2+, K+, Мg2+) та аніони (Cl–, HPO 2–4, HCO–3) — 0,9 %;
• гази (кисень, вуглекислий газ).
Транспортні білки плазми крові У плазмі міститься кілька сотень білків, частина з яких здійснює транспорт речовин. Основними транспортними білками крові є альбумін, α-глобуліни і β-глобуліни. Вони переносять сполуки, що погано розчиняються у воді,— жирні кислоти, гідрофобні гормони, жиророзчинні вітаміни, а також йони та інші речовини.
Близько 55 % від усіх білків, що містяться в плазмі крові людини, становить сироватковий альбумін. Він є неспецифічним транспортним білком і може зв’язуватися із широким колом речовин: металами, йонами, жирними кислотами, амінокислотами, ферментами тощо.
На відміну від альбуміну, деякі транспортні білки крові є вузько специфічними. Зокрема, церулоплазмін спеціалізований для переносу йонів Купруму, трансферин — йонів Феруму.
Спеціальні
Альбумін
Транстиретин
Альбуміни
Жирні кислоти, білірубін, гем, солі жовчних
кислот, стероїдні гормони (тироксин, кортизол, тестостерон), вітаміни, деякі ліки (аспірин, сульфаніламіди), йони Ca2+ і Мg2+
Тироксин, ретинол (вітамін A)
α-Глобуліни
Церулоплазмін Йони Купруму Сu2+
Ретинол-зв’язуючий білок
Вітамін D-зв’язуючий білок
Тироксин-зв’язуючий глобулін
Ретинол (вітамін A)
Кальциферол (вітамін D)
Тироксин, трийодтиронін
Транскортин Кортизол, кортикостерон, прогестерон
β-Глобуліни
Трансферин Йони Феруму Fe2+, Fe3+
Транскобаламін
Глобулін-зв’язуючий білок


Ціанкобаламін (вітамін B12)
Тестостерон, естрадіол
Транспорт ліпідів Жири не розчиняються у воді й тому не
можуть бути перенесені кров’ю в чистому вигляді. Вони утворюють ліпопротеїни, білкова частина яких забезпечує перенесення всього комплексу кров’ю (мал. 29.1). Якщо баланс ліпідів у крові змінюється, виникають патологічні
білок кровоносної системи тварин, який оборотно зв’язується
• Гемоглобін і еритроцити
• Газообмін у тканинах Згадайте
Транспорт газів Кровообіг у тварин виконує одну з найважливіших функцій — перенесення кисню від легенів до тканин, а вуглекислого газу — від тканин до легенів. Ці гази можуть транспортуватися у плазмі крові як у розчиненому вигляді, так і за
допомогою спеціальних переносників. Спо-
луки, що зв’язують і транспортують кисень
і вуглекислий газ, називають дихальними пігментами. Такими дихальними пігментами є гемоглобін і гемоціанін. Вони перебувають у розчиненому стані (у гемолімфі безхребетних) або містяться в кров’яних клітинах —
еритроцитах (у крові хребетних).
Дихальні пігменти є металопротеїнами —
комплексами білків з атомами металічних
елементів. Атоми металічних елементів відіграють ключову роль у приєднанні й транспортуванні кисню.
Кисень головним чином зв’язується
і транспортується дихальними пігментами (у людини — гемоглобіном). Концентрація O2 в плазмі крови дуже незначна, тому що цей газ погано розчиняється у воді.
Основна частина вуглекислого газу, навпаки, транспортується плазмою крові. Приблизно
дихання до тканин. Крім того, гемоглобін бере участь у транспортуванні вуглекислого газу у зворотному напрямку.
максимально чотири молекули O2.
Форми гемоглобіну
У капілярах легенів кисень приєднується до гемоглобіну, утворюючи оксигемоглобін. Оксигемоглобін надає артеріальній крові червоного забарвлення. Потоком крові еритроцити, що містять оксигемоглобін, доставляються до органів; тут кисень вивільняється і переходить у тканини. Віддавши кисень, гемоглобін зв’язує невелику кількість вуглекислого газу, переносячи його в легені. Сполуку

складається з одного поліпептидного ланцюга, що несе гем з атомом Феруму (мал. 30.2). Міоглобін зв’язує і зберігає кисень, створюючи в м’язах його резерв. Цей резерв витрачається у разі кисневого голодування, наприклад, під час інтенсивної роботи м’язів. Міоглобін надає м’язовим волокнам червоного кольору.
Гемоціанін
Гемоціанін — купрумовмісний білок, що зв’язує і переносить кисень у молюсків (го-


ловоногих, черевоногих) та членистоногих (мечохвостів, павукоподібних, ракоподібних). Під час зв’язування кисню безкольоровий

Згадайте
• Газообмін • Дихальна система
Органи дихання тварин
Надходження газів до організму тварин забезпечує дихальна система, функцією якої є постачання до організму кисню і виведення з нього газоподібних продуктів обміну, насамперед вуглекислого газу. Дифузія газів
тварин — водних (ракопо-
дібних, червів) або наземних, які мешкають у вологих умовах (червів, амфібій). У наземних видів покриви зволожені, із великою кількістю залоз, пронизані густою мережею кровоносних капілярів.
Зябра — органи дихання водних або напівводних тварин (рак оподібних, молюсків, риб, амфібій). У безхребетних зябра є виростами поверхні тіла, у хребетних
Органами дихання ракоподібних є зябра, які розташовані
постійно
в трахеї під час розширення тіла і видавлюється під час його стиснення.
Легені — органи дихання наземних тварин (деяких черевоногих молюсків, амфібій, рептилій, птахів, ссавців). Еволюційно виникли як вирости травного тракту. Часто мають коміркову будову і повітроносні шляхи. Густо обплетені кровоносними судинами. Повітря в легені активно нагнітається роботою м’язів.
Етапи еволюції зябрового апарату у хордових:
• зменшення числа зябрових щілин (від 150 пар зябрових щілин у ланцетника до 4–7 пар зябрових мішків у кісткових риб);
• збільшення дихальної поверхні шляхом утворення зябрових пелюсток;
• розвиток у кісткових риб зябрових кришок, які нагнітають потік води.
• відокремлення дихальних


• Продихи • Автотрофи, гетеротрофи
• Дихання • Хемотрофи, фототрофи
• Фотосинтез • Осмос, тургор
Рослини й гриби мають спільні риси:
вони ведуть нерухомий спосіб
поживні речовини.
Але ці групи організмів відрізняються
одна від одної за дуже важливою ознакою: рослини є автотрофами, тоді як гриби належать до гетеротрофів. Отже, рослини поглинають з навколишнього середовища мінеральні речовини, тому що органічні вони синтезують самі. На відміну від рослин, гриби поглинають із середовища і мінеральні, й органічні сполуки.
Рослини й гриби, як і всі живі організми, дихають. При цьому вони поглинають
атмосферний кисень і виділяють у навколишнє середовище вуглекислий газ. Але рослини
здатні до фотосинтезу і водночас потребують
надходження як кисню (для дихання), так
і вуглекислого газу (для фотосинтезу).
необхідної для активного поглинання елементів мінерального
вода з розчиненими в ній поживними речовинами надходила із субстрату (наприклад ґрунту) у міцелій, гриби створюють у клітинах високий осмотичний тиск, наслідком якого є утворення тургору (мал. 32.2).
Такий спосіб живлення змушує тіло гриба
повністю занурюватися в субстрат. Розгалужений
міцелій допомагає грибу охопити максимальну
площу для вилучення поживних речовин. При цьо-
му гриб не може мати великі розміри, тому що
надходження поживних речовин у глибину тіла
викликає труднощі. Як джерела енергії гриби використовують складні органічні речовини. Але, як вам відомо, великі біополімери не можуть проникати в клітину
крізь її мембрану. Тому гриби виділяють у навколишнє середовище ферменти, які руйнують високомолекулярні полімери до мономерів, що потім
надходять у клітину.
Відповідно, гриби розвиваються на ґрунтах, багатих на органічні речовини. Часто гриби використовують як живильне середовище інші організми або їхні залишки (паразитичні й цвілеві гриби, копрофаги, трутовики). Іноді гриби вступають у взаємовигідні харчові взаємовідносини з рослинами (мал. 32.3).
Газообмін у грибів
Як і для інших аеробних організмів, для грибів характерно кисневе дихання, що забезпечує вилучення енергії з їжі. При цьому деякі гриби, наприклад дріжджі, можуть обходитися малою




Поміркуйте
Чим різняться живлення лисиці, дощового черв’яка та мідії?
• Гетеротрофи
• Паразити, симбіонти, сапротрофи Згадайте
Основні способи гетеротрофного живлення Як ви вже знаєте, гетеротрофні організ-
не здатні синтезувати органічні речовини з неорганічних шляхом фото- або хемосинтезу. Їм необхідні готові органічні речовини, вироблені іншими організмами; вони отримують їх з їжею.
Способи гетеротрофного живлення поділяють на кілька типів:
• залежно від джерела поживних речовин — на голозойне, сапротрофне, симбіотрофне, паразитичне;
• залежно від механізму поглинання їжі — на фаготрофне та осмотрофне.
Голозойне живлення
Голозойне живлення — живлення, що складається з етапів поглинання їжі, її перетравлювання, всмоктування, асиміляції й виділення неперетравлених залишків. Голозойний тип живлення характерний для тварин.

Вільноіснуючі голозойні організми мають травну систему. Тварин, що живляться голозойним способом, можна поділити на м’ясоїдних, рослиноїдних і всеїдних.
Сапротрофне живлення Сапротрофне живлення — тип живлення, за якого організм
органічними рештками. Сапротрофні організми виділяють ферменти на мертвий або органічний матеріал, що розкладається. Перетравлення
сапрофіти (паразитичні квіткові
Серед сапротрофів виділяють детритофагів, некрофагів, копрофагів (мал. 33.1).
дрібних (від кількох мікрометрів до кількох сантиметрів) частинок — залишків рослинних або тваринних організмів або їх виділень. Детрит міститься у ґрунтах, суспензіях або донних відкладах водойм. Водні детритофаги беруть участь у біологічному очищенні вод (наприклад, двостулкові молюски), а ті, що мешкають у ґрунті,— у ґрунтоутворенні (ґрунтові бактерії, дощовий черв’як).
організми, що живляться померлими тваринами. Некрофагами є






комах (жуки-мертвоїди, шкіроїди, личинки
двокрилих); деякі птахи (грифи, сипи, марабу, крук тощо) та ссавці (гієни). Некрофаги
відіграють значну роль у природних екосистемах, роблячи внесок у розклад решток
мертвих тварин.
Копрофаги — це тварини, що живляться екскрементами. Представниками є жуки-
гнойовики, деякі двокрилі та їхні личинки, деякі кліщі та інші. Копрофаги прискорюють розклад органічних решток та підвищують родючість ґрунту.
Беручи участь у мінералізації органічних сполук, сапротрофи є важливою ланкою в кругообігу речовин і енергії. Багато сапрофагів відіграють позитивну роль «санітарів місцевості». Однак деякі з них, наприклад мухи, переносять збудників хвороб з екскрементів на харчові продукти, сприяючи поширенню захворювань — дизентерії, черевного тифу, гельмінтозів. Хребетні сапрофаги (зокрема, свині), поїдаючи трупи, сприяють циркуляції трихінельозу, лептоспірозу, токсоплазмозу та інших захворювань.
Симбіотрофне живлення
Симбіотрофне живлення — тип живлення, характерний
якого організм отримує
речовини від організму хазяїна, завдаючи йому істотної шкоди. Так живляться деякі найпростіші (малярійний плазмодій, дизентерійна амеба), бактерії (дифтерійна паличка, холерний вібріон, стафілококи), вищі рослини (повитиця європейська, вовчок), тварини (сисуни, стьожкові черви, аскариди) (мал. 33.2). Способи поглинання їжі За способом поглинання їжі гетеротрофів поділяють на фаготрофів та осмотрофів. Фаготрофи заковтують тверді шматки їжі; до них належать тварини. Осмотрофи поглинають органічні
Всередині
Згадайте
• Травлення • Травні ферменти
• Ендоцитоз • Лізосоми
Способи травлення
Травлення — процес, за якого відбувається перетравлювання їжі та її засвоєння клітинами. У результаті харчові продукти перетворюються на компоненти, позбавлені видової специфічності й придатні до засвоєння.
Існують різні способи травлення:
• внутрішньоклітинне — поживні речовини надходять усередину клітини і розщеплюються ферментами її цитоплазми або лізосом;
• позаклітинне (порожнинне й зовнішнє) — відбувається у позаклітинному середовищі завдяки ферментам, які виділяють клітини;
• пристінкове —відбувається на структурах клітинної мембрани.
Внутрішньоклітинне травлення Внутрішньоклітинне травлення — тип травлення, за якого поживні речовини розщеплюються ферментами в клітинах організму. При цьому клітина активно захоплює поживні речовини з навколишнього середовища шляхом ендоцитозу. Внутрішньоклітинне травлення найдавніше з еволюційної

тозу (мал. 34.2). У
участь лізосоми. Ці
понад 30 гідролітичних ферментів, що
білки, нуклеїнові кислоти, вуглеводи й ліпіди. Лізосоми, що відбруньковуються від
Гольджі, містять ці ферменти в
лізосомами



Коли первинні лізосоми зливаються з травними (фагоцитозними) вакуолями, гідролітичні ферменти активуються. Такі лізосоми, що утворюються в результаті злиття первинних лізосом з травними вакуолями і містять активні ферменти, називають вторинними лізосомами.
Під дією гідролітичних ферментів лізосом біологічні полімери розщеплюються до
мономерів, які надходять у цитоплазму.
Після перетравлення лізосома стає залишковим тільцем з неперетравленими залишками їжі й ферментами. Залишкові тільця видаляються з клітини під час злиття травної вакуолі із зовнішньою мембраною.
Роль протеосом у внутрішньоклітинному травленні
У клітинах еукаріотів, архей та деяких бактерій у гідролізі білків беруть участь та-
кож протеосоми — великі білкові комплекси, що складаються з великого числа протеаз.
Протеази — це ферменти, що руйнують білки. Протеосоми перетравлюють білки, які стають непотрібними клітині після виконання своїх функцій, а також пошкоджені
й неправильно згорнуті білки (мал. 34.3).
До того ж, протеази видаляють білки вірусів і надлишкові ферменти.
До білків, що підлягають руйнуванню, прикріплюються молекули спеціального біл-


ка убіквітину, який розпізнається протеосомою.
Протеази протеосом розривають пептидні зв’язки у молекулах білків (здійснюють протеоліз). У результаті утворюються короткі пептиди завдовжки 7–8 амінокислот.
функціональну
знищення непотрібних структур,
під час заміни старих органел новими, або для перетравлення білків та інших речовин, утворених усередині самої клітини. Автоліз — самоперетравлення клітин після руйнування мембран лізосом, спричиненого патологічними змінами або старінням. Автоліз призводить до загибелі клітини. Іноді цей процес не є патологічним, а супроводжує розвиток



органічні молекули, які не можуть проникнути безпосередньо крізь клітинну мембрану. Біологічні
лекули руйнуються до невеликих сполук,
Комахоїдні рослини застосовують різні приманки, приваблюють комах забарвленням, солодкими виділеннями або запахом. Вони ловлять здобич за допомогою липких
виділень і ловчих апаратів (видозмінних листків) — схлопувальних листків, ловчих глечиків (мал. 35.1). У пастку виділяються ферменти, які перетравлюють спійману жертву. Утворені продукти травлення, переважно амінокислоти, всмоктуються і засвоюються.
Зовнішнє травлення у членистоногих
Особливий вид живлення — зовнішнє
травлення — характерне для деяких дрібних
представників тварин: павуків, хижих личинок жуків, бабок і мух. Ці хижаки спочатку
впорскують у тіло здобичі травні ферменти, які розм’якшують тверді тканини, а потім усмоктують частково перетравлену їжу.
Дізнайтеся більше У деяких видів морських зірок формується об’ємний шлунок, здатний вивертатися через рот. Зірка обволікає шлунком здобич, яку не може проковтнути (наприклад, мушлю молюска), і таким чином здійснює зовнішнє травлення. Морська зірка Patiria miniata розстеляє свій шлунок по дну і перетравлює органічні речовини, що знаходить.


Наприклад, хижа личинка жука-плавунця, схопивши свою жертву щелепами, впорскує в неї травну рідину, яка
здобич (мал. 35.2). Наступна
вук висмоктує утворений поживний розчин. Пристосуванням павуків для харчування рідкою їжею є
тварини будуть перетравлювати їжу, тільки виділяючи травні
• Травна система • Травні ферменти
• Пасивний та активний транспорт речовин через мембрану
Порожнинне травлення
Порожнинне травлення — тип позаклітинного травлення, за якого поживні речовини розщеплюються ферментами в порожнинах травного тракту. Порожнинне травлення
забезпечує гідроліз великих харчових молекул до оліго- та мономерів. Такий тип травлення характерний для багатоклітинних
організмів — круглих і кільчастих червів, молюсків, членистоногих і хордових.
Органи травлення складаються з травного каналу і травних залоз. Травний канал утворюють ротова порожнина, стравохід, шлунок, кишечник. Кишечник людини ділиться на тонкий і товстий. Слинні залози, залози шлунка й кишечника, підшлункова залоза виділяють

травні соки. Травні соки містять ферменти (гідролази), які здійснюють гідроліз полімерів — білків, складних вуглеводів, жирів. Порожнинне травлення завершується утворенням невеликих молекул — дисахаридів, дипептидів, жирних кислот, моногліцеридів.
Пристінкове травлення
Пристінкове травлення відбувається на величезній поверхні тонкого кишечника, утвореної складками, ворсинками й мікроворсинками слизової оболонки. Воно здійснюється завдяки гідролітичним ферментам, які вбудо-
характерний рельєф завдяки наявності складок, ворсинок і крипт (мал. 36.1). Ці структури збільшують загальну поверхню тонкого кишечника в 600 разів, що сприяє здійсненню функції травлення. На складках стінок тонкого кишечника є випинання слизової оболонки — ворсинки. Висота ворсинок становить 0,5–1,5 мм. На 1 мм2 слизової

Протеолітичні ферменти (протеази)
Амілолітичні ферменти (амілази)
Пепсин, трипсин Шлунок, підшлункова залоза
α- і β-амілаза, β-галактозидаза
Слинні залози, підшлункова залоза, слизова оболонка кишечника
Полісахариди Олігоі моносахариди Ліполітичні ферменти (ліпази)
Ліпаза шлункового соку, ліпаза підшлункової залози, ліпаза кишкового соку
ляр (мал. 36.2). У кожну ворсинку входить по 1–2 артеріоли, які розпадаються на капіляри. З капімлярів кров збирається у венулу, яка проходить уздовж осі ворсинки.
Будова мікроворсинок тонкого
кишечника
Основну масу епітеліальних клітин, які вкривають ворсинку, становлять ентероцити. Ентероцити покриті мікроворсинками, у середньому до 1700–3000 штук
на клітину. Висота кожної мікроворсин-
ки — близько 1 мкм. На 1 мм2 епітелію тонкого кишечника розташовано близько 50–200 млн таких мікроворсинок. Завдяки їм поверхня пристінкового травлення
і всмоктування збільшується в 30–40 разів. У мембрани мікроворсинок убудовані
ферменти, які беруть участь у розщепленні та транспорті речовин, що всмоктуються (мальтаза, інвертаза, лактаза, трегалаза, лужна фосфатаза, моногліцеридліпаза, пептидази тощо). Ці ферменти синтезуються всередині ентероцитів і вбудовуються в їхню мембрану як інтегральні білки. Процеси, що відбуваються на мікроворсинках, отримали назву пристінкового (мембранного) травлення. Вони були вперше описані українським ученим О. М. Уголєвим 1958 року.
Шлунок, підшлункова залоза, слизова оболонка кишечника
Нейтральні жири
Гліцерол і жирні кислоти
Всмоктування речовин у тонкому кишечнику Кінцеві продукти травлення транспортуються всередину ентероцита, звідки переносяться в кров (амінокислоти, вуглеводи) або лімфу (жири). Перенесення речовин відбувається шляхом пасивного й
транспорту. Абсорбція води відбувається
(Ca2+,
Mg2+, Zn2+, Cu2+) всмоктуються шляхом простої або полегшеної дифузії. Всмоктування йонів Na+ відбувається шляхом
більшості органічних речовин відбувається завдяки активному закачуванню через мембрану ентероцита (спеціальними переносниками з використанням АТФ) і наступним пасивним транспортуванням у кров або лімфу. Так, наприклад, здійснюється всмоктування амінокислот, глюкози й галактози. Транспортування жирів здійснюється у вигляді гліцеролу й жирних кислот. Гліцерол надходить усередину ентероцитів пасивно, жирні кислоти транспортуються за участю
• Вітаміни • Бродіння • Товстий кишечник • Апендикс
Травні процеси в товстому
кишечнику У товстому кишечнику завершуються
процеси травлення під дією підшлункового, кишкового соків, відбувається часткове розщеплення харчових волокон ферментами кишкових мікроорганізмів. Залози слизової
оболонки товстої кишки виділяють небагато травного соку, який містить слиз і невелику кількість ферментів. У процесах перетравлення їжі товстий кишечник відіграє незначну роль, оскільки їжа майже повністю перетравлюється і всмоктується в тонкому кишечнику. У товстому кишечнику відбувається всмоктування води, у невеликих кількостях — солей, глюкози, вітамінів, амінокислот, часткове всмоктування білків.
Мікроорганізми, які живуть у товстій кишці, синтезують ферменти, деякі вітаміни та фізіологічно активні речовини.


Роль симбіотичних мікроорганізмів Значна роль у процесах травлення належить мікроорганізмам — бактеріям, що живуть у товстому кишечнику (мал. 37.1). До 90 % із них становлять біфідобактерії, інші види представлені лактобактеріями, стрептококами, кишковою паличкою тощо. Ферменти бактерій розщеплюють волокна клітковини (целюлозу) до оцтової кислоти, глюкози та інших продуктів. Тому роль бактерій особливо важлива в травленні травоїдних тварин, довжина товстого кишечника в яких значно більша,
Мікроорганізми зброджують вуглеводи
лоти). Кислоти пригнічують розмноження хвороботворних і гнильних бактерій.
Під дією гнильних бактерій у товстому кишечнику руйнуються невсмоктані продукти перетравлення білка.
Мікроорганізми товстого кишечника синтезують вітамін K, вітаміни групи B (B1 — тіамін, B2 — рибофлавін, B5 — пантотенову кислоту, B3 — нікотинову кислоту, B6 — піридоксин, B9 — фолієву кислоту), амінокислоти, білки та інші речовини.
Фізіологічно активні речовини, які продукуються кишковими мікроорганізмами, впливають на тонус кишкової стінки, підсилюють секрецію травного соку, сприяють посиленню процесів усмоктування води, амінокислот, йонів Кальцію, Феруму, вітаміну D.
Корисні мікроорганізми пригнічують ріст і розмноження патогенних мікробів.



Поняття про пробіотики і пребіотики
Кишкові мікроорганізми необхідні для нормального функціонування травної системи і підтримання життєвого тонусу організму. За певних умов, наприклад за умови неправильного харчування або після довготривалого лікування антибіотиками, мікрофлора кишечника пригнічується. Розвивається хворобливий стан — дизбактеріоз.
Відновити порушений баланс можна двома способами — вживанням пребіотиків
— це речовини, що сприяють росту
(лактулоза, рафіноза), розчинні харчові волокна (інулін, пектин, полідекстроза), рослинні екстракти й антиоксиданти (вітаміни A, B, C). Речовини-пребіотики містяться переважно в молочних і рослинних продуктах (кукурудзяних пластівцях, крупах, хлібі, цибулі, часнику, фасолі, горосі, бананах та інших фруктах, овочах і травах). Пробіотики — це види їжі або лікарські препарати, що містять живі мікроорганізми. Основними пробіотиками є лакто- й біфідобактерії, які є складовими кисломолочних продуктів. До продуктів-пробіотиків належать сметана, йогурт, кефір, айран, кумис, квашена капуста та інші. У разі тяжкого дизбактеріозу вживати тільки кисломолочні продукти недостатньо,
Досить часто
Згадайте
• Каталіз • Ферменти
• Метаболізм
Метаболічні шляхи У клітинах постійно відбувається безліч біохімічних реакцій, що забезпечують обмін речовин. Ці реакції утворюють певні послідовності, в яких продукти одних реакцій стають субстратами для наступних. Сукупність послідовних біохімічних реакцій, завдяки яким відбувається синтез складних сполук з простіших або розпад сполук до кінцевих продуктів, називається метаболічним шляхом. Метаболічні шляхи всіх речовин
пов’язані між собою, утворюючи єдину мережу біохімічних реакцій в організмі.
Ферментативний каталіз
Ферментативний каталіз — це прискорення біохімічних реакцій за участю ферментів. Відповідно, ферменти — це біологічні каталізатори, що прискорюють хімічні реакції в живих організмах. Реагенти в реакції, що каталізується ферментами, називаються
субстратами, а отримувані речовини — продуктами. Ферменти зазвичай є білковими макромолекулами. Вони специфічно зв’язують субстрати реакції в особливій ділянці — активному центрі (мал. 38.1). При цьому субстрати орієнтуються так, що набувають оптимального положення для перебігу реакції. Енергія активації, що необхідна для перебігу реакції, при цьому знижується (мал. 38.2).
рівняння реакції за участю ферменту має вигляд: Ф + С → ФС → Ф + П, де Ф — фермент, С
речовин. Специфічність зумовлена просторовою і хімічною структурою ділянки активного центру, що зв’язує субстрат (мал. 38.1).
Коферменти
Коферменти (кофактори) — це низькомолекулярні небілкові речовини, участь яких необхідна для каталітичної дії ферментів. Коферменти приєднуються до активного центру ферменту і беруть участь в утворенні фермент-субстратного комплексу. Коферментами є вітаміни, деякі йони (K+, Mg2+ і Mn2+).
субстрату: зменшення концентрації субстрату знижує
реакцій, а збільшення концентрації субстрату стимулює метаболічний шлях. Але основна регуляція здійснюється шляхом зміни концентрації або активності
ферментів. Концентрація певного ферменту
в клітині регулюється на етапах транскрипції і трансляції, у процесі формування і руйнування ферментного білка. Активність фер-
менту змінюється за рахунок хімічної модифікації або алостеричної регуляції.
Регуляція транскрипції ферментів Учені Ф. Жакоб і Ж. Моно сформулю-
вали теорію оперона (1961 р.), що пропонує
два механізми регуляції швидкості транскрипції у прокаріотів: індукцію і репресію. Транскрипція регулюється блокуванням або
вивільненням оператора — ділянки, з якої
починається транскрипція структурного
гена. В еукаріотів регуляція ускладнюється і залучає додаткові регуляторні ділянки геному (енхансери, сайленсери), альтернативний
сплайсинг та інші механізми.
Алостерична регуляція активності ферментів
Активність ферментів регулюється спеціальними речовинами — інгібіторами (пригнічують активність) і активаторами. Ці речовини зворотно зв’язуються з регуляторним центром молекули ферменту, який просторово віддалений від активного центру.
Зв’язування змінює третинну структуру молекули ферменту і, відповідно, структуру активного центру. У результаті змінюється
Регуляторний центр
Субстрат Субстрат
Приєднання інгібітора
Регуляторний центр Активний центр Активний центр Зниження
Приєднання активатора
Активний фермент Активний фермент Неактивний фермент
Неактивний фермент І А S S S S
Мал.
швидкість реакції, що каталізується. Така регуляція має назву алостерична регуляція (мал. 38.3). Активаторами та інгібіторами можуть бути
тип регуляції
ферментів — їх хімічна модифікація, наприклад фосфорилювання (приєднання фосфатних груп) або глікозилювання (приєднання вуглеводних залишків). Активність ферментів також регулюється шляхом обмеженого протеолізу (видалення фрагменту молекули). Таким шляхом ферменти інактивуються або, навпаки, стають активними.
Поміркуйте
Згадайте
• Катаболізм • Роль АТФ
• Субстрати та продукти реакції
Катаболізм і клітинне дихання
Як вам уже відомо, катаболізм (енер-
гетичний обмін, дисиміляція) — це процес розпаду складних речовин на більш прості, що зазвичай перебігає зі звільненням енергії. До процесів катаболізму належить клітинне, або тканинне, дихання — сукупність ре-
акцій біологічного окиснення органічних речовин, у яких організми отримують енергію, необхідну для життєдіяльності. Ця енергія запасається в хімічних зв’язках макроергічних сполук (АТФ та ін.), які є універсальним джерелом енергії для біохімічних процесів.
Виділяють два основні типи клітинного дихання: анаеробне (безкисневе) та аеробне (кисневе).
За анаеробного дихання окиснення органічних речовин і одержання енергії відбувається без участі кисню. При цьому розщеплення органічних речовин є неповним і виділяється незначна кількість енергії. До
I етап, підготовчий
Відбувається у травному каналі. Складні
нічні сполуки розпадаються на прості під дією травних ферментів. Виділяється тільки теплова енергія.
II етап, безкисневий (гліколіз)
Відбувається у цитоплазмі клітини без участі кисню. Молекула глюкози розщеплюється з утворенням 2 молекул піровиноградної кислоти. Енергія використовується для синтезу 2 молекул АТФ. IІI етап, кисневий (аеробне клітинне дихання)
біохімічних реакцій. У результаті цих реакцій з однієї молекули глюкози утворюються дві молекули пірувату (піровиноградної кислоти). Підготовчий етап гліколізу відбувається з витратою енергії двох молекул АТФ, а на останньому етапі синтезуються чотири молекули АТФ. Таким чином, енергетичний баланс гліколізу становить дві молекули АТФ на одну молекулу глюкози (мал. 39.1).
Сумарне рівняння гліколізу:
С6Н12О6 + 2АДФ + 2Ф → 2С3Н4О3 +
стадіях еволюції і сьогодні є одним з основних мета-
болічних процесів у всіх живих організмів. В аеробних організмів кінцеві продукти гліколізу підлягають подальшим перетворен-
ням у біохімічних циклах, що належать до
аеробного клітинного дихання. В анаеробних
організмів піруват далі підлягає бродінню.
А для деяких анаеробів гліколіз залишається єдиним способом одержання енергії.
Бродіння
Бродіння — це анаеробний процес окиснення вуглеводів, який дозволяє клітинам
отримувати енергію у вигляді молекул АТФ.
Першим етапом бродіння є гліколіз. На наступному етапі залежно від типу бродіння з продукту гліколізу (пірувату) утворюються спирт, молочна і лимонна кислоти або інші сполуки.
Більшість типів бродіння здійснюють мікроорганізми. Залежно від того, які речовини утворюються, виділяють декілька різновидів бродіння.
Під час молочнокислого бродіння (наприклад, у молочнокислих бактерій) утворюється молочна кислота:
C6H12O6 = 2CH3–CHOH–COOH.
Спиртове бродіння (здійснюється дріжджами і деякими бактеріями) характеризується утворенням молекул етанолу і вуглекислого газу:
C6H12O6 = 2C2H5OH + 2CO2.
За оцтовокислого бродіння (оцтовокислі бактерії) продуктом є оцтова кислота: C6H12O6 + 2O2 → 2CH3COOH + 2CO2. Відомі також маслянокисле, лимоннокис-
природі саме бродіння забезпечує енергією ті організми,
у клітинах з пірувату внаслідок бродіння утворюється молочна кислота, накопичення якої призводить до болю в м’язах після фізичних вправ. Людина використовує бродіння для одержання багатьох харчових продуктів. Наприклад, отримання кисломолочних продуктів (сметани,
Згадайте
• Гліколіз • Будова мітохондрій
Аеробне дихання
Як ви пам’ятаєте, за безкисневим етапом
катаболізму йде кисневий етап, або аеробне
дихання. Аеробне дихання характерне для більшості організмів і відбувається в мітохондріях клітини. Під час цього процесу органічні речовини, утворені у ході гліколізу, окиснюються киснем до H2O і CO2. Значна частина енергії, яка при цьому виділяється, запасається клітинами у вигляді молекул АТФ. Ключовим етапом аеробного дихання є
цикл Кребса, або цикл трикарбонових кис-
лот. За встановлення схеми циклу Х. Кребс отримав Нобелівську премію 1953 року. Саме в реакціях цього циклу утворюються сполуки, які є джерелом протонів і електронів для процесу окиснення. Переважна кількість
молекул АТФ виробляється на останній стадії клітинного дихання: у процесах окисного фосфорилювання в електроннотранспортному (дихальному) ланцюзі мітохондрій.
Цикл трикарбонових кислот Піруват, утворений у результаті гліколізу, транспортується
нього надходження
для синтезу багатьох речовин. Таким чином,
анаболічні процеси і є центром перетину багатьох метаболічних
з етапів хімічного перетворення органічних речовин
атомів Гідрогену. Вони приєднуються до спеціальних молекул — переносників Гідрогену, які доставляють їх у

собою декілька білкових комплексів, убудо-
ваних у внутрішню мембрану мітохондрії.
У мембрану також убудована АТФ-синтаза —
комплекс, що синтезує АТФ.
Вивільнені в циклі трикарбонових кислот електрони, акцептовані на коферментах
НАДН·Н і ФАДН2, надходять до дихального ланцюга, де послідовно переносяться з комплекса на комплекс (мал. 40.2). Під час перенесення електронів відбувається послідовне окиснення й відновлення елементів дихального ланцюга. Наприкінці електрони поєднуються з киснем, утворюючи молекули води. Перенесення електронів по дихальному ланцюгу супроводжується викачуванням протонів із матриксу в міжмембранний простір. Так створюється протонний градієнт, за якого концентрація протонів у міжмембранному просторі більша, ніж у матриксі. Унаслідок цього виникає різниця потенціалів з обох боків мембрани: позитивні заряди переважають у міжмембранному просторі, а негативні — у матриксі мітохондрій. Збільшення концентрації протонів у міжмембранному просторі активує АТФ-синтазу. У разі досягнення пев-
ної різниці потенціалів АТФ-синтаза транспортує протони назад у матрикс, при цьому утворюється
(перенесення електронів) спряжене з фосфорилюванням (АДФ
. Пояснення механізмів сполучення роботи дихального
челлом 1961 року.
баланс окиснення 1 молекули глюкози такий: • на стадії гліколізу утворюється 2 молекули АТФ; • на стадії аеробного дихання утворюється 36 молекул АТФ. Отже, у
Згадайте
• Будова жирних кислот, триацилгліцеридів, фосфоліпідів
• Будова амінокислот
• Будова нуклеотидів, пурини, піримідини
Джерела енергії у клітині Реакції циклу трикарбонових кислот і окисне фосфорілювання у мітохондріях є універсальним шляхом отримання енер-
для аеробних організмів. Але вуглеводи
(глюкоза, піруват) не є єдиним джерелом для синтезу ацетил-КоА, який залучений до циклу трикарбонових кислот. Ця універсальна молекула може утворюватися також під час
окиснення жирних кислот, дезамінування й окиснення амінокислот (мал. 41.1). Тобто клітина використовує різні субстрати — вуглеводи, жири та білки — для вивільнення енергії у процесах катаболізму.
β-окиснення жирних кислот Як ми вже з’ясували, головний субстрат циклу трикарбонових кислот ацетил-КоА
може утворюватися в результаті окиснення
утворюються в клітині під час ліполізу — розщеплення ліпідів.
енергії, а також фосфоліпіди мембран, що підлягають постійному оновленню.
Вільні жирні кислоти можуть бути знову використані для синтезу ліпідів (анаболічні процеси)
проходить цикл трикарбонових кислот і дихальний ланцюг. Цикл
C14
Ацетил-КоА C12
C6 Ацетил-КоА
Дезамінування амінокислот Як вам відомо, в клітинах живих організмів присутні 20 основних видів амінокислот.
Для кожної амінокислоти існує специфічний
шлях розщеплення вуглецевого скелета. Але в результаті катаболізму всіх двадцяти основних амінокислот утворюються всього шість
речовин, які можуть окиснюватися у циклі трикарбонових кислот до CO2 і H2O з утворенням АТФ (мал. 40.1).
Таким чином, катаболізм амінокислот до кінцевих продуктів вивільняє енергію. Однак
енергетична роль амінокислот, звичайно, невелика, вона складає лише 10–15 % потреби організму в енергії.
Катаболізм більшості амінокислот почи-
нається з відщеплення α-аміногрупи. Амінокислота втрачає аміногрупу в результаті двох типів реакцій: трансамінування і дезамінування. Дезамінування — це відокремлення
аміногрупи від амінокислоти з утворенням вільного амоніаку. У вищих тварин основним шляхом є окисне дезамінування, за якого, окрім амоніаку, утворюється α-кетокислота:
Оксидази L- та D-амінокислот
ФАДФАДН
Утворені α -кетокислоти окиснюються у реакціях циклу трикарбонових
Але вони також можуть перетворюватися
продуктів. Пуринові нітрогеновмісні основи (аденін, гуанін) зберігають циклічну структуру пурину. Кінцевим продуктом їх розкладу є сечова кислота (мал. 41.3). На відміну від пуринів, кільцева структура піримідинових основ (тимін, цитозин, урацил) руйнується з утворенням звичайних кінцевих продуктів катаболізму
•
•
енергії. У результаті пластичного обміну клітини забезпечуються будівельним матеріалом для створення своїх структур і органічними речовинами для етапів енергетичного обміну.
Прикладами такого біосинтезу є синтез
білків з амінокислот, синтез вуглеводів у процесі фотосинтезу, синтез жирів з гліцерину і жирних кислот.
Поняття про матричний синтез
Синтез складних полімерних молекул на основі генетичної інформації клітини, закодованої в молекулі ДНК, відбувається за типом так званого матричного синтезу.
Матричними називаються процеси синтезу, за яких на основі первинної структури одного біополімера (матриці) синтезується первинна структура іншого біополімера (копії).
До матричних процесів у живих клітинах
і процесинг іРНК відбуваються в ядрі клітини, трансляція — у цитоплазмі на рибосомах. Після синтезу поліпептидний ланцюг укладається в просторову структуру і піддається різним посттрансляційним модифікаціям.
Транскрипція На етапі транскрипції відбувається
молекули ДНК. Під час синтезу молекули РНК нуклеотиди
уридиловий нуклеотид РНК (а не тимідиловий, як у синтезі ДНК). Транскрипція здійснюється великим комплексом ферментів, головним з яких є ДНКзалежна РНК-полімераза (мал. 42.1). Така назва означає, що він створює полімерний ланцюжок РНК за зразком молекули ДНК. Процес транскрипції починається, коли РНК-полімераза виявляє на ланцюзі ДНК зону промотора. Вона прикріплюється
цюга РНК, що синтезується. Ділянка ДНК, з якої фермент уже зчитав інформацію, знову скручується в спіраль. Процес транскрипції закінчується, коли РНК-полімераза досягає
ділянки термінатора.
Дозрівання (процесинг) РНК
Дозрівання РНК є важливим етапом реалізації спадкової інформації в еукаріотів.
Воно властиве всім типам РНК і не відбувається тільки в окремих випадках.
Під час дозрівання РНК відбувається де-
кілька процесів, зокрема:
• сплайсинг — вирізання інтронів і з’єднання екзонів у синтезованій молекулі РНК за допомогою малої ядерної РНК (мяРНК) (мал. 42.2);
• кепування — додавання до початку молекули РНК декількох модифікованих нуклеотидів, які допомагають транспортувати її в цитоплазму;
• поліаденілування — додавання до кінця молекули РНК декількох аденілових нуклеотидів, які допомагають транспортувати її в цитоплазму.

Альтернативний сплайсинг Процес дозрівання дозволяє
багатостадійному процесингу, у результаті якого формується типова для тРНК просторова структура (мал. 42.3). Після дозрівання тРНК переносяться з ядра в цитоплазму
переносниками.
еукаріотів налічується від кількох сотень до десятків тисяч генів рРНК, які
Згадайте
• Будова білка • Амінокислоти білків • Пептидний зв’язок • Будова рибосом
Генетичний код Будова молекули білка визначається послідовністю нуклеотидів у ДНК. Кожна амінокислота кодується за допомогою трьох
нуклеотидів. Такий триплет нуклеотидів, відповідний певній амінокислоті, називається кодоном. Система запису спадкової інформації в молекулах нуклеїнових кислот, за якою послідовність нуклеотидів у молекулах
ДНК і РНК визначає послідовність амінокислот у молекулі білка, називається генетичним кодом.
Наприклад, триплету АУГ відповідає амінокислота метіонін (Мет), триплету АУЦ — амінокислота ізолейцин (Іле), а нуклеотиди УАА, УАГ і УГА є стоп-кодонами, вони сигналізують про закінчення синтезу поліпептидного ланцюга.
Генетичний код універсальний — він працює за однаковими принципами в організмах різного рівня складності. Однак відомо кілька винятків. У геномах мітохондрій і прокаріотів виявлено альтернативні варіанти деяких кодонів. А недавно у деяких груп організмів було відкрито дві рідкісні амінокислоти: селеноцистеїн, що кодується стоп-кодоном УГА, і піролізин, що кодується стоп-кодоном УАГ. Універсальність
Вони працюють дуже специфічно — кожна з 20-ти аміноацил-тРНК-синтетаз розпізнає тільки одну амінокислоту і відповідну їй тРНК. Молекула тРНК, ковалентно пов’язана з амінокислотою, називається аміноацил-тРНК. Трансляція Трансляція, або біосинтез білка,— це етап, під час якого за інформацією,
ланцюг молекули білка. Процес трансляції відбувається в рибосомах, які містяться в цитоплазмі
тини. Синтез відбувається згідно з генетичним кодом, тобто кожному триплету нуклеотидів іРНК відповідає певна амінокислота.
Біосинтез білка забезпечується енергією за рахунок розщеплення АТФ.
Процес трансляції складається з трьох етапів: ініціації, елонгації та термінації.
Ініціація — початок синтезу поліпептидного ланцюга (мал. 43.1, А). На цьому етапі відбувається: приєднання малої субодиниці рибосоми до ланцюга іРНК, розпізнавання старт-кодону, приєднання великої субодиниці рибосоми та транспорт до рибосоми першої амінокислоти.
Старт-кодоном завжди є кодон АУГ. До нього приєднується тРНК, що приносить до рибосоми амінокислоту
На мал. 43.1, Б наступним кодоном є ГУЦ, а наступною амінокислотою, яка транспортується за допомогою тРНК,— валін.
Між двома амінокислотами утворюється пептидний зв’язок. Молекула тРНК при цьому звільняється і залишає рибосому.
Після цього рибосома переміщується до наступного триплету іРНК, розпізнає його та приєднує наступну
молекулу тРНК, яка приносить до рибосоми відповідну амінокислоту. Вона приєднується до попередньої амінокислоти за допомогою пептидного зв’язку, і поліпептидний ланцюг подовжується. Термінація — завершення трансляції (мал. 43.1, В). Починається з розпізнавання рибосомою стопкодону — УАА, УАГ або УГА. Синтез
поліпептидного ланцюга завершується, рибосома розпадається на субодиниці,
молекули тРНК та іРНК звільняються.
Рибосоми
Рибосоми — немембранні органели, що складаються з рибосомних білків і молекул рРНК. Рибосома може дисоціювати на дві окремі субодиниці — велику й малу.
По суті, рибосома — це величезний фермент, активний центр якого каталізує синтез пептидних зв’язків. Також
на рибосомах є ділянки зв’язу вання іРНК і тРНК, ділянки зв’язування рибосомних субодиниць одна з одною, ділянки зв’язування рибосом з мембра-
нами ендоплазматичного ретикулуму. На одній молекулі іРНК одночасно може «працювати» кілька рибосом. Спільно
цес спонтанного згортання поліпептидного ланцюга має назву фолдінг. Кінцева
первинною структурою, тобто послідовністю амінокислот у поліпептидному ланцюжку. Властивості амінокислот,
Згадайте
• Будова амінокислот
• Радикали амінокислот
• Гідрофільність, гідрофобність
• Третинна і четвертинна структури білків
Дозрівання білка
Після закінчення синтезу може відбуватися процес посттрансляційного дозрівання білка. Посттрансляційні зміни включають видалення фрагментів поліпептидного ланцюга, приєднання небілкової частини, остаточне формування просторової структури молекули. У результаті формується функціонально активний білок.
Фолдінг
Залишаючи рибосому, поліпептидний ланцюг згортається, і білок набуває певної просторової структури (конформації). Про -
а гідрофільні розподіляються по поверхні. Також формування структури білка визначається утворенням зв’язків (гідрофобних, електростатичних та ін.) між радикалами амінокислотних залишків (мал. 44.1). Для підтримання конформації білкових молекул величезне значення має формування ковалентних дисульфідних зв’язків між атомами Сульфуру бічних радикалів цистеїну.
властивості й функції. Зокрема, в молекулах ферментів формуються активні центри, що виконують каталітичні функції. На окремих поліпептидах у складі білків з четвертинною структурою формуються поверхні, що контактують завдяки нековалентним зв’язкам (гідрофобним, йонним, водневим). У молекулах білків клітинних мембран формуються канали для трансмембранного транспорту речовин. Неправильна просторова структура спричиняє утворення неактивних

Згорнута
молекула
білка
Мал. 44.2. Принцип роботи шаперонів N N N 5’ 3’ іРНК
Шаперони
білки шаперони. Вони допомагають синтезованим білкам згортатися в правильну конформацію (мал. 44.2).
Шаперони не тільки беруть участь у фол-
дінгу дозріваючих ланцюгів, але й допома-
гають пошкодженим білкам знову набути
правильної конформації. Наприклад, синтез шаперонів певного класу (білків теплового шоку), що беруть участь у стабілізації пептидів, зростає за підвищення температури та інших формах стресу. При цьому вони захищають білки клітини від денатурації.
Посттрансляційні модифікації
Після завершення трансляції велика частина білків піддається подальшим хімічним модифікаціям.
Відомо більше двохсот варіантів посттрансляційних модифікацій білків. Багато з них здійснюються на мембранах ендоплазматичного ретикулуму. Білки піддаються ацетилюванню, глікозилюванню, фосфорилюванню та іншим хімічним перетворенням. Наприклад, глікозилювання є необхідним етапом дозрівання білків плазматичної мембрани. Для багатьох білків, особливо ферментів, важливим є приєднання небілкового компонента (простетичної групи). Обмежений протеоліз
білків необхідне утворення зв’язків між окремими ланцюгами (наприклад, у молекулі гемоглобіну об’єднуються чотири окремі ланцюги).
Синтез і дозрівання цитоплазматичних, мембранних і секреторних білків Водорозчинні білки для внутрішніх потреб цитоплазми синтезуються
з мембранами ендоплазматичного ретикулуму. Після синтезу білки зовнішніх
убудовуються в мембрану ендоплазматичного ретикулуму і доставляються до апарату Гольджі, а потім — до поверхні клітини. Секреторні білки також транспортуються до апарату Гольджі, але не по мембранах, а по по каналах ендоплазматичного ретикулуму. Для подальшого транспорту вони пакуються апаратом Гольджі у секреторні пухирці. У каналах ендоплазматичного ретикулуму і цистернах
Згадайте
• Пластиди • Хлорофіл
• Будова хлоропластів
Фотосинтез
Фотосинтез — це процес утворення живими організмами органічних речовин з неорганічних з використанням енергії світла: 6CO2 + 6H2O + Енергія світла = C6H12O6 + 6O2
Процес фотосинтезу складається з двох
основних фаз — світлової і темнової. Під час світлової фази кванти світла вловлюються хлорофілом, енергія квантів використовується для синтезу АТФ і НАДФ · H2. Побічним
продуктом є кисень. У ході темнової фази за рахунок АТФ та інших продуктів світлової фази відбувається фіксація молекул CO2 і
утворюються молекули глюкози.
До фотосинтезу здатні рослини і деякі
бактерії.
У клітинах рослин фотосинтез відбувається в хлоропластах: світлова фаза — на
мембранах тилакоїдів, темнова — у стромі.
Світлова фаза: поглинання енергії Сонця
Сонячна енергія уловлюється фотосинтетичними пігментами, серед яких основну роль відіграє хлорофіл a. Крім того, існують хлорофіли b, c, d, f. Допоміжними пігмента-
є каротиноїди (жовті, помаранчеві,

тром
люють енергію
і передають її в реакційний центр. Світлова фаза: фотоліз води У рослин фотосинтез починається з фотосистеми II. Енергія поглиненого світла від антенних комплексів передається в реакційний центр ФС II і переводить один з електронів хлорофілу а в збуджений стан (мал. 45.2). Збуджений електрон передається на молекулу-переносник, а в молекулі хлорофілу з’являється позитивно заряджена електронна «дірка».
Втрачений хлорофілом електрон заміщується електроном, який утворюється в результаті
Світлова фаза: фотосинтетичний ланцюг перенесення електронів Електрон, випущений збудженим хлорофілом ФС II, через ланцюг молекул-переносників передається до ФС I. Там він
електронну «дірку», яка утворюється під час
у внутрішньотилакоїдний простір. На мембрані тилакоїдів виникає електрохімічний градієнт. Накопичені протони «прориваються» з внутрішньотилакоїдного
поглинання кванта світла хлорофілом ФС I. Тут електрон збуджується вдруге і бере участь у відновленні НАДФ+ до НАДФ · H2. Такий рух електронів
на-
нециклічним потоком, або Z-схемою. У мембранах тилакоїдів можуть здійснюватися циклічні потоки електронів. У них
електрон збуджується тільки в реакційному центрі ФС I, і не відбувається утворення НАДФ · H2. Потік стає циклічним, коли електрони від реакційного центру ФС I пере-
даються не на НАДФ+, а повертаються назад, у ланцюг переносників електронів від ФС II до ФС I. Такий рух електронів забезпечує тільки АТФ, але не НАДФ · H2.
Світлова фаза: протонний градієнт на мембранах тилакоїдів
Перенесення електронів супроводжується іншим процесом: переносом протонів H+
3.
Згадайте
• Моносахариди, полісахариди
• Крохмаль, целюлоза, глюкоза, сахароза
Процеси темнової фази фотосинтезу
У процесах темнової фази фотосинтезу утворюються вуглеводи — первинні органічні речовини. Саме в цій фазі відбувається включення атмосферного CO2 у склад біосфери. Реакції синтезу органічних речовин відбуваються з використанням енергії, накопиченої у ході світлової фази (мал. 46.1).
Темнова фаза фотосинтезу здійснюється у стромі хлоропластів. Ця фаза називається темновою тому, що світло не бере в ній безпосередньої участі. У рослин вона відбувається як удень, так і вночі.
Сукупність послідовних реакцій темнової фази називається циклом Кальвіна. Цикл названий на честь американського біохіміка Мелвіна Кальвіна, який отримав за його відкриття Нобелівську премію з хімії 1961 р.
Цикл Кальвіна Під час біохімічних реакцій циклу
віна за участю вуглекислого
НАДФ · H2 і АТФ утворюються молекули глюкози. Синтез 1 молекули глюкози відбувається за 6 обертів циклу і
Кальвіна складається з трьох стадій: карбоксилювання, відновлення та регенерації (мал. 46.2). Карбоксилювання. Ця стадія
каталізується ферментом рибулозобісфосфаткарбоксилазою (скорочено — RuBisCo). Процеси карбоксилюваня здійснюються за участю АТФ, отриманої під час світлової фази фотосинтезу. Нова, вже 6-карбонова сполука, нестійка і швидко розкладається на дві молекули 3-фосфогліцеролової кислоти (3-ФГК). Відновлення. 3-ФГК відновлюється до 3-фосфогліцеролового альдегіду (3-ФГА), частина молекул якого йде в цитоплазму на синтез 6-карбонового моносахариду (глюкози

або фруктози). Тут, крім АТФ, використовується також НАДФ · H.
Регенерація. Частина молекул 3-ФГА використовується для синтезу рибулозо-1,5бісфосфату, який вступає в новий цикл.
Фермент RuBisCo
RuBisCo (мал. 46.3) є дуже важливим ферментом на Землі, оскільки саме він включає неорганічний CO2 з атмосфери у біологічний кругообіг. Іншого подібного ферменту не існує. Цей фермент виявлений у фотосинтезуючих клітинах усіх наземних і водних еукаріотичних фототрофів і ціанобактерій, у більшості пурпурних і зелених бактерій та у безхлорофільних хемоавтотрофних бактерій. Вважається, що це найпоширеніший
на Землі і переважний у кількісному від-
ношенні білок.
Реакція, що каталізується ферментом RuBisCo, відбувається дуже повільно (кілька молекул CO2 на секунду), тому в стромі хлоропластів цей фермент може становити до половини всього білка. На рівні цього ферменту здійснюється регуляція швидкості циклу Кальвіна.




Синтез, запасання і використання
крохмалю
Трикарбонові фосфосахариди (3-ФГА), що утворилися на другій стадії циклу Кальвіна, транспортуються в цитоплазму клітини, де з’єднуються один з одним і утворюють шестикарбоновий сахарид — глюкозу або фруктозу. Надалі
целюлозу та інші сполуки: nC6H12O6→ (C6H10O5)n + nH2O. Крохмаль є основним
ся у вигляді крохмальних зерен діаметром від 1 до 100 мкм. Зазвичай крохмаль концентрується в листках у
фотосинтезу, після чого перетворюється на розчинну сахарозу, яка транспортується в інші частини рослини. Крохмаль накопичується у насінні й використовується під час проростання. Відкладення крохмалю накопичуються також у підземних пагонах (бульбах, цибулинах, кореневищах), паренхімі провідних тканин коренів і стебел. Особливо багатими на крохмаль
• Прокаріоти
• Автотрофи, гетеротрофи Згадайте



відбувається в цитоплазмі та
складках
матичної мембрани — мезосомах. На мезосомах розташовані фотосинтезуючі пігменти — бактеріохлорофіли, які здійснюють світлову фазу фотосинтезу; темнова фаза відбувається в цитоплазмі. Подібно до хлорофілу, бактеріохлорофіли поглинають енергію світла й випускають електрони, які передаються по електроннотранспортному ланцюгу
(мал.
• забезпечується хлорофілом а;
• супроводжується виділенням молекулярного кисню;
• відбувається з фотолізом води як джерела електронів. Безкисневий (аноксигенний) фотосинтез відбувається в пурпурних, деяких зелених і геліобактерій (мал. 47.2). Це найдавніші, примітивні форми фотосинтезу, які:
• забезпечуються бактеріохлорофілом;
• відбуваються без виділення кисню в навколишнє середовище;
• як донора електронів використовують не воду, а інші речовини — гідроген сульфід, молекулярний Гідроген, молекулярний Сульфур, тіосульфат, органічні сполуки. В екстремальних галофільних архебактерій виявлений так званий безхлорофільний фотосинтез. Роль хлорофілу в них виконує білок бактеріородопсин (мал. 47.3). Це фіолетовий світлочутливий пігмент, подібний

0 1 2 3 4 5 6

конкурувати за них з гетеротрофами, посіли нові екологічні
форм і видів. Наступним етапом була поява кисневого
фотосинтезу. Молекулярний кисень видалявся з клітин як побічний продукт, оскільки він був токсичний для давніх автотроф-
них анаеробів. Згодом кисень накопичувався в атмосфері, й організми почали виробляти способи захисту від його токсичної дії. Так
виникли аероби. З’явилися нові метаболічні шляхи, що використовують кисень для ефективного вироблення енергії ( кисневе
дихання). Анаероби зникли або збереглися
у важкодоступних місцях. Унаслідок високої концентрації кисню
в атмосфері сформувався озоновий шар. Він
захищав планету від жорсткого сонячного
випромінювання. Організми змогли вийти з води на суходіл, що зумовило різкий стри-
бок видоутворення.
на рік (у перерахунку на суху речовину). За час існування життя на Землі органічні залишки накопичувалися і модифікувалися (гумус ґрунтів, мул, торф, кам’яне вугілля, осадові породи морів і океанів).
• Підтримка складу атмосфери. Щорічно в ході фотосинтезу в атмосферу надходить 70–120 млрд тонн кисню. Сьогодні він становить близько 21 % за обсягом повітря. Фотосинтез і дихання підтримують
Сьогодні основними фотосинтезуючими організмами на Землі є зелені рослини і ціанобактерії. Фотосинтез є основним джерелом біологічної енергії (мал. 47.4). Фотосинтезуючі автотрофи використовують її для синтезу органічних
отримує
від реакцій окиснення неорганічних сполук.
Такий тип живлення характерний тільки
для бактерій і архей.
Хемосинтез здійснюється без участі світла. Це відрізняє хемосинтезуючі організми від фотосинтезуючих, оскільки останні використовують як джерело енергії сонячне світло, а не енергію хімічних реакцій. Для одержання енергії мікроорганізми використовують енергію реакцій окиснення сірководню, амоніаку, водню, ферум(II) оксиду та інших речовин. Енергія, що отримується під час окиснення, запасається у формі АТФ. Речовинами, з яких відбувається синтез органічних молекул, є вуглекислий газ або метан.

Процес хемосинтезу відкрив 1889 року видатний український мікробіолог С. М. Виноградський.
Групи хемосинтезуючих організмів Залізобактерії. Існують за рахунок окиснення Феруму (двовалентного Fe2+ до тривалентного Fe3+):
4Fe(OH)2 + O2 = 4H2O + 2Fe2O3
Утворений ферум(III) оксид залізобактерії відкладають у своїй слизовій оболонці. Ці мікроорганізми поширені в прісних і морських водоймах (мал. 48.1, 48.2).
Сіркобактерії. Окиснюють сірководень (гідроген сульфід) до молекулярної сірки: 2H2S + O2 = 2H2O + 2S У разі нестачі сірководню окиснюють сульфур до сульфатної кислоти: 2S + 3O2 + 2H2O = 2H2SO4
Сіркобактерії можуть жити в океанах на величезній глибині, у тих місцях, де з розломів земної кори у воду виходить сірководень. Колосальна кількість сіркобактерій існує в Чорному морі, в якому на глибинах понад
Тіонові бактерії. Окиснюють відновлені сполуки Сульфуру та двовалентного Феруму до сульфатної кислоти. Деякі представники тіонових
концентрацій кислоти (pH = 2). Більшість із них

Нітрифікуючі бактерії. Окиснюють амоніак, що утворюється в процесі гниття органічних речовин (білків), до нітритної та
нітратної кислот: 2NH3 + 3O2 = 2HNO2 + 2H2O, 2HNO2 + O2 = 2HNO3
Утворені кислоти взаємодіють з ґрунтовими мінералами, утворюючи нітрити та
нітрати. Нітрифікуючі бактерії поширені в ґрунті та водоймах. Багато з них є симбі-
онтами рослин.
Водневі бактерії окиснюють водень, який
утворюється під час анаеробного розкладання
органічних решток: 2H2 + O2 = 2H2O. Отриману енергію використовують для перетворення CO2 на метан та інші органічні сполуки.
Значення хемосинтезу
Органічна продукція хемосинтезу становить менше 1 % від фотосинтезу, проте він має величезне значення для біологічних і геохімічних процесів на Землі. Основне значення хемосинтезу полягає в тому, що він забезпечує кругообіг найважливіших елементів зі змінним ступенем окиснення: Феруму, Сульфуру, Нітрогену та інших. Суттєве значення в кругообігу Нітрогену належить хемотрофним нітрифікуючим бактеріям. Вони поширені в природі, і здійснювані ними процеси відбуваються у досить великих масштабах. Процес нітрифікації є джерелом нітратів і нітритів — сполук Нітрогену, що засвоюються рослинами і вклю-
чаються до складу органічних речовин. До того ж, життєдіяльність нітрифікуючих бак-
терій — найважливіший чинник родючості ґрунтів. Важливу роль у процесах перетворення речовин у ґрунтах відіграють також водневі бактерії.

цеві руди. Сіркобактерії, утворюючи сульфатну
Хемосинтезуючі організми виробляють органічні речовини там, де фотосинтез
робота
«Фотосинтез і хемосинтез»
1. Розрахуйте, скільки кілограмів
Залізобактерії відіграють важливу роль у кругообігу таких елементів, як Ферум і Манган. Завдяки їхній життєдіяльності на
Згадайте
• Полісахариди, глюкоза
• Будова крохмалю
• Будова жирних кислот
• Будова фосфоліпідів, жирів, холестеролу
Глікогенез
У рослинах, як ви вже знаєте з матеріалу § 46, глюкоза, що синтезована в реакціях фотосинтезу, полімеризується до крохмалю. Саме крохмаль є запасним полісахаридом рослин.
У грибів, тварин і людини вуглеводи також запасаються, але переважно у вигляді глікогену. Це полісахарид, теж полімер глюкози. Структурно глікоген є аналогом
крохмалю, але має більший ступінь розгалуженості (мал. 49.1).
Процес біосинтезу глікогену називається глікогенезом . Глікогенез стимулюється
гормоном інсуліном. Полімеризація здійснюється кількома ферментами, що будують
прямі або розгалужені ланцюжки глікогену. У лінійних ділянках основного ланцюга залишки глюкози зв’язані 1,4-глікозидними зв’язками, тоді як точки розгалуження формуються 1,6-глікозидними
(мал. 49.2).
запаси є енергетичним резервом організму, що швидко

Біосинтез жирних кислот і ліпідів
Жири в організмі синтезуються з вуглеводів, тому найшвидше жирні кислоти і жири синтезуються після вживання вугле-
водневої їжі. Найбільш активно цей процес відбувається у печінці та жировій тканині. Синтез жирних кислот і жирів називається ліпогенезом. Їхній синтез
клітини. Субстратом для синтезу є
вам сполука
ацетил-КоА. Про-
є циклічним: у кожному циклі до радикалу жирної кислоти, що поступово подовжується, додається два атоми Карбону. У кожному циклі
використовується НАДФ · H і АТФ. Кінцевим
продуктом синтезу є пальмітинова кислота, що
має 16 атомів Карбону (мал. 49.4).
Інші жирні кислоти в організмі людини
синтезуються саме з пальмітинової кислоти. Але подовження ланцюгів жирних кислот до
18, 20 і 22 атомів Карбону відбувається вже
не у цитоплазмі, а в мітохондріях.
Мал. 49.4.

синтезовані.
складу інших молекул: жирів і фосфоліпідів. Стероїдні гормони (тестостерон, естрогени) синтезуються з холестеролу.
Жири, синтезовані в печінці, транспортуються кров’ю в складі ліпопротеїнів. Жири, синтезовані в клітинах жирової тканини, запасаються в них (мал. 49.5).
На відміну від вуглеводів, жири становлять довготривалий енергетичний резерв
• Екзоцитоз • Прото- і метанефридії
У ході обміну речовин утворюються
відходи, які повинні виводитися з організму. Якщо вони накопичуються понад певної концентрації, то виникає загроза порушення нормального перебігу фізіологічних процесів.
Екскреція — це виведення з організму кінцевих продуктів обміну речовин.
Екскрети — це кінцеві продукти обміну речовин у живих організмах, які більше не беруть участі у життєвих процесах.
Основні продукти екскреції у тварин:
• вуглекислий газ, що утворюється в процесі клітинного дихання;
• нітрогенвмісні продукти розпаду білків і нуклеїнових кислот — амоніак, сечовина і сечова кислота;
• жовчні пігменти, які утворюються під час руйнування гема в печінці.
Виділення продуктів метаболізму
клітиною
Переміщення




кінець відкривається назовні видільною порою. Рухами війок продукти обміну видаляються з організму. У ракоподібних органами виділення є зе-
лені залози, розташовані біля основи антен.
Вони являють собою мішечки з каналом, який
іде до сечового міхура. Сеча накопичується
в сечовому міхурі, а потім виливається назовні. У комах і павукоподібних є мальпігі-
єві трубочки. Продукти обміну надходять туди з гемолімфи і по трубочках виводяться
в травний тракт. Крім того, у комах є жирове тіло, де накопичуються шкідливі речовини.
У молюсків головними органами виділення є нирки, схожі на метанефридії.
Еволюція видільної системи у хребетних
Система виділення хребетних еволюціонувала від окремих ниркових канальців — нефронів — до спеціальних органів — нирок, які складаються з багатьох видільних
канальців із загальною вивідною протокою. У наземних хребетних удосконалюються способи мінімізації втрати води шляхом її зворотної реабсорбції.



виконувати зворотне всмоктування
глюкози й інших речовин. Вторинні, або тазові, нирки
в плазунів, птахів і ссавців. Одиницею будови нирки є нефрон, який починається капсулою Шумлянського — Боумена з клубочком капілярів. У судинних клубочках відбувається
тільця відходить видільний звивистий каналець.
Згадайте
• Осмос • Осмотичний тиск
Осморегуляція та її механізми
Важливу роль в організмі відіграють йони Натрію, Хлору, Калію, Магнію, Кальцію, Феруму, концентрація яких повинна строго регулюватися, оскільки ці йони беруть участь у багатьох процесах, включаючи роботу ферментів, синтез білків, утворення гормонів, проникність мембран, електричну
активність і м’язове скорочення.
Регуляція відносних концентрацій розчинених речовин і води всередині тканин тіла називається осморегуляцією.
Живі організми населяють різноманітні середовища — суходіл, морські та прісні водойми. У солоній воді (гіпертонічному середовищі) вода з клітин «прагне» вийти назовні, тоді як у прісній воді (гіпотонічному середовищі) — навпаки, постійно надходить у клітину (мал. 51.1). Зрозуміло, що контроль внутрішньоклітинних умов у різних умовах існування потребує різних адаптацій.

Існує два типи реакцій тварин на концентрацію осмотично активних речовин у зовнішньому середовищі. Пойкілосмотичні тварини не мають активної системи стабілізації концентрації осмотично активних речовин; концентрація
Гомойосмотичні тварини здатні підтримувати сталість концентрації осмотично активних речовин у рідинах внутрішнього середовища. Способи осморегуляції гомойосмотичних тварин, що регулюють уміст води в організмі, різноманітні. Виділяють гіперосмотичні і гіпоосмотичні механізми регуляції.
Гіперосмотична регуляція
рідинах тіла вища, ніж у навколишньому середовищі, тому вода постійно надходить у них шляхом осмосу через клітинні мембрани. Таким організмам загрожує небезпека роздутися від проникаючої води. Тому надлишок води постійно виводиться. У прісноводних одноклітинних надлишок води виводиться за допомогою скоротливих вакуолей, у

епітеліальними клітинами, що
містяться в шкірі у земноводних і зябрах у риб. У риб і багатьох водних безхребетних зябра є основним органом осморегуляції, більш ефективним, ніж нирки.
Морські хрящові риби (акули, скати) теж
мають гіперосмотичну регуляцію. Їхній водний баланс забезпечується за рахунок накопичення в крові дуже високої концентрації сечовини.
Гіпоосмотична регуляція
Механізм осморегуляції називають гіпоосмотичним, якщо осмотичний тиск (концентрація солей) у рідинах організму менший, ніж у зовнішньому середовищі. Гіпоосмотична регуляція характерна для морських костистих риб, морських плазунів, морських ссавців.
Оскільки в тілі морських мешканців менше солей, ніж у навколишньому середовищі, вони постійно втрачають воду через покриви тіла, зябра та із сечею. Тому їм загрожує зне-
воднення. Для компенсації втрат води вони змушені весь час багато пити. Але ковтання морської води призводить до поглинання великої кількості солей. Над-
лишок більшості солей морські риби виводять нирками або через травний канал з екскрементами. Солі Натрію риби екскретують спеціальними клітинами зябрового апарату, а плазуни і морські птахи — клітинами со-

Згадайте
Роль транспірації в житті рослин
Рослинні екскрети
Рослини не синтезують білок у надлишку і тому виділяють дуже мало нітрогенвмісних відходів, які утворюються під час розщеплення білків. Три кінцеві продукти, які утворюються у ході обмінних процесів,— кисень, вуглекислий газ і вода — використовуються рослинами як вихідні речовини для інших реакцій. Єдиний газоподібний продукт, що
виділяється рослинами у великій кількості,— це кисень, що утворюється у ході фотосинтезу.
Продуктами виділення у рослин також є нектар, дубильні речовини, слиз, смоли,
ефірні олії, органічні кислоти, вітаміни, цукри, гормони, ферменти та інші речовини.
Кількість речовин, що виділяється рослиною, може становити до 30 % від маси сполук, утворених під час фотосинтезу.
Багато рослинних екскретів мають біологічне значення.
Солодкий нектар важливий для залучення комах-запилювачів. Ефірні олії зумовлюють запах, що відлякує травоїдних тварин (кмин, кропива тощо). Віск захищає поверхню органів і перешкоджає випаровуванню води. Смоли затягують механічні ушкодження і захищають рослину від

бутонів, старіння та опадання листків.
Видільні структури рослин
Виділення у рослин здійснюється клітинами листків і коренів, а також клітинами спеціальних видільних тканин (залозистими волосками, молочними судинами, нектарниками) (мал. 52.1). Речовини, що виділяються, можуть накопичуватися у вакуолях і клітинних стінках. Багато продуктів метаболізму рослин відкладається у змертвілих тканинах (деревина), а також у листках або корі, які рослини періодично скидають.
Гутація і транспірація Вода становить 80–95 % маси рослини. Основна маса води надходить у рослину з ґрунту. Всмоктуючись через корінь, вода переходить у тканини стебла і листків. Досягнувши листків,
За гарного освітлення відбувається фотоактивне відкриття продихів. На світлі в замикаючих клітинах продихів збільшується вміст цукрів і йонів Калію, що веде до підвищення осмотичного тиску і надходження води. Тургор клітин збільшується, і продихи відчиняються тим ширше, чим вищий рівень освітлення. Якщо ж транспірація
надто інтенсивна і перевищує поглинання води
коренем, тургорний тиск у замикаючих клітинах спадає, і продихи закриваються. У процесі еволюції в рослин сформувалися різні пристосування для зменшення транс-
пірації: восковий наліт на поверхні листків і плодів, занурення продихів у мезофіл, опушеність, редукція листкової поверхні. За нестачі води рослини можуть згортати або навіть утрачати листки. Чинники середовища також впливають на інтенсивність транспірації. Головним чинником, що регулює транспірацію, є світло. Під час максимальної освітленості спостерігається й максимальна інтенсивність транспірації.
Транспірація також залежить від вологості повітря, температури, вітру. Значно впливає на інтенсивність транспірації мінеральне живлення рослин. У разі нестачі Нітрогену,
Фосфору й Калію інтенсивність транспірації максимальна, а за збалансованого мінерального живлення транспірація різко зменшується. Гутація — процес виведення води у вигляді крапель рідини на поверхні рослини. Гутація відбувається через гідатоди — спеціальні водні

Мал. 52.2. Гутація
спричиняють ураження різних
органів. Знешкодження токсичних продуктів розпаду
• Гомеостаз
• Дисиміляція білків, вуглеводів, жирів
• Будова нирок та сечовидільних шляхів
Роль екскреції та осморегуляції
в підтриманні гомеостазу
Екскреція і осморегуляція є дуже важливими процесами життєдіяльності, вони підтримують сталість внутрішнього середовища
організму (гомеостаз). Їхня функція полягає в підтримці сталості складу й обсягу рідин внутрішнього середовища організму, насамперед крові.
Шляхом екскреції видаляються побічні продукти метаболізму, багато з яких є токсичними і негативно впливають на перебіг нормальних метаболічних реакцій.
Процеси екскреції й осморегуляції підтримують йонний склад рідин тіла за рахунок регуляції концентрації йонів Na+, K+, Mg2+, Ca2+, Fe2+, H+, Cl–, I–, PO3–4, HCO3–.
Процеси екскреції й осморегуляції підтримують постійну концентрацію йонів Гідрогену H+ (тобто підтримують кислотність середовища).
Шляхом осморегуляції контролюється вміст води в рідинах тіла.
марнотратно витрачати її на виведення амоніаку. Такі тварини використовують інші способи екскреції нітрогенвмісних продуктів. Головним нітрогенвмісним екскретом у ссавців є сечовина, яка утворюється в печінці з амоніаку і яка набагато менш токсична, ніж амоніак. В інших наземних тварин (комах, птахів) екскретом є сечова кислота та її
його концентрації призводить до
кислотності, погіршення самопочуття, головного болю, зниження уваги. Видалення понад 90 % вуглекислого газу забезпечують легені. Також через легені ви-
водяться інші леткі речовини, наприклад ви-
пари ефіру й хлороформу під час наркозу,
випари алкоголю в разі сп’яніння.
Рослини як кінцеві продукти обміну ви-
діляють не тільки вуглекислий газ і воду, а й кисень. Роль кисню в організмах двоїста.
Вільний, атомарний Оксиген і озон фактично є клітинними отрутами. В атмосфері чисто-
го кисню дихання рослин знижується, а за тривалої його дії рослина гине. Це пов’язано
з посиленням вільнорадикальних реакцій, пошкодженням мембран унаслідок окиснення їх ліпідів і, зрештою, з порушенням багатьох процесів обміну речовин.
Фактори, що порушують процес виділення у людини
• Спадкові та вроджені захворювання органів виділення. Спадкові дефекти нирок (нефропатії) можуть виникати в різних структурах видільної системи, наприклад у клубочковому апараті, ферментних систе-
мах і транспортних каналах ниркових ка-
нальців, спричиняти анатомічні аномалії
нирок і сечовидільних шляхів (мал. 53.1).
• Інфекційні захворювання. Ниркові ін-
фекції зазвичай спричиняють бактерії, які уражають ниркові лоханки або ниркову паренхіму. Трапляються також паразитарні та вірусні захворювання. Інфекція знижує активність роботи нирок.

• Інтоксикація. До ураження нирок можуть призвести отруєння алкоголем, важкими металами, отруйними речовинами
Практична робота
(або скористайтеся тими, що розміщено в
ному додатку).
2. Проаналізуйте їх, зверніть увагу на коректність, науковість та об’єктивність інформації, яка
міститься. 3. Сформулюйте висновок.
У результаті фотосинтезу рослини утворюють
• Метаболізм • Цикл трикарбонових кислот
• Біотехнології Згадайте
Взаємоперетворення між різними
класами органічних речовин
Обмін речовин в організмі людини відбувається не хаотично. Він інтегрований і тонко настроєний. Усі перетворення органічних речовин тісно пов’язані один з одним. Наприклад, у разі надмірного споживання жирів вони можуть використовуватися для утворення глюкози. Білки й вуглеводи можуть перетворюватися на ліпіди, а вуглеводи в деяких випадках можуть перетворюватися на білки.
Взаємоперетворення окремих класів речовин можливі завдяки циклу трикарбонових кислот, в якому сполучаються всі основні шляхи розпаду й синтезу речовин (мал. 54.1). Взаємоперетворення здійснюються через ключові метаболіти, які є спільною ланкою на шляхах розпаду або синтезу. До таких метаболітів належать піруват, ацетил-КоА, фосфогліцерат, метаболіти циклу Кребса. Вуглеводи в результаті гідролізу утворюють моносахариди (глюкозу), які здатні перетворюватися на тріози, зокрема піровиноградну кислоту, що надходить до циклу трикарбонових кислот. І, навпаки, тріози здатні утворити глюкозу. Білки в результаті гідролізу утворюють різні амінокислоти, які
дезамінування дають амоніак і кетокислоти. Кетокислоти надходять у
трикарбонових кислот. Навпаки, піровиноградна кислота, а також кетокислоти циклу трикарбонових кислот (
щавелевооцтова) перетворюються на амінокислоти, які організм використовує в процесі біосинтезу білків.
Глюкоза
Піруват
Ацетил-КоА Оцтова
Продукти гідролізу жирів — жирні кислоти — в результаті β-окиснення дають ацетил-КоА. Навпаки, тріози можуть дати гліцерин, а ацетил-КоА необхідний для синтезу
високомолекулярних жирних кислот. У результаті можна знову отримати жири.
Метаболічна інженерія
Одним з перспективних нових напрямків у біотехнології є метаболічна інженерія —
спрямована зміна клітинного метаболізму за допомогою введення, видалення або модифікації метаболічних шляхів з використанням
технології рекомбінантних ДНК. Завданням
метаболічної інженерії є створення в організмі метаболічних шляхів, які раніше в даному
організмі не існували або взагалі не існували
в природі.
Метаболічна інженерія здатна створювати біологічні системи, що вироблятимуть хімічні речовини, які важко й дорого одержувати традиційними способами хімічної індустрії. Такими речовинами можуть бути, наприклад, корисні білки з високим умістом незамінних амінокислот, їстівні вакцини, ан-
Лактат
титіла, нові полімери, що не засмічують навколишнє середовище.
Прикладами результатів метаболічної інженерії є створення бактерій-продуцентів етанолу (мал. 54.2), розгалужених спиртів, бурштинової кислоти, синтетичного
• Асиміляція і дисиміляція • Закони термодинаміки Згадайте
Єдність процесів обміну речовин і енергії
У клітинах одночасно відбуваються процеси енергетичного та пластичного обміну.
Вони пов’язані між собою потоками речовин і енергії (мал. 55.1). Головну роль у поєднанні анаболічних і катаболічних процесів відіграє АТФ.
Процеси анаболізму і катаболізму перебувають в організмі
у XIX–XX ст. термодинамі-
— науки про взаємоперетворення теплоти й енергії — стало можливо кількісно розраховувати перетворення енергії в біохімічних реакціях і передбачати їх напрямок.
Термодинаміка обміну речовин З точки зору термодинаміки, живі організми являють собою відкриті нерівноважні системи, оскільки вони обмінюються з навколишнім середовищем як енергією, так і речовиною, і при цьому перетворюють і те, й інше.
Припинення обміну речовин та потоку енергії для організмів означає втрату структурної організації і смерть. Експериментальним шляхом було встановлено, що до процесів, які відбуваються в біологічних системах, можна застосовувати
перший і другий закони термодинаміки. Сумарна кількість енергії, яку отримує живий організм з їжею за певний проміжок часу, дорівнює кількості енергії, що виділяється у вигляді тепла і міститься в продуктах виділення, та енергетичним витратам на роботу, що здійснюється.
Кількість теплоти, виділеної організмом, можна точно виміряти. Для цього організм
поміщають у спеціальну камеру, яка добре ізольована від середовища, тобто не відбувається обміну енергією з навколишнім середовищем (мал. 55.2). Експерименти, ви-
конані цим методом, довели, що кількість
енергії, яка надходить в організм, дорівнює енергії, що виділяється під час проведення
калориметрії.
Практична
участь у метаболізмі (фотоліз, гідроліз), терморегуляція (потовиділення, гутація), транспорт речовин
H+, Na+, K+, Cl– Утворення мембранного потенціалу для синтезу АТФ та передачі сигналів, у тому числі, нервового імпульсу
HCO3–, HPO42–, H2PO4–Забезпечення буферних властивостей системи тканин
Ca2+, PO43– Забезпечення міцності опорних структур тварин (кістки, мушлі молюсків)
Mg, Fe, Zn, Cu, Mn Утворення активного центру гормонів, ферментів, вітамінів, транспортних білків, пігментів фотосинтезу
Біополімери
Полімери Мономери Обов’язкові елементи
Білки Амінокислоти C, H, O, N, S
Полісахариди Моносахариди C, H, O
Каталітична, структурна, моторна, транспортна, регуляторна
Механічна, резервна, регуляторна Жири
Нуклеїнові
кислоти
Гліцерин і жирні кислоти C, H, O
Нуклеотиди
Мембранний транспорт
C, H, O, N, P

Резервна, термоізолююча, регуляторна, структурна
Інформаційна, регуляторна, каталітична
Пасивний транспорт:
А. Проста дифузія
1 — дифузія крізь фосфоліпідний бішар 2 — дифузія крізь білок-канал
Б. Полегшена дифузія крізь білок-переносник
3 — симпорт
4 — антипорт Активний транспорт: 5 — крізь білок-насос із підводом
• сапротрофне
симбіозом
• паразитичне — одержання

Вихідні
У ГМО-технологіях широко використовують ген медузи, який відповідає за синтез білка, що світиться під впливом ультрафіолету. Якщо такий ген увести до організму кози так, щоб синтезований ним білок


• Нуклеотиди • Реплікація • Транскрипція • Трансляція
Згадайте Центральна догма молекулярної біології
Френсіс Крік 1958 року запропонував
так звану центральну догму молекулярної
біології. Ця догма стверджувала, що потік інформації в живих організмах відбувається тільки в напрямку від ДНК до РНК, а потім до білків. Але після подальших досліджень догму було відредаговано, і в сучасному формулюванні вона має такий вигляд: потік інформації
організмів (під час реплікації, транскрипції і трансляції). Передачу інформації з РНК на РНК використовують деякі віруси. А передача інформації з
ротної транскрипції події відбуваються у зворотному порядку порівняно зі звичайною транскрипцією. Здійснює його також комплекс ферментів, головним з яких є фермент РНК-залежна ДНК-полімераза (її часто називають ревертазою або зворотною транскриптазою). Цей фермент будує ланцюжок ДНК за зразком ланцюжка РНК.
Принцип побудови нової молекули також
базується на явищі комплементарності, але відповідність у цьому випадку дещо інша порівняно з транскрипцією.

Мал. 56.2.
Ферменти, що забезпечують передачу спадкової інформації Функціонування нуклеїнових кислот
Транскрипція Зворотна транскрипція ДНК (зразок)
(будується)
(зразок)
(будується)
Уридиловий нуклеотид до складу ДНК
не входить, тому навпроти аденілового нуклеотиду РНК розташовується тимідиловий
нуклеотид у ланцюжку ДНК, а навпроти ури-
дилового — аденіловий. Особливо часто цей процес використовують віруси, у яких нуклеїновою кислотою є РНК. Вони проникають у клітини живих
організмів і там за допомогою ферменту ревертази зі своєї РНК утворюють ДНК. А вже
ця ДНК вбудовується в геном клітини й починає контролювати процеси, які в ній від-
буваються. Також ряд вірусів використовує
для розмноження в клітині явище реплікації
РНК без синтезу проміжної молекули ДНК. Одним із тих, хто відкрив явище зворотної транскрипції, був український учений С. М. Гершензон.
(цей фермент бере участь у процесі транскрипції). А ДНКзалежна ДНК-полімераза синтезує нові молекули ДНК під час реплікації.
Топоізомерази — це ферменти, які здатні змінювати топологію ДНК (її просторову будову) (мал. 56.2). Це дозволяє привести ділянку ДНК в стан, коли можлива робота інших ферментів.
Гелікази — це ферменти, які відповідають за розділення дволанцюгових молекул нуклеїнових кислот на одноланцюгові. Такий
яких структурах розташовані гени?
У прокаріотів вони зосереджені у великій кільцевій молекулі ДНК (це нуклеоїд або
бактеріальна хромосома). Крім того, вони є в невеликих кільцевих молекулах ДНК —
плазмідах.
В еукаріотів гени містяться в хромосомах ядра, мітохондріях і пластидах. Відповідно до місця розташування гени еукаріотів по-
діляють на ядерні, мітохондріальні та гени
пластид.
Усі гени мають однакову схему будови.
Вони складаються з кількох ділянок. Головною ділянкою будь-якого гена є та, яка
містить інформацію про будову молекули білка або РНК (продукту гена). Це кодуюча частина гена. Інші ділянки гена некодуючі. Вони не містять інформації про будову
молекул, синтез яких забезпечує ген, але відповідають за роботу гена. Некодуючими ділянками гена є промотор і термінатор. Промотор — це ділянка гена, яка позначає місце, де починається синтез РНК, термінатор — де закінчується синтез. Крім того, до складу гена входять регуляторні ділянки, які регулюють його роботу. Гени прокаріотів Гени прокаріотів мають відносно просту структуру.
еукаріотичних
синтез продукту гена.
Особливості геномів прокаріотів
Основна частина геному прокаріотів зосереджена в бактеріальній хромосомі. Це кільцева молекула ДНК, яка зазвичай в одному
місці прикріплюється до клітинної мембрани.
Крім цієї ДНК до складу геному еукаріотів
входять плазміди. Плазміди є маленькими
кільцевими молекулами ДНК, які розташо-
вані в цитоплазмі клітини.
Геном прокаріотів не містить або містить
дуже мало некодуючих ділянок ДНК.
Особливості геномів еукаріотів
Характерною рисою геномів еукаріотів є те, що більша частина їхньої ДНК представ-
лена некодуючими ділянками. Спочатку таку
ДНК назвали сміттєвою, бо думали, що вона
непотрібна. Але потім виявилося, що вона
може відігравати важливу роль у регуляції роботи геному та еволюційних процесах.
Проте остаточно роль некодуючих ділянок
ДНК ще не з’ясовано.
Геноми еукаріотів поділяються на дві великі частини — ядерну і позаядерну. Основна частина генів еукаріотів зосереджена в ядерній частині геному. Ядерна частина пред-
ставлена генами, які розташовані в хромосомах ядра клітини.
Позаядерна частина геному представлена ДНК мітохондрій і пластид. Ця ДНК має форму кільця, вона не пов’язана з білками і за своєю будовою дуже схожа на бактеріальну хромосому. Деякі еукаріоти (наприклад, дріжджі) можуть мати також у своїх клітинах плазміди.
переміщатися всередині геному. Ці гени не є структурними
геномі людини понад 20 000 генів. Але для життєдіяльності
промотором або регуляторними ділянками. Це дозволяє змінювати швидкість роботи генів або «вмикати» чи «вимикати» їх. Другий механізм — модифікація деяких нуклеотидів у ланцюжках ДНК. Якщо до них приєднується метильний радикал (СН3), то зчитування інформації з ділянки ДНК за таким нуклеотидом стає неможливим. Третій механізм — пакування певних ділянок ДНК за допомогою білків
розвитку генетики з давніх
Згадайте
• Біологічні науки
• Мінливість
• Гени
Генетика як наука
• Спадковість
• Мутації
Генетика (від грец. genetic — походження) — наука про спадковість і мінливість живих організмів. Цей термін було запропоновано англійським генетиком В. Бетсоном
1905 року. В основу генетики було покладено закономірності спадковості, які виявив Г. Мендель під час вивчення різних сортів і гібридів гороху в 1860-х роках. Народження генетики відносять до 1900 року, коли Х. де Фріз, К. Коренс і Є. Чермак повторно відкрили закон Г. Менделя, але розвиток генетики почався набагато раніше. Уже в давні часи люди помічали певні закономірності успадковування ознак і намагалися
сортів і порід. Тому перший період
розпочався
створення
і покращення існуючих порід свійських тварин, сортів культурних рослин, а також мікроорганізмів, які використовуються у фармацевтичній промисловості й медицині. Велике значення має генетика для медицини та ветеринарії, оскільки багато захворювань людини
й тварин є спадковими, і для їх діагностики, лікування та профілактики потрібні генетичні дослідження.
Спадковість і мінливість
Спадковість — це здатність живих орга-
нізмів передавати особинам наступного поко-
ління особливості своєї організації, а також характерні риси становлення цих особливостей у процесі розвитку. Прикладами спадко-
вості є рудий колір волосся, який діти отри-
мують від батьків, однакова кількість крил і особливості їхньої будови в різних поколінь мухи дрозофіли, однакове забарвлення яблук одного сорту.
свою організацію, а також набувати нових ознак у процесі індивідуального розвитку. Прикладами мінливості є поява
листків конюшини з чотирма лопатями, народження білої ворони у сірих батьків, несхожість рідних братів в одній родині.
Методи генетичних досліджень
Генетика використовує велику кількість методів для проведення досліджень, традиційними з яких є гібридологічний, генеа-
логічний, популяційно-статистичний, цитогенетичний, біохімічний і близнюковий.
Ці методи застосовуються вже багато років.
В останні роки найбільш поширеними
геномі. Полімеразна ланцюгова реакція (ПЛР) за
генів, секвенування тощо). Метод генетичних маркерів полягає в ідентифікації
хромосом або особин за допомогою
них лише їм сполучень нуклеотидів. Молекулярно-генетичні маркери (ДНК-маркери) є поліморфними (такими, що мають кілька варіантів) ознаками, виявленими методами молекулярної біології в нуклеотидній послідовності ДНК. Вони використовуються для порівняння різних груп (сортів, порід, штамів, видів, родів тощо) живих організмів. За допомогою цього методу можна встановити наявність певних генних мутацій у геномі, визначити набір генетичних маркерів, що є специфічним для певного біологічного виду або навіть окремого індивида.
Згадайте
• Генетика • Ген
• Алель
• Гаплоїдна клітина
• Диплоїдна клітина
Основні терміни і поняття генетики
Генетика, як і будь-яка наука, має свій понятійний апарат і систему позначень.
Ген — дискретна функціональна одиниця спадковості, за допомогою якої відбувається запис, зберігання та передача генетичної інформації в ряді поколінь, певна
ділянка молекули ДНК (або РНК у деяких
вірусів) розташована на певній ділянці (у певному локусі) хромосоми еукаріотів, у бактеріальній хромосомі чи плазміді
у прокаріотів або в молекулі нуклеїнової
кислоти вірусів.
Алель — один з можливих станів (варіантів) гена.
Алель дикого типу — алель, який поширений у природних популяціях певного виду і зумовлює розвиток ознак, що є характерними для цього виду.
Локус — місце розташування алелів певного гена на хромосомі.
— диплоїдна або поліплоїдна клітина (особина), гомологічні хромосо-
одну статеву хромосому.
Генотип — сукупність усіх генів
у різних реплікуючих структурах цитоплазми (пластидах, мітохондріях, плазмідах). Генотип — це спадкова основа організму, єдина система взаємодіючих генів, тому
нюється. Межі, в яких змінюються фенотипові прояви генотипу, називаються нормою реакції.
Гібридологічний аналіз та основні типи схрещувань Гібридологічний аналіз — це досліджен-
гато генів) схрещування. Під час вивчення успадкування, зчепленого зі статтю, часто використовують зворотне схрещування, коли ознака, яка вивчається, в першому варіанті схрещування є у самки, а в другому — у самця.
Генетична символіка Для запису систем схрещування та розв’язання генетичних задач у генетиці використовують спеціальну систему позначень і символів.
Якщо генів кілька, то вони в запису роз-
ташовуються в алфавітному порядку. Домі-
нантний алель завжди пишуть перед рецесивним алелем того ж гена.
Основні генетичні символи
Батьківський організм P
Гібриди першого покоління F1
Гібриди другого покоління F2
Гамети G
Знак схрещування ×
Материнська особина ♀
Батьківська особина ♂
Алель певного гена — латинські букви A, B, a, b
Алелі одного гена — однакові букви Aa, AA, Bb
Домінантні алелі — великі букви A, B, R
Рецесивні алелі — маленькі букви a, b, r
Генотипова формула особини Ab, aa, AaBb, AArr
Будь-який алель (домінантний чи рецесивний, якщо це не має значення) у генотиповій формулі












Мал.
Аналізуюче схрещування
досліджень генетики часто про-
яка визначається домінантним
Р. Білі пелюстки — рецесивна ознака, яка визначається рецесивним алелем р.
рослина, яку ми досліджуємо, має пурпурні пелюстки, то в неї може бути два різні генотипи, які забезпечують
— (наприклад, A–B–)
вони передають тільки
• Ген • Гібридизація
• Алель • Генотип
• Фенотип
досліджень
Основи сучасного гібридологічного методу створив Грегор Мендель (мал. 60.1). Він досліджував наслідування різних ознак гороху.
Провівши математичні підрахунки розподілу різних варіантів ознак у нащадків, Г. Мендель
зміг установити закономірності успадкування ознак і сформулював свої закони. Саме Г. Мен-
дель запропонував «задатки» ознак (гени) позначити літерами латинського алфавіту.
Закон чистоти гамет та цитологічна
основа законів Г. Менделя
У своїх дослідах Г. Мендель упевнився, що і батьківський, і материнський організми мають два варіанти (алеля) спадкового «задатку» (гена). І кожному зі своїх нащадків











групи нащадків за допомогою двокрапки. Наприклад, розщеплення за генотипом 1 (АА) : 2 (Аа) : 1 (аа) означає, що всіх нащадків можна поділити на 4 частини. З них одна частина
буде мати генотип АА,
і ще одна — генотип аа.
Закон однотипності гібридів першого
покоління
Нащадки
гібрида Під час схрещування гібридів першого
покоління між собою серед гібридів другого
покоління у певних співвідношеннях
з’являться особини з фенотипами вихідних
батьківських форм та гібридів першого
покоління (мал. 60.3).
У цьому випадку ми спостерігаємо у другому поколінні розщеплення за генотипом 1(BB) : 2(Bb) : 1(bb), а за фенотипом: 3 (фіолетові) : 1 (білі). Закон незалежного комбінування
AABB AABb AaBB AaBb
AABb AAbb AaBb Aabb
AaBB AaBb aaBB aaBb
AaBb Aabb aaBb aabb
ями ознак (мал. 60.4).
гому поколінні розщеплення
генотипом: 1(AABB) : 4(AaBb) : 2(AABb) : 2(AaBB) : 1(aaBB) : 2(aaBb) : 1(AAbb) : 2(Aabb) : 1(aabb), а за фенотипом: 9 (жовті гладенькі) : 3 (зелені гладенькі) : 3 (жовті зморшкуваті) : 1 (зелені зморшкуваті). Генотипи AABB, AaBb, AABb і AaBB визначають однаковий фенотип, тому що в них міститься хоча б по одному домінантному алелю обох генів. Який алель буде в іншій хромосомі в цьому випадку,
•
бути різним. Розрізняють повне домінування, неповне домінування і кодомінування.
Множинний алелізм Як ви вже знаєте, в організмі диплоїдних еукаріотів кожний ген, розташований в аутосомі, представлений у двох екземплярах. Також вам відомо, що можуть існувати різні варіанти генів, які називаються алелями. Зрозуміло, що













Приклади плейотропії
Організм Приклади плейотропії

Овес Забарвлення лусочки і довжина ості насінин визначається одним геном
Кішка Білі кішки з голубими очима мають схильність
ластовиння. Синдром Марфана виникає як результат порушення
домінувати. Так, ген С у кроликів відповідає за інтенсивність забарвлення шерсті (мал. 61.1). Один з його алелів (алель повного забарвлення) є
домінантним для всіх інших алелів і забезпечує рівномірне густе забарвлення всього тіла.
Другий алель (шиншилового забарвлення) є
рецесивним до першого алеля і домінантним
для інших алелів. Він забезпечує менш інтенсивне забарвлення шерсті по всьому тілу. Третій алель (гімалайського забарвлення) забезпечує світле забарвлення всього тіла з темними плямами на деяких ділянках (лапи, вуха тощо). Він є рецесивним до двох перших алелів і домінантним для наступного. Останній
ознакою. Приклади плейотропії можна побачити як у людини, так і в інших живих організмів.
Згадайте
• ДНК • Хромосома • Ядро
• Мітоз • Мейоз
Групи зчеплення
Після відкриття законів Г. Менделя в науці поступово почали накопичуватися факти
про те, що в деяких випадках розщеплення
ознак відбувається не так, як це передбачали.
Виявилося, що гени, які розташовані в одній
хромосомі, успадковуються разом (зчеплено).
Такі гени назвали зчепленими генами. А разом усі гени, які розташовані в одній хромо-
сомі, утворюють групу зчеплення. Кількість
груп зчеплення в організмів певного виду
дорівнює кількості хромосом в одинарному (гаплоїдному) наборі, який міститься у статевих клітинах. Наприклад, у дрозофіли їх 4, у кішки — 19, а в людини — 23.
Утворення гамет у разі
зчепленого успадкування
Прикладом зчепленого успадкування
генів може бути успадкування двох ознак у мушки дрозофіли — кольору тіла й форми крил. Чорний колір (а) і зачаткові крила (b)
визначаються рецесивними алелями, а сіре тіло (A) і довгі крила (B) — домінантними. Гени, які визначають ці ознаки, розташовані поряд в одній хромосомі. Що буде у випадку, якщо ми схрестимо самку дрозофіли, яка є рецесивною гомозиготою за цими ознаками (генотип
спадковості:
хромосоми.
• Гени розташовані в хромосомах у лінійній послідовності.
• Гени, які локалізовані в одній хромосомі, утворюють одну групу зчеплення і передаються нащадкам разом.
• Кількість груп зчеплення дорівнює гаплоїдному числу хромосом.
• Гаплоїдне число хромосом є постійним для кожного виду.
• Ознаки, які визначаються зчепленими генами, також успадковуються зчеплено.
• Між гомологічними хромосомами можуть відбуватися кросинговери й обмін ділянками.
• Частота кросинговеру прямо пропорційна відстані між генами.
Чорне
Батьки (P)
Така форма зумовлена тим, що в цей момент
кожна з хромосом складається з двох
однакових ниток (хроматид), які з’єднані
між собою в одній точці, що називається
центромерою, а частини хроматид від цієї
точки до їхніх кінців — плечами. У більшості еукаріотів кожна з хромосом
має парну їй гомологічну хромосому. Гомоло-
гічні хромосоми дублюють одна одну. У кож-
ній із хромосом такої пари є ділянки, які
кодують однакові гени.
Каріотип Сукупність усіх хромосом клітини нази-
вають каріотипом. Для кожного з видів еукаріотів властивий свій каріотип. Кількість, розмір і структура хромосом цього каріотипу є одним із критеріїв виду, який дозволяє
визначити належність особин до нього. Каріотип людини містить 23 пари хромосом.
Одна з цих пар — це статеві хромосоми (ХХ
у жінок і XY у чоловіків). Всі інші хромосо-
ми людини називають аутосомами.
Механізм кросинговеру
В експериментах Моргана та його співробітників під час вивчення успадкування
зчеплених ознак було виявлено, що серед гібридів дрозофіл є певна частина мух з перекомбінацією цих

Ви вже знаєте, що кросинговер
хромосомної теорії спадковості й механізму кросинговеру було створено генетичні карти хромосом. Генетичною картою хромосоми називають її графічне зображення з позначеним на ньому розташуванням генів. На карті позначають назви генів, відстані між генами та іноді

Згадайте
• Стать • Розмноження
• Хромосоми • Статеві хромосоми
Способи визначення статі
У живих організмів існує кілька способів визначення того, якої статі особина розів’ється із зиготи. Майбутню стать можуть
визначати зовнішні умови (якщо личинка черв’яка бонелії перебуває на дні океану, то з неї розвивається самка, а якщо на хобот-
ку самки — то самці), плоїдність організму (у бджіл і мурах гаплоїдні особини — самці,
а диплоїдні — самки) чи спеціальні статеві хромосоми, як у дрозофіл (інші хромосоми
в цьому випадку називають аутосомами).
Статеві хромосоми
Якщо організм визначає свою стать за
допомогою статевих хромосом, то він має
одну або дві такі хромосоми. Якщо статевих хромосом дві, то вони зазвичай відрізняються за розміром (одна велика, а інша маленька). А особини різної статі мають або
дві великі хромосоми (гомогаметна стать),
або одну велику й одну маленьку (гетерогаметна стать). Позначають такі хромосоми латинськими літерами. Наприклад, велику
хромосому можуть позначати літерою X, а малу — літерою Y. У різних



літерою — Z, генотип — ZZ), а гетерогаметною — жіноча
статі за допомогою статевих хромосом. У деяких
гемізиготи.
перебувати у стані
Гемізигота — це диплоїдна особина, яка має лише один алель певного гена. Цей стан
виникає внаслідок того, що особини однієї зі статей мають дві різні статеві хромосоми.
Наприклад, у людини в Х-хромосомі генів багато, а в Y-хромосомі мало. Через це на-
віть рецесивні алелі генів Х-хромосоми будуть проявлятися у фенотипі, бо немає другої
хромосоми з домінантним алелем.
Розглянемо особливості успадкування ге-
нів, зчеплених зі статтю, на прикладі ссавців. З генами, які розташовані в Y-хромосомі
самців, усе просто. Вони передаються напряму від самця до самця і в самок проявлятися не можуть. Вони завжди перебувають у стані
гемізиготи, бо в нормі ця хромосома в ядрі
клітини тільки одна. Успадкування генів, які розташовані на X-хромосомах, більш складне. В організмі са-
мок вони поводяться як звичайні гени ауто-
сом (нестатевих хромосом), бо X-хромосом тут дві. В організмі самців ці гени проявляють себе у стані гемізиготи. Тому ознаки, які визначаються рецесивними алелями
таких генів, проявляються у самців завжди.
А отримують вони їх від своїх матерів.
Успадкування, залежне від статі
Стать може суттєво впливати і на успад-
кування генів, які розташовані в аутосомах.
Такий тип успадкування має назву успад-
кування, залежне від статі. Можливі різні
варіанти прояву цього типу успадкування.
Наприклад, ознака може розвиватися тільки
У самців домінує алель цього гена, який відповідає за рогатість, а у самок, навпаки, домінантним є алель комолості. Таке явище виникає через те, що організм є складною системою і на прояв ознак впливає багато різних факторів, наприклад рівень гормонів у крові. У самців
• Спадковість • Мінливість
• Реалізація
різних процесів. Наприклад, у мухи дрозофіли (класичного об’єкта генетичних досліджень) забарвлення очей зумовлене наявністю в них двох пігментів — яскраво-червоного й коричневого. Для вироблення кожного з них має відбутися декілька біохімічних реакцій. Кожну з цих реакцій каталізує окремий фермент, який кодується окремим геном.
І порушення будь-якого з них позначається на забарвленні очей дрозофіли (мал. 64.1). Ознаки, які визначаються одним геном, називають моногенними. Але навіть вони можуть утворюватися внаслідок взаємодії. Ви
вже ознайомилися з цим явищем, коли розглядали поняття неповного домінування алелів. Відомо багато випадків, коли ознака або властивості організму визначаються двома або більше різними генами, які взаємодіють між собою. Але слід пам’ятати, що взаємодіють не самі гени, а молекули білків або РНК, утворення яких вони забезпечують. Під час



взаємодії неалельних генів відбувається відхилення від менделівських закономірностей розщеплення за фенотипом у нащадків. Розрізняють такі основні типи взаємодії генів: комплементарність,
Комплементарність






Батьки (P)

(F1)
Гібриди (F2)





12/16
пригнічує прояв домінантного алеля іншого гена. Відповідно, розрізняють домінантний і рецесивний епістаз. Наприклад, у собак домінантний алель гена A забезпечує чорне забарвлення, а рецесивний — коричневе.
А домінантний алель гена І узагалі блокує
синтез відповідних ферментів і спричиняє
появу палевого забарвлення. Тому особини
з генотипами A–іі будуть мати чорну шерсть,
з генотипами A–І– або aaІ– — палеву, а з генотипом aaіі — коричневу (мал. 64.3).
Полімерія
У разі полімерної взаємодії генів для прояву ознаки необхідна наявність хоча б одного домінантного алеля в будь-якого з кількох генів. Ці гени виконують одну функцію (наприклад, забезпечують синтез одного пігменту),
але можуть розташовуватися в різних хромосомах. Їх називають полімерними генами. Полімерні гени зазвичай визначають
кількісні ознаки (розмір, забарвлення тощо).
Діють вони, доповнюючи один одного, тому їх зазвичай позначають однаковими літера-
ми латинського алфавіту, додаючи нижній числовий індекс для того, щоб розрізняти
гени між собою. Наприклад, A1A1а2а2 або A1а1A2A2.


(F1)

(F2)




a1a1a2a2 Червоний A1a1A2a2 A1A1a2a2 a1a1A2A2

Згадайте
• Спадковість
• Мінливість
• Гени
• Хромосомна теорія спадковості
Різноманітність форм
мінливості ознак
Ви вже знаєте, що мінливість — це
властивість живих організмів змінюватися.
Ці зміни можуть відбуватися як із самим
організмом упродовж певного часу, так і зі
зміною поколінь у кожного з видів живих
організмів.
У генетиці виділяють дві основні форми мінливості — спадкову (генотипову) і неспадкову (модифікаційну, або фенотипову).
Зміни, які виникають у випадку спадкової мінливості, передаються нащадкам, а неспадкової — нащадкам не передаються.
Спадкова мінливість поділяється на ком-
бінативну й мутаційну. За комбінативної мінливості не змінюється структура ДНК. Відбувається лише перекомбінування алелів різних
генів. За мутаційної мінливості структура
ДНК може змінюватися. Такі зміни не завжди
пов’язані зі зміною послідовності нуклеотидів у межах гена. Зміни можуть відбуватися
Комбінативна
у генотипі. Ви вже добре знайомі з цим типом мінливості на прикладі законів Г. Менделя і взаємодії генів. В еукаріотів, які розмножуються статевим шляхом,
шому поколінні
представниками різних видів або сортів. Виділяють три основні форми гетерозису: репродуктивний (підвищується врожайність), соматичний (збільшуються лінійні розміри організму) і адаптивний (підвищується стійкість до дії чинників середовища).
Мінливість ознак бактерій
Комбінативна мінливість трапляється не тільки в еукаріотів, які здійснюють її під час статевого розмноження.
їхньої ДНК можуть поглинатися іншими бактеріями. Потім бактерії
вбудовують ці фрагменти у свою кільцеву молекулу ДНК.
Трансдукція — це перенесення бактеріальних генів з однієї клітини в іншу за
допомогою бактеріофага. Коли бактеріофаги
розмножуються в клітині, то в деякі з вірусних частинок потрапляє ДНК не вірусу, а бактерії. Вірусна частинка переносить цю
ДНК в іншу бактеріальну клітину, де вона вбудовується в бактеріальну хромосому.
За допомогою таких процесів бактерії
можуть, наприклад, обмінюватися генами стійкості до антибіотиків.
Мінливість вірусів
Мінливість у вірусів може бути як спадковою, так і неспадковою. Неспадкова мін-
ливість вірусів виникає, коли вірус покидає
клітину, в якій утворився, і захоплює части-
ну її клітинної мембрани, утворюючи свою
зовнішню оболонку. Різні ділянки мембрани
дещо відрізняються між собою, і тому різні
віріони також мають незначні відмінності. Ці
відмінності нащадкам не передаються.
Спадкова мінливість вірусів, як і інших
організмів, може бути мутаційною і комбі-
нативною. Мутаційна мінливість у вірусів є
наслідком мутацій. У вірусів немає таких репараційних систем, які виправляють пошкодження спадкового матеріалу, як у клітинах. Тому шанси на виникнення мутацій у них більші, ніж у клітинних організмів. Найбільший ризик виникнення мутацій у РНК-вірусів, бо РНК є менш стабільною, ніж ДНК, з точки зору збереження генетичної інформації. Комбінативна мінливість у
що стає причиною появи нових варіантів вірусу грипу (мал. 65.1).
та
і
форм дрозофіли 1. Розгляньте нормальні форми дрозофіли. Зверніть увагу на нормальні ознаки: сіре тіло, червоні очі, сформовані крила. Відрізніть самців від самок.
2. Розгляньте мутантні форми дрозофіли. Визначте, які
3.
Згадайте
• Мінливість
• Спадкова мінливість
• ДНК • Обмін речовин
Мутації
Мутацією (від латин. mutatio — зміна)
називають зміну ознаки, що зумовлена зміною спадкових структур, перебудовою генетичного апарату. Мутації змінюють генотип
особини. Вони виникають раптово й іноді
надають організму значних відмінностей від
вихідної форми.
Ученим такі зміни були відомі давно. Мутаційній мінливості присвятили свої роботи С. І. Коржинський і Г. де Фриз. Останньому належить термін «мутація». Крім того він сформулював основні положення теорії мутацій (1901–1903):
• Мутації виникають раптово як дискретні (перервні) зміни ознак.
• Нові форми є стійкими.
• На відміну від неспадкової мінливості, мутаційні ознаки не утворюють неперервних рядів і не зосереджуються навколо якогось середнього типу. Мутації є якісними змінами в організмах.
• Мутації проявляються по-різному. Вони можуть бути і шкідливими, і корисними.
• Вірогідність виявлення мутацій залежить від числа досліджуваних особин.
• Одні й ті самі мутації можуть виникати повторно. Молекулярна
репарацїї не
із
то виникає зміна ДНК, яка буде передаватися нащадкам. Виникне мутація. Слід зазначити, що в багатоклітинних організмах
очей, форма носа, вух, підборіддя тощо.
кілька варіантів класифікації мутацій:
• За типом прояву ознаки в гетерозиготі мутації поділяють на домінантні (проявляються у гетерозиготі) і рецесивні (не проявляються у гетерозиготі).
• За локалізацією в клітині розрізняють ядерні (змінюють гени, розташовані в ядрі клітини) і цитоплазматичні (змінюють гени, розташовані в цитоплазмі клітини, наприклад, у мітохондріях або пластидах) мутації.
• Залежно від причини виникнення виділяють спонтанні (причина виникнення не встановлена) та індуковані (причиною виникнення є дія встановленого фактору — фізичного, хімічного або біологічного) мутації. • Важливим є також те, у яких саме клі-






ганізації спадкового матеріалу, на якому відбувається мутація. Якщо мутація змінює лише
один ген (заміна, втрата чи додавання пари
нуклеотидів), це є прикладом генної мутації. У разі, коли зачіпається комплекс генів на хромосомі (заміна, втрата, додавання чи зміна місця розміщення ділянки хромосоми), це є прикладом хромосомної мутації. А коли зміни відбуваються на рівні геному (зміна кількості окремих хромосом чи всього хромосомного набору), це є прикладом геномної мутації. До геномних мутацій належать поліплоїдія і гетероплоїдія (анеуплоїдія). Поліплоїдія — це збільшення кількості хромосом шляхом додавання цілих хромосомних на-
борів у результаті порушення мейозу.
Гетероплоїдія — це зміна кількості хро-
мосом, що не є кратною гаплоїдному набору. Явище, коли яка-небудь із хромосом у генотипі має не дві, а три гомологічні хромосоми,
називаються трисомією. Трапляється і втрата однієї з гомологічних хромосом — моносомія. Мутагенні фактори
Фактори, які здатні індукувати мутаційний ефект, називають мутагенними. Установлено, що будь-які фактори зовнішнього і внутрішнього середовища, які можуть порушувати гомеостаз, здатні спричиняти мутації. Традиційно їх поділяють на фізичні (рентгенівське та інші випромінювання, ультразвук,
температура тощо), хімічні (хімічні сполуки) та біологічні (віруси, токсини) (мал. 66.1). Значну загрозу як мутагени для людини можуть становити шкідливі звички. І тютюнопаління, й алкоголь, і наркотичні речовини є досить сильними мутагенними факторами. Вони зумовлюють
Практична робота
Згадайте
• Мінливість
• Форми мінливості
• Спадковість
• Фактори середовища
Модифікаційна мінливість
Неспадкову мінливість іще називають фе-
нотиповою, або модифікаційною. Модифікації — це фенотипові зміни, які виникають
під впливом умов середовища. Модифікацій-
ні зміни ознаки не успадковуються, але її діапазон (норма реакції) генетично зумовлений і успадковується. Вони не спричиняють змін генотипу. Модифікаційна мінливість відповідає умовам існування, вона є пристосувальною (мал. 67.1).
Унаслідок цієї мінливості під дією на організм факторів навколишнього середовища
змінюється інтенсивність ферментативних реакцій або відбувається «включення» чи
«виключення» певних генів. Характерними рисами модифікаційної мінливості є такі:
• оборотність — зміни зникають за умови зникнення специфічних умов середовища, що спричинили появу модифікації;
• мають груповий характер;
• зміни у фенотипі не успадковуються;
• успадковується норма реакції генотипу;

• існує статистична закономірність варіаційних рядів;
• модифікації диференціюють фенотип, не змінюючи генотипу.
Прикладами модифікаційної мінливості є: • зміна маси тіла тварин у разі зміни кількості їжі; • зміна забарвлення хутра у зайця зимою; • зміна розміру окремих листків
Норма реакції визначається генетично. Для різних ознак


зубів у людини (якісні зміни).
Відповідно до цього, норма реакції може бути вузькою (якісні зміни — забарвлення
лялечок та імаго деяких метеликів) та широкою (кількісні зміни — розміри листків
рослин, розміри тіла комах залежно від харчування їхніх лялечок). Проте для деяких
кількісних змін характерна вузька норма реакції (жирність молока), а для деяких
якісних змін — широка (сезонні зміни забарвлення у песців).
Варіаційний ряд і варіаційна крива
Варіаційний ряд — це послідовність будь-яких чисел, розташованих за порядком зростання їхніх величин. Проміжок між
крайніми членами ряду називають інтерва-
лом варіювання, а довжину цього інтерва-
лу — розмахом.
Варіаційним рядом є і ранжирування
відображення прояву модифікаційної мінливості — ряд значень певного показника
або характеристики організму, розміщених за порядком зростання чи спадання кількісного вираження (довжини листка, зміни інтенсивності забарвлення хутра та ін.) (мал. 67.3).
Варіаційна крива є графічним відображенням прояву модифікаційної мінливості.
Вона
зустрічальності особин із середнім проявом ознаки.
Згадайте
• Вид • Популяція • Генетика • Еволюція
Популяції та їх характеристики Популяція — це сукупність особин одного виду, які відтворюють себе протягом
кількості поколінь і тривалий час
займають певну територію, функціонуючи і розвиваючись в одному або кількох угру-
пованнях живих організмів. Види живих організмів складаються із сукупності своїх
популяцій. У більшості видів нараховується кілька популяцій. Але існують і види, які мають тільки одну популяцію.
Кожній популяції властиві певні характеристики, за допомогою яких можна характеризувати її стан. Це щільність, розподіл особин за віком і статтю, характер розміщення в межах проживання, тип росту та інші.
Чисельність і щільність популяції
Чисельність популяції — це загальна кількість особин на певній території, які належать до однієї популяції. Для популяцій дрібних організмів (особливо водних) чисельність розраховують на певний об’єм (води,
ґрунту, повітря). Чисельність популяції з часом може змінюватися (мал. 68.1).
Якщо ми будемо рахувати не загальну кількість особин, а середню кількість на одиницю площі чи об’єму, то визначимо щільність популяції. Наприклад, чисельність



тичні процеси, які в
ся, вивчає популяційна генетика. Популяційна генетика пояснює процеси адаптації та
видоутворення через зміну частот алелів генів як наслідку еволюційних процесів. Вона вивчає те, як змінюються частоти алелів під
дією різних еволюційних факторів.
Популяційна генетика сформувалася
у 20–40-х роках XX століття. Вона стала
основою сучасної синтетичної теорії еволюції. Найбільший внесок у її розвиток зроби-
ли вчені Сьюал Райт, Рональд Фішер, Джон
Холдейн, Сергій Четвериков, Голфрі Харді (мал. 68.2), Вільгельм Вайнберг (мал. 68.3)
та інші.
Важливими методами, які сприяли розвитку популяційної генетики, стали методи
біохімії та молекулярної біології. У 60–70-х роках XX століття широке застосування
отримав метод білкового електрофорезу .
За допомогою цього методу вдалося встановити велике різноманіття форм білків, які кодувалися одним геном. Ці роботи стали основою нової еволюційної теорії нейтральності.
Дослідження різноманіття білків (особливо ізоферментів — різних форм одного ферменту) широко використовують і зараз. Але з кінця 1970-х років у генетиці популяцій для проведення досліджень почали широко використовувати ДНК-технології. І зараз ці методи є одними з найбільш популярних. Крім того, створення нових методів виділення ДНК з викопних решток дозволяє проводити аналіз навіть давно вимерлих популяцій і видів. Так, завдяки цим методам


2.
у досліджуваних рослин ознаки відмінності. Яка
Згадайте
• Еволюція
• Популяція
• Фактори еволюції
• Видоутворення
Фактори еволюції
Елементарні фактори еволюції — це явища та процеси, які змінюють генофонд популяції. Зміни в генофонді популяцій з часом можуть накопичуватися. Тому особини в популяції починають дедалі більше відрізнятися від своїх предків. Так і відбувається еволюція.
До факторів еволюції відносять мутації (мутаційний процес), популяційні хвилі (хвилі життя), дрейф генів, ізоляцію, міграцію і природний добір. Закон Харді — Вайнберга У тих умовах, коли ситуація в популяції живих організмів відносно стабільна, різні варіанти
Популяційні
хвилі (хвилі життя)
Дрейф
Коливання чисельності природних
популяцій, яке відбувається постійно
внаслідок кліматичних, біологічних
або інших факторів
генів Зміна частоти алелів певних генів через випадкові процеси. Наприклад, виверження вулкана, повінь або потрапляння невеликої групи особин на нову територію (ефект засновника)
в людини 23 пари хромосом, а у шимпанзе, як і у нашого спільного предка,— 24 пари
Періодично виникають спалахи розмноження комах (наприклад, сарани). При цьому тварини можуть поширюватися за межі території свого звичайного проживання
Коли люди потрапили на Американський континент, серед них випадково не виявилося людей з алелем, який відповідає за формування III і IV груп
Екологічне (симпатричне) видоутворення (мал. 69.2)
алелів одного гена описують формулою: p2 + 2pq + q2 = 1,
де p — це частота (у частках одиниці)
першого алеля гена, а q — частота другого алеля. Відповідно, p2 і q2 — частоти обох
типів гомозигот, 2pq — частота гетерозигот.
Зрозуміло, що в реальному природному середовищі досягнення цих умов повністю
неможливе. Але за умови достатньо близької ситуації (дуже мало мутацій, схрещування майже вільне, міграції майже немає) розрахунки за цією формулою дають цілком прий-
нятний результат. Якщо ж це співвідношен-
ня порушується, то це є сигналом про те, що відбуваються якісь еволюційні процеси і змінюється генофонд популяції.
Направленість елементарних процесів еволюції З еволюційних факторів тільки природний добір є направленим — він діє у пев-
напрямі, відбираючи більш




ненаправлені фактори виконують дуже
ливу роль. Вони забезпечують природний добір матеріалами для роботи. Способи видоутворення Існує кілька можливих способів утворення нового виду. Найважливішою умовою утворення
пуляцій.
способів видоутворення побудована саме на різниці
Генетика людини Генетика людини вивчає явища спадковості й мінливості у популяціях людей, особливості успадкування нормальних і патологічних
Згадайте
• Генетика • Геном людини
• Методи генетичних досліджень
Молекулярногенетичний
генетичного захворювання. Генеалогічний метод був
Молекулярно-генетичний метод досліджень спадковості
ці технології використовують у
До найбільш поширених молекулярно-генетичних технологій належать:
• секвенування ДНК (полягає у встановленні послідовності нуклеотидних основ на
певній ділянці ДНК);
• полімеразна ланцюгова реакція (використовує принцип комплементарності ДНК для збільшення її кількості у пробі);
• генетичні маркери (полягає в ідентифікації певних генів, ділянок ДНК, хромосом
або особин за допомогою притаманних лише їм сполучень нуклеотидів); • ДНК-мікрочіп (полягає в тому, що на спеціальній платі розташовується велика кількість зондів — невеликих молекул ДНК, з якими взаємодіють РНК, що наявні у досліджуваних клітинах)
Біохімічний Використовується для діагностики захворювань обміну речовин, причиною яких є зміна активності окремих ферментів. За допомогою біохімічних методів відкрито близько
кілька напрямів досліджень спадковості людини. Так, медична генетика зосереджена на дослідженнях спадкових захворювань і порівнянні успадкування й реалізації нормальних і патологічних ознак та залежності захворювань від генетичних факторів. А на межі генетики людини, біології людини й антро-
пології сформувалася антропогенетика. Цей
напрям досліджує процеси, які відбуваються
в сучасних та проходили в давніх популяціях людини, залучаючи дані популяційної
генетики людини, генетики поведінки, цито-
генетики, імуногенетики, антропології тощо.
Методи генетики людини
Дослідження генетики людини пов’язане
з великими труднощами. Причини — у не-
можливості експериментального схрещування, повільній зміні поколінь, малій кількості
потомків у кожній сім’ї. Крім того, на від-
міну від класичних об’єктів, що вивчаються у загальній генетиці, у людини складний каріотип, велика кількість груп зчеплення. Проте, незважаючи на всі ці труднощі, генетика людини успішно розвивається.
У вивченні генетики людини використовуються такі методи: генеалогічний, молекулярно-генетичний, біохімічний, популяційно-статистичний, цитогенетичний, метод
моделювання тощо.
Складання родоводів
Збирання даних починається з пробан-
да — особи, родовід якої необхідно скласти.
Ним може бути людина — носій якої-небудь
ознаки, або особа, яка звернулася за порадою
до лікаря-генетика. Зазвичай родовід складають за однією або кількома ознаками. Метод
зонтальному ряду за порядком народження (зліва направо). У межах одного покоління кожний член позначається арабськими цифрами. Кожний член родоводу може бути позначений відповідним шифром, наприклад II-5, III-7 (мал. 70.1).
Практична робота
Складання родоводів 1. Складіть схему родоводу певної родини (своєї або іншої), використовуючи генетичні символи.
2. Проаналізуйте родовід і визначте тип успадкування (домінантний
3. Сформулюйте висновок.
Згадайте
• Спадковість
• Генеалогія
Геномні та хромосомні
захворювання людини
Геномні й хромосомні захворювання людини зазвичай є дуже тяжкими й рідко бувають сумісними з життям. Так, під час утворення триплоїдної зиготи її розвиток розпочинається, але зародок гине на досить
• Мутації
• Генетика людини
Спадкові захворювання і вади
людини
Як і в інших живих організмів, генетичні порушення в організмі людини можуть від-
буватися на різних рівнях організації спад-
кового матеріалу, що і стає причиною спад-
кових захворювань. Відповідно, трапляються геномні, хромосомні й генні захворювання. На відміну від спадкових захворювань,
природжені вади виникають не в результаті
пошкодження ДНК. Природжені вади — це структурні порушення, які виникають до народження дитини і проявляються відразу або
через певний час після народження. Їх причиною є порушення процесу ембріогенезу під час внутрішньоутробного розвитку зародка. Причиною природжених вад може бути
дія біологічних, хімічних або фізичних факторів. Наприклад, захворювання вагітної жінки на краснуху може бути причиною глухоти у дитини, а дія снодійного талідоміду стала причиною народження дітей з нерозвиненими кінцівками.
мають. Але за умови подальшого збільшення кількості
хромосом виникають проблеми. Спадковими
ваннями є синдром Кляйнфельтера (генотип XXY) і синдром Шерешевського — Тернера (в геномі є лише одна X-хромосома). Прикладом хромосомного захворювання у людини є синдром Лежена,
одного
трьох
що відповідають за синтез білка опсину, який сприймає відповідний колір. Ген синього опсину розташований на хромосомі 7, а гени червоного й зеленого — на X-хромосомі. Призводить до втрати можливості сприймати відповідний колір Гемофілія Виникає внаслідок пошкодження одного з генів, що відповідають
мозку.
Генні захворювання людини
За допомогою сучасних методів досліджень уже відкрито близько 5000 молекулярних захворювань, які є наслідком прояву мутантних генів. Деякі з таких захворювань
поки що лікувати не вдається, але для деяких знайдено шляхи лікування.
Виявлення та профілактика
спадкових захворювань
Виявлення спадкових захворювань можливе декількома способами. Для цього можна
проводити аналіз каріотипу, що дозволить
виявити пошкодження хромосом або зміну їхньої кількості, або виконати біохімічні аналізи, які покажуть зміну активності ферментів або дефіцит чи надлишок певних речовин в організмі (наприклад, гормонів). Можна провести аналізи амніотичної рідини й виявити захворювання
спадкових захворювань. Зараз відомі сотні захворювань, у яких механізми біохімічних порушень вивчено досить докладно, але спадкові захворювання людини набагато простіше попередити, ніж вилікувати. Тому для їх попередження створено систему генетичного консультуван-
Приклади Хромосомна ДНК, плазміди, ДНКвіруси, мобільні генетичні
Назва
ДНК-залежні
ДНК-полімерази
ДНК-залежні
РНК-полімерази
Топоізомерази




Згадайте
• Властивості живих організмів
• Будова клітини
Віруси в системі органічного світу
Віруси є внутрішньоклітинними паразитами — вони розмножуються тільки в живих клітинах, використовуючи їхній ферментативний апарат.
У таксономії живої природи вірусів виділяють в окремий таксон неклітинних форм життя Vira . Основною відмінністю вірусів від клітин є відсутність обміну речовин і нездатність до самостійного розмноження. Поза клітиною віруси не виявляють ознак живого і поводяться як агрегати біомолекул. Позаклітинна форма вірусу нази-
вається віріон .
Утім віруси використовують цілком успішний спосіб відтворення. Подібно до всіх живих організмів, вони мають генетичний матеріал, який передають своїм численним копіям. Віруси можуть видозмінюватися


й еволюціонувати. Крім того, вони активно впливають на еволюцію живих організмів. Існування вірусів було відкрито 1892 року видатним ученим Д. Й. Івановським під час вивчення мозаїчної хвороби


Голівка
Вони уражають усі форми клітинних організмів, у тому числі тварин, рослини, бактерії та гриби. Серед вірусів тварин і людини існують збудники дуже небезпечних хвороб, таких, наприклад, як віспа, поліомієліт, сказ, вірусний гепатит, грип, СНІД тощо. Багато вірусів, до яких чутлива людина, уражає тварин, і навпаки. Крім того, деякі тварини є
переносниками вірусів людини.
Віруси тварин і людини можуть поширюватися:
• тваринами-переносниками (наприклад, вірус сказу);
• повітряно-крапельним шляхом під час
кашлю або чхання (вірус грипу);
• фекально-оральним шляхом під час контакту із зараженою їжею або водою (віруси, що спричиняють кишкові розлади);
• статевим шляхом і під час переливання зараженої крові (ВІЛ).
Віруси рослин завдають величезної шкоди сільськогосподарським культурам. Наприклад, вірус тютюнової мозаїки є причиною втрат не тільки тютюну, а й томатів (мал. 72.2), перців
порушення росту (карликовість), зморшкуватість і скручування листків, надмірну кущистість.
Віруси легко передаються від однієї рослини до іншої через контакт із соком хворих рослин (у разі травмування рослин, під час пікіровки розсади, пасинкування тощо), через насіння, а також комахами-переносниками.
Віруси бактерій — бактеріофаги — вибірково уражають бактеріальні клітини. Типова фагова частка складається з голівки та хвоста (мал. 72.3). У голівці міститься ДНК або РНК. На кінці хвоста
Згадайте
• Реплікація ДНК
• Зворотна транскрипція
Процеси життєдіяльності й розмноження вірусів
Як ви вже знаєте, віруси є внутрішньо-
клітинними паразитами, оскільки вони не здатні розмножуватися поза клітиною. Віруси використовують ресурси клітини-хазяїна для утворення своїх численних копій.
У вірусів розрізняють дві життєві форми: позаклітинну (віріон), що не виявляє ознак життєдіяльності, і внутрішньоклітинну, в стані якої вірус активно розмножується.
Поза організмом-хазяїном вірусні частинки деякий час не втрачають здатності

до зараження. Наприклад, вірус поліомієліту зберігає інфекційну активність протягом кількох діб, вірус віспи — декількох місяців. Віріони взагалі мають високу життєздатність, вони
навіть
дози радіації та високий тиск. Проте вони гинуть в ультрафіолетовому опроміненні, за умов високої температури, під впливом дезінфікуючих речовин. Але вірус гепатиту В зберігає
на поверхні Т-лімфоцита (мал. 73.1). Інші віруси, наприклад вірус тютюнової мозаїки, мають широкий спектр хазяїв.
2. Проникнення в клітину. Вірус переносить усередину клітини свій генетичний матеріал, а іноді й власні білки, які допомагають у реалізації його спадкової програми. Для проникнення в клітини тварин віруси використовують різні способи: деякі впорскують нуклеїнову кислоту через плазматичну мембрану, інші зливаються з клітинною мембраною, треті потрапляють у клітину шляхом ендоцитозу. Процес інфікування вірусами грибів і

Мал. 73.2. Інфікування бактеріальної

Мал. 73.3.
своєю оболонкою, а клітина продовжує жити і продукувати вірус. Деякі віруси вбудовують свій геном у хромосому клітини-хазяїна. Цей геном реплікується разом
з геномом клітини і не виявляє себе, доки певні чинники не спричинять його активацію (наприклад, вірус герпесу).
Особливості репродукції різних
груп вірусів
• ДНК-вмісні віруси (вірус тютюнової мозаїки, герпесу). Віруси прикріплюються до поверхні клітини, проникають усередину,
звільняються від капсиду. У клітинному ядрі ферменти клітини-хазяїна реплікують вірусну ДНК і транскрибують її в іРНК. Рибосоми клітини-хазяїна транслюють іРНК в білки вірусного капсиду (мал. 73.3). Вірус для виробництва власної РНК і ДНК використовує ферменти клітини-хазяїна.
• РНК-вмісні віруси (вірус кору). Реплікація зазвичай відбувається в цитоплазмі. Для копіювання своїх геномів РНК-віруси використовують власний фермент РНКрепліказу.
• Ретровіруси (ВІЛ). Містять одноланцюгову РНК і використовують власний
Згадайте
• Клітинний і гуморальний імунітет
• Вакцини
Інфекційний процес, викликаний вірусами
Кожний вірус має певну специфічну вибірковість хазяїв, що визначається типами клітин, які він може інфікувати.
У вірусних інфекцій є інкубаційний період, протягом якого симптоми захворювання відсутні. Зазвичай інкубаційний період три-
ває від декількох днів до декількох тижнів, але в деяких вірусів може тривати місяці або
навіть роки (ВІЛ).
Після інкубаційного періоду або одночас-
но з ним настає період поширення інфекції, під час якого заражений організм є джерелом вірусних частинок.
Далі настає власне період захворювання. Віруси спричиняють загибель заражених клітин, від чого страждає весь організм.

Вірусні інфекції можуть бути гострими (грип, віспа, сказ, лихоманка Ебола) і хронічними (гепатити B і C). Іноді віруси перебувають в організмі в стані спокою (віруси герпесу, оперізуючого лишаю). Час від часу відбуваються спалахи інфекційних захворювань (зокрема вірусних), під час яких фіксується незвично велика кількість хворих. Якщо спалах відбувається в окремому регіоні, його називають
ферментні системи, які руйнують одно- й дволанцюгові
знищуючи уражені та сусідні клітини. Ще одним видом антивірусного захисту є специфічні антитіла (гуморальний імунітет) — імуноглобуліни, які приєднуються до вірусу

цинації. Він здійснюється імунними клітинами: T-лімфоцити розпізнають вірусні
фрагменти, а Т-кілери руйнують уражені
клітини (клітинний імунітет).
Період стійкості набутого імунітету значно варіюється залежно від виду вірусної інфекції. До деяких інфекцій, наприклад кору, вітряної віспи, паротиту, краснухи, імунітет зазвичай зберігається протягом життя. Повторні захворювання трапляються рідко. Але імунітет до вірусу грипу зберігається
протягом кількох місяців. Повторне захворювання пояснюється тим, що вірус грипу швидко мутує. Його поверхневі гени постійно змінюються та з’являються нові штами
вірусу. З точки зору імунної системи, такі
нові інфекції.
Деякі віруси (в тому числі ВІЛ та віруси
гепатиту) уникають імунної відповіді та ви-
кликають хронічні хвороби. До того ж ВІЛ, потрапляючи в організм людини, вражає імунні клітини – Т-лімфоцити. Це знижує
стійкість імунітету до будь-яких інфекцій, у тому числі й до ВІЛ.
Профілактика і лікування вірусних інфекцій Ефективними методами боротьби з вірусними інфекціями є вакцинація і вживання
ДНК неактивні.
один спосіб профілактики вірусних захворювань — запобігання потраплянню вірусу в організм. Це можливо, якщо відомі шляхи поширення інфекції. Наприклад, для профілактики зараження грипом рекомендують не контактувати з носіями інфекції, уникати місць масового скупчення людей у періоди епідемії. Для профілактики вірусних кишкових інфекцій рекомендують мити руки та продукти харчування.
Згадайте
• Регресивна еволюція (дегенерація)
• Плазміди
• Внутрішньоклітинний ендосимбіоз
Гіпотези походження вірусів
Існує кілька гіпотез виникнення вірусів (мал. 75.1)
1. Гіпотеза регресивної еволюції. Віруси є нащадками стародавніх одноклітинних організмів, будова яких спростилася через паразитичний спосіб життя. Гіпотеза ґрунтується на існуванні складних, великих ДНКвірусів, геноми яких мають сотні генів (наприклад, вірус віспи, мал. 75.2). Вони могли бути внутрішньоклітинними паразитами і зазнати регресивної (дегенеративної) еволюції.
2. Гіпотеза виникнення з доклітинних форм життя. Віруси є нащадками стародавніх доклітинних форм життя, які перейшли до паразитичного способу існування. Гіпотеза ґрунтується на величезній різноманітності генетичного матеріалу вірусів: у якості нуклеїнових кислот вони мають як ДНК, так і РНК, що можуть бути одно- й дволанцю-

говими. Вважається, що до виникнення перших клітин як носії
3. Гіпотеза «оскаженілих генів».
схожості вірусів з мобільними генетичними елементами — плазмідами, транспозонами, віроїдами, F-факторами бактерій. Віруси«втікачі» стали відносно автономними, але певну залежність від клітин зберегли.
Певна річ, кожна з гіпотез має аргументи «за» і «проти». Найімовірніше, що віруси виникали різними шляхами і на різних етапах еволюції, а в подальшому
спільно зі своїми клітинами-хазяями.
Взаємодія вірус — хазяїн
Віруси взаємодіють
як харчовий ресурс і притулок. Іноді вірус має двох хазяїв: в одного виду він викликає тяжке захворювання, а іншому не завдає шкоди і «зберігається» в ньому. Наприклад, вірус сказу в природі зберігається в гризунах, віруси енцефаліту переносяться
кліщами.
Час від часу віруси змінюють хазяїв. Вважається, що натуральна віспа людини з’явилась у результаті еволюції віспи корів, а еволюція вірусу імунодефіциту зелених мавп призвела до виникнення ВІЛ.
Роль вірусів у виникненні ДНК-геномів
Існує гіпотеза про те, що віруси першими в еволюції використали ДНК для перенесення спадкової інформації. Ця
на припущенні, що спочатку всі
живі системи використовували тільки РНК
для збереження і реалізації спадкової інформації. Найдавніші віруси також були РНКвмісними. Але згодом вони змінили РНК на
ДНК, щоб уникнути дії захисних систем клітин, які знищували молекули вірусної РНК.
Відповідно, віруси «розробили» і ферментний
апарат для реплікації ДНК. Поступово в усіх живих системах здійснився перехід від РНКдо ДНК-геномів.
Віруси і горизонтальне перенесення генів В еволюції віруси є важливим «засобом»
перенесення генів, що забезпечує генетичне різноманіття організмів.
рисні «надбання»,
в клітинне ядро. Поступово цей вірус став основним сховищем інформації в клітинці, яка зберегла здатність до трансляції генів і життєздатності. На користь гіпотези свідчить те, що клітинне ядро і віруси мають дуже схожу будову: обидва являють собою хромосоми, укладені у білкову капсулу. У деяких порівняно простих організмах, таких як паразитичні червоні водорості, ядро може проникати з клітини в клітину. Цей процес дуже нагадує вірусне інфікування.
Згадайте
• Вторинна й третинна структури білка
• α-спіраль і β-структура
Пріони
Пріони — це інфекційні агенти, які є білками з аномальною третинною структурою. Вони не містять нуклеїнових кислот.
У певному сенсі, пріони подібні до вірусів, оскільки здатні збільшувати свою чисельність, тільки використовуючи ресурси клітини. Разом з тим для їх розмноження
не потрібні ДНК або РНК.
Пріонні білки тварин і людини утворюються з нормальних клітинних білків, які відповідають за оболонки нервових волокон. Просторова структура білків може аномально
змінюватися. Як правило, під час переходу білка з нормального стану в пріонний його α-спіралі перетворюються на β-структури (мал. 76.1). Унаслідок цього білок набуває
каталітичної активності й каталізує перетворення дедалі більшої кількості нових нор-


мальних білків на пріонні. Таким чином, запускається ланцюгова реакція
нормальну структуру й відмирають. У ссавців пріонні захворювання уражають нервову тканину, переважно головний мозок (мал. 76.2). Вони спричиняють невиліковні стани — губчасті енцефалопатії (коров’ячий сказ у великої рогатої худоби, скрейпі в овець), що призводять до смерті. У людини відомі такі пріонні захворювання, як хвороба Крейтцфельдта — Якоба і куру. За даними сучасних досліджень, основний шлях поширення пріонних захворювань — заражена їжа. Наприклад, уживання м’яса корів, уражених
симптомів.
причиною хвороби зле чаклунство. Але насправді інфікування відбувалося через канібалізм — аборигени практикували ритуальне поїдання мозку
померлих родичів. Вони вважали, що, з’ївши мозок
покійного, вони придбають його розум і силу. З викоріненням канібалізму куру практично зникла. За відкриття інфекційного характеру хвороби куру
Карлтон Гайдузек отримав Нобелівську премію
з фізіології та медицини 1976 року.
Віроїди Віроїди — інфекційні агенти, що складаються тільки з кільцевої молекули РНК. У віроїдів немає білкової оболонки. Віроїдна РНК дуже маленька — завдовжки лише кілька сотень нуклеотидів; вона не кодує білків.
Імовірно, копіювання віроїдної РНК здійснюється РНК-полімеразами клітини-хазяїна. Деякі віроїди реплікуються в клітинному ядрі, інші — у хлоропластах.
Віроїди спричиняють захворювання рослин, такі як карликовість хризантем, веретеноподібність бульб картоплі (мал. 76.3), плямистість авокадо тощо. Вони значно впливають на світове сільське господарство, спричиняючи захворювання економічно важливих культурних і декоративних рослин.
Зараження віроїдами відбувається під час
механічного пошкодження рослини. Усереди-
ні ураженої рослини віроїди переміщаються по клітинних контактах — плазмодесмах. Сьогодні ще не зовсім зрозумілий молекулярний механізм, що призводить до захворювання. Припускають, що віроїдна РНК

Мал. 76.3. Веретеноподібність бульб картоплі спричиняється віроїдами
видів РНК: вони переносять спадкову інформацію (іРНК, РНК ретровірусів), беруть участь у сплайсингу (мяРНК) і синтезі білка (тРНК, рРНК), мають каталітичну
(рибозими).
зберігання спадкової інформації в молекулі ДНК виник пізніше. На відміну
хімічно стабільніша і складається з двох комплементарних
Прокаріоти
Згадайте
• Будова бактеріальної клітини
• Реплікація ДНК
Бінарний поділ
Прокаріотичні клітини розмножуються
нестатевим шляхом. Розмноженню передує
подвоєння кільцевої молекули ДНК, яка
в прокаріотичній клітині існує у вигляді компактної структури — нуклеоїду, що прикріплений до мезосоми (впинання цитоплазматичної мембрани всередину клітини).
Реплікація кільцевої молекули ДНК бактерій починається з точки ініціації реплікації. Вона відбувається одночасно в протилежних напрямках. Через певний час після реплікації ДНК і розходження дочірніх хромосом клітина починає ділитися. У більшості випадків прокаріотичні клітини діляться навпіл з утворенням двох однакових за розміром дочірніх клітин, тому цей процес називають бінарним поділом (мал. 77.1).
В одних видів бактерій бінарний поділ відбувається шляхом формування перегородки, що зростає
не розходяться і
шаються пов’язаними між собою.
спричинює утворення клітинних скупчень різної форми. Наприклад, сферичні бактерії можуть утворювати пари (диплококи), ланцюжки (стрептококи) або грони (стафілококи) клітин. Різновидом бінарного
Мал. 77.3. Схема утворення спор у бактерій. Спора розвивається всередині клітини
кий бінарний поділ. Під час брунькування на одному з полюсів материнської клітини утворюється маленький виріст, який збільшується і згодом відокремлюється (мал. 77.2, в). У результаті брунькування утворюються дві
нерівноцінні клітини, що розрізняються за формою, розмірами та іншими ознаками.
Материнська клітина поступово старіє, а дочірня клітина, навпаки, активно добудовує клітинні структури і краще пристосовується
до мінливого середовища.
Утворення спор
За несприятливих умов паличкоподібні
бактерії здатні утворювати спори (мал. 77.3).
На поверхні бактеріальної клітини утворю-
ється щільна багатошарова оболонка, усі
життєві процеси в клітині припиняються.
Спороутворення не є розмноженням, тому що з кожної клітини формується одна спора
і число особин при цьому не збільшується.
У вигляді спори прокаріотична клітина витримує дію високих або низьких температур, отруйних речовин, зневоднення, зберігаючи
життєздатність протягом багатьох років. За
сприятливих умов оболонка спори руйнується, і процеси життєдіяльності відновлюються. Кон’югація
Мал. 77.4.
тині (мал. 77.4).
кон’югації
альна плазміда, яка називається F-фактором. Кон’югація відбувається за наявності двох типів клітин: донорів (F+), що володіють F-фактором, і реципієнтів (F–), що не мають його. F-фактор містить гени структур, за допомогою яких відбувається прикріплення клітини-донора до клітини-реципієнта. Потім між клітинами формується кон’югаційний місток, через який передається копія F-фактора, а також інші плазміди з цитоплазми донора. Після потрапляння F-фактора в реципієнтну клітинку вона стає F+. Кон’югація не є способом статевого розмноження, оскільки
Поміркуйте
Чим відрізняється генетичний матеріал еукаріотичних клітин від генетичного
Згадайте
• Будова клітинного ядра • Хромосоми
Генетичний матеріал в еукаріотичних клітинах Клітини еукаріотів відрізняються від
клітин прокаріотів більш складною будовою, насамперед наявністю таких клітинних структур, як ядро, розвинена мережа внутрішньоклітинних мембран, мітохондрії та пластиди. Еукаріотичне ядро містить велику кількість генетичного матеріалу, що представлений, як правило, кількома десятками молекул ДНК. Комплекси цих молекул ДНК з білками називають хромосомами. Набір хромосом у ядрі клітини, що характеризується їх числом, розміром і формою, називають каріотипом. Каріотип є видоспецифічною характеристикою, тобто різні біоло-
гічні види мають різні каріотипи (мал. 78.1).
Соматичні й статеві клітини Багатоклітинні еукаріотичні організми мають різні типи клітин, які спеціалізуються на виконанні різних функцій. Усі клітини поділяють на соматичні та статеві.


Статевими клітинами (гаметами) називають клітини, спеціалізовані на функції статевого розмноження. Вони містять половинний набір генетичного матеріалу і під час злиття одна з одною утворюють першу клітину нового організму.
Соматичними клітинами називають усі інші типи клітин, з яких будується тіло ор-
ганізму.
Число хромосом у соматичних клітинах особини або виду називають диплоїдним (подвійним) і позначають 2n. Так, у людини 2n = 46.
У статевих клітинах число хромосом називають гаплоїдним (одинарним) і позначають n. У людини n = 23 (мал. 78.2).
Непрямий поділ еукаріотичних клітин Процес поділу еукаріотичних клітин значно складніший порівняно з поділом прокаріотів. Еукаріотичні клітини розмножуються шляхом спеціально вироблених механізмів непрямого поділу — мітозу і мейозу.
Ускладнення генетичного апарату еукаріотів, наявність у
•
поділу або природної загибелі.
життєвому циклі виділяють дві великі стадії — інтерфаза і власне поділ (мал. 79.1).
Інтерфаза — період життєвого циклу
між двома послідовними поділами кліти-
ни. У цей час клітина росте і виконує свої функції в організмі. Одна з найважливіших подій інтерфази — реплікація (подвоєння)
ДНК перед поділом.
Поділ еукаріотичних клітин може відбуватися шляхом мітозу або мейозу.
Періоди інтерфази
1. Пресинтетичний період (G1). Клітина зростає і виконує свої функції в організмі. Збільшується кількість мембран і органел, синтезуються різні сполуки, запасається енергія. Клітини проводять нервові імпульси, скорочуються, секретують речовини тощо.
2. Синтетичний період (S). Розпочинається підготовка клітини до поділу. Відбувається одна з найважливіших подій інтерфази — реплікація (подвоєння) ДНК. Також подвоюються центросоми.
3. Постсинтетичний період (G2). Клітина завершує підготовку до поділу. Особливо інтенсивно синтезується АТФ, створюються нові мембрани й органели.
Тривалість інтерфази
Тривалість інтерфази і клітинного циклу варіює залежно від видової належності, типу клітин і відрізняється навіть у різних клітинах однієї і тієї ж тканини. У більшості клітин, що активно діляться, тривалість інтерфази
коротший, ніж етап підготовки до нього: мітоз становить близько 1/10 частини
клітинного циклу.
Регуляція інтерфази Існують складні механізми контролю клітинного циклу. Тривалість періоду G1 значною мірою визначається зовнішніми умовами і сигналами від інших клітин. Тривалість
періоду G2 регулюється розміром клітини.
У клітинному циклі існують так звані
контрольні точки. Це ключові етапи, на яких контролюється правильність процесів, що відбуваються, а також збереження генетичного матеріалу. Важлива контрольна
точка є на початку фази G1. Якщо умови сприятливі та клітина отримує від сусідніх клітин сигнали зростання й поділу, то вона починає підготовку до реплікації ДНК.
У фазі G2 є контрольна точка, яка затримує
клітини у цій фазі G2, якщо після реплікації виявилося пошкодження ДНК.
Перехід від одного періоду клітинного
циклу до іншого регулюється ферментом
циклінзалежною протеїнкіназою. Важливу роль у цьому процесі відіграє білок циклін.
Контрольні точки забезпечують правильність і високу точність процесів дуплікації
і розходження хромосом. Порушення контролю клітинного циклу можуть призводити до розвитку ракових захворювань.
Особливі клітинні цикли
Описані закономірності життєвого циклу
характерні для клітин, що часто діляться.
Однак існують клітини, життєвий цикл яких має інші особливості. Добре відомо, що клітини
конують свої численні функції. Вони можуть роками перебувати на стації G0, не вступаючи в період S. Однак у разі пошкодження або видалення частини печінки вони продовжують нормальний клітинний цикл — входять у S- і G2-періоди, а потім діляться. Клітини печінки, а також деякі інші клітини організму людини (наприклад, підшлункової залози) здатні й до іншого видозміненого життєвого циклу. Вони проходять G1- та S-періоди інтерфази,
Згадайте
• Будова молекули ДНК • Білки
• Хромосоми
Інтерфазний хроматин
Молекули ДНК в інтерфазному ядрі під світловим мікроскопом виглядають як безструктурне переплетіння ниток, що нази-
вають хроматином. Хроматин являє собою
комплекс ДНК і білків. Білки хроматину виконують структурну й регуляторну функції.
Структурні білки підтримують тривимірну
структуру молекули ДНК, стабілізують її та захищають від пошкоджень. Регуляторні
білки регулюють активність генів. Нитки ДНК у хроматині певним чином упаковані. Розрізняють більш щільні (гетерохроматин) і менш щільні (еухроматин) ділянки хроматину, що мають різну функціональну активність (мал. 80.1).


Мал. 80.2.

Нуклеосоми Елементарною одиницею упаковки хроматину є нуклеосома. Нуклеосома є
дібною частинкою, що складається з
гістонів, навколо якої обмотана двоспіральна ДНК (мал. 80.2).
Характеристики нуклеосом
• До складу нуклеосоми входить чотири пари гістонових білків Н2А, Н2В, Н3 і Н4 (всього вісім білків).
• Діаметр нуклеосомного диска становить 11 нм, а його товщина — 5,5 нм.
• ДНК робить 1,67 оберта (147 пар нуклеотидів) навколо нуклеосомного ядра.
• Нуклеосоми розташовані уздовж молекули ДНК на відстані 10–20 нм одна від одної.
• Ділянка ДНК між нуклеосомами називається лінкерною ДНК і становить 10–100 пар нуклеотидів.
• З лінкерною ДНК між двома сусідніми нуклеосомами зв’язується
спеціальних






Нуклеосомний
Соленоїдний рівень Скручування нуклеосомної
Петельний рівень Пакування хроматинових фібрил петлями
Доменний рівень Утворення петельних доменів, які своєю
спаковується в компактні
структури — хромосоми. Щільна упаковка
ДНК у хромосомах перешкоджає розривам
ниток ДНК у процесі поділу клітини . Іс-
декілька рівнів конденсації хроматину (мал. 80.3). Білки хроматину поділяються
• Будова клітини • Клітинний цикл
• Інтерфаза • Хроматин
• Хромосома Згадайте
Загальна схема і біологічне значення мітотичного поділу Мітотичний поділ
поділу еукаріотичних клітин, за якого ге-
нетичний матеріал рівномірно розподіляється між дочірніми клітинами. У результаті мітотичного поділу утворюються дві дочірні клітини, які є точною генетичною копією материнської клітини (мал. 81.1).
Отже, завданням мітотичного поділу є точне копіювання генетичної інформації і відтворення численних копій (клонів) вихідних клітин. Основними біологічними процесами, які реалізуються за рахунок мітотичного поділу, є ріст організмів, регенерація органів і тканин, а також нестатеве розмноження.
Підготовка клітини до мітозу На стадії S інтерфази відбувається реплікація ДНК. У результаті загальна кількість генетичного матеріалу в клітині подвоюється. Копії молекул ДНК, що утворилися під час реплікації, не відокремлюються одна від одної, а залишаються з’єднаними в ділянці центромери — так майбутні хромосоми набувають Х-подібної форми.
дій
клітинного ядра (мітоз, або каріокінез) і розподілу цитоплазми (цитокінез). Мітоз складається із чотирьох стадій
профази, метафази, анафази і телофази. Середня тривалість мітозу — 1–2 години. Найшвидше діляться ембріональні клітини. Так, дроблення яйцеклітини відбувається за 10–40 хвилин. Мітоз у рослинних клітинах триває 2–3 години, мітоз у клітинах тварин відбувається швидше — близько 30–60
Хромосоми
Ядерна
оболонка
Метафаза
Хроматиди Мікротрубочки
Анафаза
Нитки веретена поділу простягаються між полюсами клітини. Хромосоми шикуються на екваторі клітини, прикріплюються центромерами до ниток веретена, утворюючи метафазну пластинку. Тривалість: до 1 хвилини
Сестринські хроматиди
сестринські хроматиди стають
ядра. Формуються ядерця, деконденсується хроматин, зникає
Тривалість: 20–30 хвилин
Дочірні клітини
ніше) (мал. 81.2). Вони компактно розташо-
вані в ділянці екватора клітини і найбільш зручні для вивчення під світловим мікроскопом. Саме на метафазних мікропрепаратах
визначають каріотип.
Дізнайтеся більше Центромерні частини хромосом представлені гетерохроматиновими ділянками, що містять багаторазові повтори ДНК. Крім поєднання сестринських хроматид, центромера бере участь у формуванні
Практична робота
2.
3. Сформулюйте висновок.
Поміркуйте
Якими можуть бути порушення мітозу, якщо одна з хромосом втратить центромеру?
Дізнайтеся більше
Цитокінез можна блокувати штучно за допомогою
деяких хімічних речовин, наприклад
складаються, наприклад, міцелій багатьох грибів та волокна скелетної мускулатури.
Порушення процесу
нормальний перебіг мітозу
клітин (мал. 82.1).
У клітинах тварин і рослин цитокінез відбувається по-різному. У тваринній клітині виникає перетяжка плазматичної мембрани, що оперізує клітину по екватору. Утворена борозна поступово поглиблюється і, врештірешт, розділяє цитоплазми дочірніх клітин. У рослин у центрі клітини утворюється клітинна пластинка, яка розростається зсередини і зрештою повністю розділяє дочірні клітини. Такий спосіб розділення цитоплазми зумовлений наявністю жорсткої клітинної стінки рослин. У деяких місцях між рослинними клітинами зберігаються цитоплазматичні канали і формуються плазмодесми. Не завжди поділ ядра супроводжується поділом цитоплазми. У разі порушення цитокінезу формуються двоядерні або навіть багатоядерні клітини (симпласти). Із таких клітин
хромосоми розходяться
сів клітини нерівномірно, спостерігається анеуплоїдія — нестача або наявність зайвих хромосом у дочірніх клітинах. Часткова втрата генетичного матеріалу в ході мітозу можлива внаслідок фрагментації хромосом. Деякі хімічні речовини, віруси, йонізуюче випромінювання та інші чинники спричиняють розриви хромосом. Хромосомні фрагменти без центромерних ділянок не можуть прикріпитися до веретена поділу, не розподіляються до нових клітинних ядер і руйнуються в цитоплазмі.
У цілому порушення мітозу трапляються рідко і не перевищують 1 %, проте вони частішають з віком організму, у разі онкологічних захворювань, вірусних інфекцій, після радіоактивного опромінення.
Типи мітозу
Основна класифікація типів мітозу ґрунтується на стані ядерної оболонки в процесі поділу. За відкритого мітозу оболонка ядра
руйнується, і веретено поділу утворюється в цитоплазмі. За закритого мітозу руйнування ядерної оболонки не відбувається, а утворення веретена і мітоз відбуваються
всередині ядра.
Ще одна класифікація враховує симетрію веретена. За ортомітозу веретено симетричне щодо екватора клітини. За плевромітозу веретено складається з двох частин, які можуть розташовуватися під кутом одна до одної.
Для тварин і вищих рослин характерний відкритий ортомітоз. Еволюційно давнішим вважають закритий плевромітоз, наприклад, у дріжджових грибів (мал. 82.2).
Різновидом мітозу є ендомітоз, за якого хромосоми подвоюються, але поділ ядра і клітини не відбувається. У результаті в одному ядрі накопичуються численні копії хромосом. Якщо ці копії не розходяться, а залишаються зчепленими разом, утворюються гігантські політенні хромосоми (мал. 82.3).

Регуляція процесу мітозу У запуску початкових стадій мітозу (профази й метафази) активну участь бере циклін-кіназний комплекс (білки циклін-кіназа
руйнуються.
Поміркуйте
Мейоз
Мейоз
Хромосоми
ядерна оболонка та ядерце руйнуються, у цитоплазмі формується
рекомбінації генетичного матеріалу. Відбувається
Метафаза I
Фази мейозу II
Профаза II
Метафаза II
Анафаза II
Хроматиди
Телофаза II
Відбувається
конденсація хроматину. Ядерна оболонка і ядерце руйнуються. Формується веретено поділу
Хромосоми шикуються на екваторі
клітини і прикріплюються центромерами до ниток веретена поділу
Сестринські хроматиди відокремлюються одна від одної і рухаються
уздовж ниток
веретена поділу до
протилежних полюсів клітини
Хромосоми збираються на проти-
лежних полюсах
клітини. Їх число
гаплоїдне, вони
однохроматидні.
Деконденсується хроматин, формуються нові ядерні оболонки
Цитокінез
Після поділу цитоплазми виникають чотири дочірні гаплоїдні клітини. Кожна клітина має унікальну комбінацію генетичного матеріалу
й несуть унікальні комбінації генетичного матеріалу. Фази мейозу Перед мейозом, в інтерфазі, відбувається реплікація ДНК. Отже, кожна хромосома на початку мейозу складається з двох сестринських хроматид — двох точних копій. Кожний поділ мейозу поділяють на чотири фази — профазу, метафазу, анафазу і телофазу. Безпосередньо за першим поділом
проходить другий
Згадайте
• Кросинговер • Незалежне розходження хромосом
Біологічною функцією
є виробництво гамет — гаплоїдних клітин, спеціалізованих для статевого розмноження. Після
запліднення ядра гаплоїдних гамет (n) зливаються, утворюючи зиготу, і диплоїдний набір хромосом відновлюється (n + n = 2n).
Таким чином, мейоз від покоління до покоління підтримує сталість хромосомного набору виду під час статевого розмноження (мал. 84.1).
Процеси, що відбуваються в ході мейозу, є основою комбінативної мінливості організмів. Рекомбінація генетичного матеріалу в мейозі відбувається на двох етапах: у профазі I (кросинговер) та анафазі I (незалежне розходження гомологічних хромосом). Так досягається перекомбінування генів батьків, що збільшує генетичну мінливість серед нащадків.
Рекомбінація генетичного матеріалу під час мейозу й статевого розмноження виявилася вигідним еволюційним надбанням. Вона збільшує різноманітність організмів набагато ефективніше, ніж мутації, які рідко відбуваються і не завжди корисні. Як наслідок, зростає еволюційна стійкість біологічного виду до змін середовища. Переважна більшість сучасних організмів використовують цю перевагу
Гомологічні хромосоми
Нерівний кросинговер
Дуплікація Делеція


Мал. 84.3. Нерівний кросинговер
як у першому, так і в другому поділі мейозу. Нерозходження хромосом є причиною таких хромосомних захворювань людини, як синдром Дауна (зайва 21-ша хромосома), синдром Тернера (наявна тільки одна статева хромосома — Х), синдром Клайнфельтера (наявні три статеві хромосоми — XXY).
Ще одним порушенням мейозу є нерівний кросинговер у профазі I, який є результатом неправильної кон’югації гомологічних хромосом. У результаті нерівного кросинговеру виникають хромосоми з подвоєною або з відсутньою ділянкою. Гамети, що утворюються при цьому, є носіями хромосомних мутацій — дуплікацій або делецій (мал. 84.3). До блокування мейозу призводять порушення кон’югації хромосом під час профази I. Через це безплідними є багато між-
видових гібридів. У міжвидових гібридів
поєднуються хромосоми батьків, які не можуть попарно кон’югувати між собою з різних причин (у наборах батьків різне чис-
хромосом, хромосоми розрізняються за структурою, суттєво різняться алелі). Стерильними є міжвидові
і лошак (мал 84.4). Стерильність
63, що не здатні до кон’югації та подальших процесів мейозу. На кон’югацію хромосом впливають також великі хромосомні мутації, особливо інверсії та транслокації.
Порівняльна характеристика мітозу та мейозу. Складання аплікаційних схем мітозу й мейозу
1. Розгляньте схеми, малюнки, мікрофотографії фаз мітозу й мейозу.
3. Послідовно порівняйте події,
Згадайте
• Мітоз • Мейоз
• Клітинний цикл
Прямий поділ — амітоз 1841 року німецький біолог Роберт Ремак описав тип поділу клітини, якому 1882 року
німецький цитогенетик Вальтер Флеммінг
дав назву амітоз. Під час амітозу ядро інтерфазної соматичної клітини ділиться навпіл шляхом утворення перетяжки. У процесі
амітозу не відбувається конденсації хроматину й утворення хромосом, не формується веретено поділу, хромосоми випадковим чином розподіляються між дочірніми ядрами. Якщо не відбувається подальшого розподілу цитоплазми, клітина стає двоядерною, а після наступних амітозів — багатоядерною. Іноді амітоз завершується поділом цитоплазми. При цьому генетичний матеріал розподі-
ляється між дочірніми клітинами здебільшого нерівномірно.
До недавнього часу була поширена думка, що поділ шляхом амітозу притаманний переважно старіючим, пошкодженим або відмираючим клітинам організму, наприклад зародковим клітинам ссавців, клітинам пухлин. Іноді амітоз описувався у нормально функціонуючих клітин, наприклад у високоспеціалізованих багатоядерних



Поодинокі клітини
Морфологія клітини Зморщування клітини
Ядро Конденсація хроматину, розпад ядра на фрагменти
Лізис ядра
Клітинна мембрана Цілісність збережена Цілісність порушена
Органели
Мітохондрії, ЕПР, апарат Гольджі інтактні
Лізосоми Інтактні
Руйнування
Мітохондрії набухають, ЕПР і АГ фрагментуються
У клітині змінюється
цитоплазми, порушується вибіркова проникність клітинної мембрани, пригнічується робота мітохондрій. Ферменти, звільнені з лізосом,
пошкоджують внутрішньоклітинні структури. Клітина набухає, мембрана розривається і вміст клітини виходить назовні, що призводить до запалення. Апоптоз є запрограмованою загибеллю клітини і зумовлений реалізацією відповідної генетичної програми. Однією з основних функцій апоптозу є знищення дефектних
(пошкоджених, інфікованих) клітин. У дорослому організмі програмована загибель необхідна для заміни старіючих клітин на
молоді. Також апоптоз бере участь у процесах заміщення одних структур організму іншими у ході онтогенезу (мал. 85.2). Апоптоз запускається різними механізмами. Сигналами можуть бути, наприклад, зміна контактів з іншими клітинами, різка зміна обміну речовин, серйозне пошкоджен-
ня внутрішньоклітинних мембран, розриви у дволанцюговій ДНК. У відповідь на сигнал активуються спеціальні гени — «кілери», які запускають програму самоліквідації клітини. Під час апоптозу клітинне ядро розпадається на окремі фрагменти, клітина
Згадайте
• Генна терапія • Біотехнології
Клітинні культури Досягнення молекулярної та клітинної біології XX століття відкрили перспективи для створення принципово нових біоме-
дичних технологій. Одним з напрямків, що сьогодні бурхливо розвиваються, є клітинні технології, які ґрунтуються на застосуванні клітинних культур. Клітинні культури є клітинами певної тканини, які отримано від мікроорганізмів, рослин або тварин, що вирощуються в штучних умовах на поживному середовищі (мал. 86.1). Клітинні культури набули широкого застосування в різних галузях біології і медицини.
Галузі використання клітинних культур
• Наукові дослідження. Клітинні культури широко застосовуються в наукових дослідженнях як модельні об’єкти. На них


досліджують механізми клітинного поділу і диференціювання, взаємодію клітин із середовищем, процеси адаптації, старіння, злоякісної трансформації та ін. • Біотехнологія. У біотехнології клітинні культури використовуються для виробництва вакцин і біологічно активних речовин. Мікробіологічна промисловість сьогодні використовує тисячі штамів мікроорганізмів, що вирощуються в культурі. Вони синтезують антибіотики, інтерферон, гормони, ферменти, вітаміни, незамінні амінокислоти, кормові білки. Так, гриби і бактерії синтезують антибіотики (пеніцилін, стрептоміцин, еритроміцин тощо); сінна паличка — фермент амілазу; кишкова паличка — амінокислоти; пивні
рослинних клітин є джерелом токсинів,
біцидів, регуляторів росту, алкалоїдів.
тини тварин і людини продукують
(наприклад, клітини гіпофіза —
і соматотропін).
тики захворювань. • Медицина. Культури
вуються у діагностиці та лікуванні спадкових захворювань, регенерації та заміщенні клітин, тканин і органів (замісна




як трансплантаційний матеріал. Зокрема, клітини кісткового мозку використовують
для трансплантації під час терапії лейкозів і променевої хвороби. У хірургії для лікування великих опіків або хронічних виразок
для трансплантації широко використовують
епідерміс, вирощений поза організмом. Генна терапія (лікування спадкових захворювань). Клітини вилучають з організму
пацієнта, генетично модифікують, а потім
вводять назад в організм (мал. 86.2). Цей метод особливо корисний у лікуванні захворювань крові, оскільки клітини крові можна досить легко вилучити і ввести назад.
• Фармакологія. Культури клітин і тканин людини та тварин застосовують як тестсистеми для вивчення властивостей нових фармакологічних препаратів, а також для прогнозування безпеки їх застосування.
• Рослинництво. На основі клітинної культури можна розмножувати рослини (клональне мікророзмноження) або проводити їх селекцію в культурі.
Клітинна інженерія
Клітинна інженерія — це конструювання клітин
(ядра, цитоплазми, хромосом тощо). Зокрема, метод пересадки ядер соматичних клітин у яйцеклітини дозволяє зробити численні генетичні копії організму — клони. Цей же метод був використаний для створення «ембріона від трьох батьків» (мал. 86.3). Дана технологія розроблена для лікування мітохондріальних
Згадайте
• Розмноження • Тварини
• Рослини • Гриби
• Спадкова інформація
Репродукція живих організмів
Репродукція — це здатність живих орга-
нізмів до самовідтворення, утворення ними
нащадків, які є засобом збереження виду і забезпечують безперервність їхнього існування. Здатність до самовідтворення — це
одна з ключових ознак живого, яка відрізняє живі організми від неживих систем.
Репродукція живих організмів відбувається у формі розмноження, яке здійснюється у різні способи. Слід відзначити, що
здатність до репродукції мають не тільки
клітинні організми, але й такі неклітинні форми життя, як віруси.
Форми розмноження живих
організмів
Основних форм розмноження живих
організмів існує кілька. У першу чергу
розрізняють статеве (під час якого утворюються статеві клітини) і нестатеве (під час якого статеві клітини не утворюються)
розмноження.

Як окрему форму розмноження можуть розглядати вегетативне розмноження, виокремлюючи його з нестатевого. У такому випадку нестатевим вважають розмноження, під час якого утворюються спеціалізовані структури (спори, гемули тощо). А вегетативним вважають розмноження, під час якого такі структури не утворюються, а для розмноження використовуються звичайні соматичні органи (у
для клітинних форм. Суттєвою перевагою нестатевого розмноження є те, що в цьому варіанті продукувати нових нащадків
усі
тоді як у випадку статевого розмноження на це здатні тільки особини жіночої статі.
Статеве розмноження Статеве розмноження — тип розмноження, за якого утворюються спеціалізовані статеві клітини і відбувається статевий процес. Статеве розмноження спостерігається у представників більшості систематичних






значення різних способів розмноження живих організмів має як схожі, так і відмінні аспекти. Безумовно, будь-яке розмноження є засобом передачі спадкової
інформації наступним поколінням. Воно дозволяє зберігати генетичну інформацію виду тривалий час (для деяких видів — навіть десятки мільйонів років). Крім того, розмноження є засобом збільшення кількості особин виду, що дозволяє йому зберігати сталу зону існування, а за можливості, розширювати свій ареал.
Відмінні риси різних форм розмножен-
ня пов’язані з особливостями цих процесів. Якщо статеве розмноження забезпечує високий рівень мінливості нащадків (за рахунок комбінативної мінливості), то нестатеве розмноження вимагає набагато менших витрат ресурсів організму.


Часто процес репродукції
захворюваннями
ресурсів на розмноження. А от у ситуації, коли організм має значні шанси на виживання (наприклад, в умовах посухи для тих самих дерев), він, навпаки, може гальмувати репродукцію (дерева скидають квітки і плоди, на які їм не вистачає вологи).
Типи та способи розмноження організмів 1. Розгляньте малюнки із зображенням різних типів (статеве чи нестатеве) та способів (брунькування, поліембріонія тощо) розмноження
• Розмноження • Мітоз
• Спори • Бруньки
• Регенерація Згадайте Способи нестатевого
Нестатеве розмноження — утворення нового організму
материнського організму, в ході якого не утворюються статеві клітини і не
відбувається статевий процес. У цьому випадку в розмноженні бере участь тільки одна батьківська особина, що передає свою спадкову інформацію дочірнім організмам. Нестатеве розмноження трапляється у різних груп живих організмів і представлено декількома основними типами.
У разі простого поділу клітини утворюються дві дочірні клітини, удвічі дрібніші за
материнську. При цьому органели материнської клітини більш-менш рівномірно розподіляються між ними.
Під час множинного поділу спочатку багаторазово ділиться ядро материнської клітини, завдяки чому вона стає багатоядерною, а вже потім ділиться її цитоплазма й утворюється відповідна кількість дочірніх клітин. Здатність до поділу (фрагментації) у деяких видів тварин дуже значна.

тварин (наприклад, споровиків) формуються спори — утвори, оточені щільною оболонкою. Такого ж типу спори утворюють і деякі бактерії (відмінністю є те, що спори бактерій утворюються всередині клітини). Вони не є формою нестатевого розмноження, оскільки слугують лише
одів і поширення.
Клонування
Одним з способів нестатевого розмноження є клонування. Клонування — це отримання природним шляхом
нізму.
Для проведення клонування у таких складних організмів, як ссавці, було створено нову технологію. За цією технологією із соматичних клітин організму ссавця виділяють ядро і поміщають у цитоплазму яйцеклітини, ядро якої перед тим вилучають або руйнують. Цитоплазма клітини в цьому випадку стимулює поділи, і клітину, яка почала ділитися, поміщають у матку самки. Після чого вона вже розвивається нормальним для ссавців способом. Першим успішним клонуванням за такою
Фрагментація
Розділення тіла багатоклітинного організму на дві або більше частин, кожна з яких утворює нову особину. Як варіант фрагментації можна розглядати невпорядкований поділ, коли організм ділиться на кілька нерівних за розміром частин
Розмноження спорами Розмноження відбувається спорами — спеціалізованими клітинами, що утворюються в материнському організмі. Деякі спори мають джгутики, за допомогою яких вони здатні активно пересуватись у вологому середовищі
Розмноження
з утворенням спеціалізованих багатоклітинних структур Розмноження відбувається за допомогою спеціалізованих багатоклітинних структур, що утворюються в материнському організмі (гемули, статобласти тощо)
Види з короткими життєвими циклами завдяки цим формам розмноження за незначний проміжок часу можуть значно збільшувати свою чисельність. Крім того, за нестатевого або вегетативного розмноження нова
особина, зазвичай, розвивається швидше,
ніж за статевого. У результаті нестатевого розмноження
дочірні особини за набором спадкової інформації здебільшого є точними копіями батьків. Людина використовує цю особливість у розмноженні культурних рослин, підтримуючи з покоління до покоління властивості певних сортів.
(гідра, коралові поліпи) організмів (мал. 88.1)
Водорості, гриби, лишайники, плоскі й кільчасті черви, голкошкірі
Водорості, спорові рослини (мохи, хвощі, папороті), гриби
Лишайники, губки, мохуватки
Нестатеве розмноження — брунькування дріжджів 1. Розведіть у теплій воді невеликий шматочок дріжджів. Нанесіть піпеткою 1–2 краплі води з клітинами дріжджів на предметне скло.
рідини фільтрувальним
скопа. Серед дріжджових клітин знайдіть ті, що брунькуються.
Спеціалізовані
Згадайте
• Рослини
• Органи
• Гриби
• Живці
Вегетативне розмноження
Вегетативні органи рослин виконують функцію не лише живлення, але й вегетативного розмноження (мал. 89.1). Гриби також активно використовують фрагменти свого тіла (грибниці) для репродукції шляхом вегетативного розмноження (мал. 89.2).
Не в усіх рослин здатність до вегетативного розмноження розвинена одна ково добре. Крім того, навіть для одного виду
здатність до вегетативного розмноження у різних органів рослини буде відрізняти ся. Але цей спосіб репродукції








Живцями
заснований на регенераційних властивостях окремих органів рослин: пагонів, коренів, листків. Фрагмент вегетативного органа відокремлюється від материнської рослини і поміщається у водний розчин, де формує кореневу систему. Після її формування живець висаджують у ґрунт. Залежно від використаного вегетативного органа розрізняють листкові, кореневі й стеблові живці
Щепленням Метод заснований на відділенні
(прищепи)
середовища
ефективним або взагалі неможливим. Тому в багатьох рослин існують спеціальні пристосування певних органів для розмноження вегетативним шляхом.
Пристосування до вегетативного розмноження в природних умовах Вегетативне розмноження рослин у природних умовах часто здійснюється за допомогою спеціалізованих структур, які утворюються вегетативними органами рослини.
Пристосування до вегетативного розмноження в умовах агрокультури Вегетативне розмноження є гарним способом забезпечити репродукцію, коли є потреба в збереженні унікального сполучення генів у генотипі особини. Тому цей спосіб розмноження
Гриби вирощуються в агрокультурі на різноманітних
Фікус, фіалка, червона і чорна смородина, аґрус

і жіночих особин одного виду. Особини різної статі продукують у процесі розмноження різні типи гамет, що забезпечує збільшення генетичного різноманіття їхніх нащадків. Між собою особини різної статі різняться за первинними й вторинними статевими ознаками. Первинні статеві ознаки — це анатомо-морфологічні особливості організму, які
забезпечують утворення відповідних гамет і запліднення. До первинних статевих ознак відносять статеві залози, статеві провідні шляхи, зовнішні статеві органи. Вторинні статеві ознаки — це анатомо-морфологічні
особливості організму, що відіграють певну роль у процесах розвитку організму й регуляції фізіологічних процесів, які в особин різної статі відбуваються по-різному.
У тварин існує досить багато способів визначення статі майбутньої особини. Вона може визначатися як під впливом зовнішніх умов (наприклад, у крокодилів стать залежить від температури, за якої дозрівали
яйця), так і генетично (з допомогою статевих хромосом або іншим способом).
Статеве розмноження Статеве розмноження — тип розмноження, за якого утворюються спеціалізовані статеві клітини і відбувається статевий


кількість хромосом у клітині, що утворилася — зиготі,— збільшується у два рази, тобто відновлюється, причому одна половина всіх хромосом є батьківською, інша — материнською.
Живі організми утворюють статеві клітини двох типів: жіночі — яйцеклітини і чо-
ловічі — сперматозоїди (мал. 90.1). Згідно з Міжнародною гістологічною номенклатурою, термін «сперматозоїд» слід застосову-
вати лише для позначення рухливих чоловічих гамет, а як загальну назву чоловічих статевих клітин слід використовувати термін «сперматозоон». Різниця у будові жіночих і чоловічих статевих клітин є основою для одного з варіантів
класифікації типів статевого розмноження. У випадку оогамії особини чоловічої статі утворюють велику кількість дрібних гамет, які мають дуже обмежений запас поживних речовин, але здатні до руху. Особини жіночої статі утворюють відносно невелику кількість великих гамет, які мають значний запас поживних речовин, але не здатні рухатися. Така спеціалізація дозволяє, з одного
боку, забезпечити нащадків достатнім для розвитку запасом поживних речовин, а з іншого — ефективно здійснювати пошук гамет, сформованих особиною іншої статі.
Поліембріонія
Особливим способом розмноження орга-
нізмів, який виник на основі статевого способу розмноження, є поліембріонія.
Поліембріонія — це процес розвитку кіль-
й у рослин. При цьому в одній насінині розвивається
генетичного різноманіття нащадків внаслідок комбінації батьківських
Практична робота
Згадайте
• Розмноження рослин • Розмноження грибів
• Статеве розмноження
Гаметогенез у грибів
Процес утворення статевих клітин називають гаметогенезом. Гамети утворюються в статевих залозах або спеціалізованих клітинах.
Серед грибів гаметогенез властивий не всім групам. У хітридіомікотових та оомікотових, наприклад, гамети утворюються
в спеціальних спорангіях або гаметангіях (оогоніях та антеридіях). Гамети, що утворюються, можуть бути однаковими (при ізогамії) чи різними (при гетерогамії) за розміром. Серед них також поширений варіант, коли одна з гамет є великою й нерухомою, а інша — маленькою й рухливою (оогамія).
У базидіоміцетів (їхніми представниками є шапинкові гриби) та аскоміцетів (до них належать трюфелі, дріжджі та пеніцили) гаметогенез відсутній. У результаті статевого процесу в них утворюються мейоспори (мал. 91.1).

Мейоспори, які утворюють гриби, мають однаковий розмір. У базидіоміцетів формуються базидіоспори, які розташовані на спеціальній структурі — базидії. В аскоміцетів формуються аскоспори, які розташовані
починається зі злиття двох гаплоїдних ядер, які
тканині в результаті
утворюються численні клітини — сперматогонії (2n)
Росту Сперматогонії трохи збільшуються, і
кожної клітини розвивається сперматоцит І порядку, здатний до редукційного поділу
Дозрівання та форму-
вання
У процесі 1-го поділу мейозу утворюються
2 сперматоцити II порядку, а потім у 2-му поділі
4 гамети — сперматиди (n). Усі 4 клітини, однакові за розміром, дозрівають
і утворюють 4 сперматозоїди
Переходячи в зону росту, оогонії починають інтенсивно
шуватися в розмірах та накопичують
гляді зерен жовтка. Вони перетворюються на ооцити І порядку
Ооцит І порядку ділиться мейозом нерівномірно. Після 1-го поділу утвориться 1 велика клітина — ооцит II порядку, в яку переходять усі поживні речовини, і 1 дрібна клітина — первинне полярне або напрямне тільце, де є лише ядро й відсутня цитоплазма. Після 2-го поділу мейозу з ооцита II порядку утвориться знову
мегаспорогенез, у результаті якого утворюються макроспори). У процесі мікроспорогенезу з однієї диплоїдної клітини утворюється чотири гаплоїдні мікроспори. Кожна з них
ділиться мітотично й утворює пилкове зерно, яке містить два спермії. У процесі мегаспорогенезу з однієї диплоїдної клітини також утворюється чотири мегаспори. Але тільки одна з них утворює зародковий мішок. Інші три відмирають. Мегаспора тричі ділиться мітотично і утворює
вісім клітин. Одна з них стає яйцеклітиною, а дві зливаються і утворюють диплоїдну центральну клітину зародкового мішка.
Гаметогенез у ссавців Гаметогенез у тварин можна розглянути
на прикладі ссавців. У ссавців структурами, в яких відбувається гаметогенез, є їхні
відбувається послідовно у трьох зонах, які виділяють у залозах, і закінчується формуванням гамет (мал. 91.2). Розрізняють сперматогенез (процес утворення чоловічих статевих клітин) та овогенез (процес утворення жіночих статевих клітин).
Вивчення стадій гаметогенезу на постійних препаратах сім’яників та яєчників, таблицях,
Згадайте
• Тварини • Ссавці
• Розмноження • Статеві клітини
Статеві залози і статеві клітини
Статевими залозами у людини є яєчка (у чоловіків) і яєчники (у жінок). Яєчка — овальні парні статеві залози, що містяться поза черевною порожниною у шкірному
мішку (мошонці). Вони належать до залоз змішаної секреції: зовнішня функція — це утворення сперматозоїдів, а внутрішня — виділення гормону тестостерону. Під час статевого дозрівання у сім’яних каналах яєчок утворюються чоловічі статеві клітини — сперматозоїди.
Яєчники — це парні статеві залози мигдалеподібної форми. У них утворюються й дозрівають жіночі статеві клітини — яйцеклітини. Також яєчники утворюють статеві гормони, такі як естрадіол і прогестерон.
До черевної порожнини яєчники прикріплені
кількома зв’язками. Розмір яєчника становить 3 × 2 × 1 см, а важить він близько 7 г. Чоловічими статевими клітинами є спер-
матозоїди. Це рухливі клітини, які мають три
відділи — головку, шийку і хвіст. У хвості містяться спеціальні білки, які забезпечують рух сперматозоїда. А в шийці зосереджені
мітохондрії, що виробляють енергію, яка ви-
статевої
половина хромосом (23 замість 46).
Розрізняють чотири періоди сперматогенезу: розмноження, ріст, дозрівання й формування (мал. 91.2). У період розмноження сперматогонії (первинні чоловічі статеві клітини) кілька разів діляться шляхом мітозу. У період росту утворені клітини збільшуються в розмірах, а їхні ядра проходять першу фазу (профазу першого поділу) мейозу. У результаті вони стають сперматоцитами першого порядку. У період дозрівання проходять наступні фази мейозу, й утворюються сперматоцити другого порядку (після першо-
фазу менструального циклу починається ріст одного або кількох первинних фолікулів, але стадії повного дозрівання досягає зазвичай один фолікул; інші зазнають регресу. Процес дозрівання
фолікула за 28-денного менструального ци-
клу вкладається в 14 днів (за 21-денного — у 10–11 днів).
Розрізняють такі періоди овогенезу: роз-
множення, росту, дозрівання і формування.
У період розмноження відбувається збільшення кількості оогоніїв (первинних жіночих статевих клітин) шляхом мітотичних
поділів. У період росту поділ оогоніїв припиняється, і вони утворюють ооцити першого
порядку. Ооцити заглиблюються в тканини яєчника, вкриваються оболонками й утворюють фолікули. У кінці періоду росту в ооциті
відбувається накопичення жовтка. Протягом
періоду дозрівання відбувається два поділи
мейозу, в результаті яких у ядрі статевої клітини залишається половина хромосом (23 замість 46). Після першого поділу утворюються ооцит другого порядку й перше полярне тільце, а після другого — зріла яйцеклітина і друге полярне тільце. Полярні тільця не беруть участі у процесах розмноження і руйнуються. Таким
клітини утворюється лише одна повноцінна зріла гамета, але вона має великий розмір і достатньо поживних речовин для перших стадій ембріонального розвитку.
Вплив різних факторів
на гаметогенез Процес утворення гамет у людини залежить від генетичних, гормональних та інших факторів. Тип гаметогенезу у людини регулюється чотирма генами, три з яких ( O , T , Tif ) розташовані на Х-хромосомі,
Практична робота
Відмінність сперматогенезу та овогенезу у людини
1. Розгляньте схему розвитку сперматозоїдів і яйцеклітини людини.
2. Укажіть процеси, які відбуваються під час сперматогенезу й овогенезу, та представте їх
гляді таблиці.
3. Знайдіть
Згадайте
• Форми розмноження • Трансформація • Трансдукція • Кон’югація
Обмін генетичною інформацією до появи еукаріотів
Статеве розмноження є характерною рисою еукаріотів. Основна задача статевого
розмноження — забезпечення рекомбінації спадкової інформації. Але можливість обмінюватися генетичною інформацією виникла задовго до їхньої появи. До появи клітинних форм життя горизонтальний переніс генів скоріше за все був домінуючим способом передачі спадкової інформації. І лише після появи клітин передача інформації від предків до нащадків стала переважати. Але прокаріотичні форми життя продовжували обмінюватися спадковою інформацією між собою. Для цього вони використовували такі способи, як трансдукція (за допомогою фагів), трансформація (поглинаючи молекули ДНК із середовища) і кон’югація (обмінюючись ДНК через спеціальні вирости — пілі). Для обміну інформацією за допомогою кон’югації використовувалися невеликі кільцеві молекули ДНК — плазміди. З появою еукаріотів процеси обміну спад-
на рівні бактерій такий обмін вимагає суттєвих витрат ресурсів організму. А на рівні багатоклітинних організмів, які
розмноження, ситуація виглядає ще гіршою. Наявність особин двох статей означає, що нащадків буде залишати тільки одна з них — жіноча. Відповідно і нащадків буде вдвічі
доведеться чекати,
мутація не виникне незалежно.
Якщо дві особини мають по одній шкідливій мутації, то вже частина їхніх нащадків першого покоління буде мати обидві ці мутації у своєму геномі за
низькі шанси на виживання, що дозволить вилучити шкідливі



лія і крокодили. У бонелії стать залежить
від місця розвитку особини, а у крокодилів від температури середовища, в якому відбувається розвиток.
Більш складним стало визначення статі за
допомогою спеціальних генів, яке поступово стало причиною утворення статевих хромосом.
Такий варіант використовують ссавці (жіночі
хромосоми XX, а чоловічі XY) і метелики (жіночі хромосоми ZW, а чоловічі ZZ). Подальша еволюція цього механізму стала причиною
повної редукції меншої з хромосом і появою
варіантів X0 і Z0 в тих же групах тварин.
Випадки редукції статевого розмноження
Слід відмітити, що недоліки статевого
розмноження все одно становлять певну проблему для живих організмів. І в процесі еволюції неодноразово спостерігалася ситуація з редукцією такого способу розмноження. Де-
які види тварин повністю або частково пере-
ходили до партеногенезу (дафнії), у багатьох
рослин розвинувся апоміксис (нечуйвітер),
а багато представників грибів взагалі втратили
здатність до статевого розмноження (плісняві
гриби з груп аскоміцетів та базидіоміцетів). Але потреба в рекомбінації генетичного
Згадайте
• Статевий процес • Рекомбінація
• Комбінативна мінливість
Форми запліднення
Заплідненням називають процес з’єднання (злиття) зрілої чоловічої і жіночої статевих клітин, у результаті якого утворюється одна клітина (зигота), що є початком нового організму. Існує багато форм запліднення, на які його поділяють залежно від того, яку з характеристик процесу було обрано. Так, запліднення, ділять на штучне (здійснюється людиною)
та природнє (без участі людини). А залежно
від місця, де воно відбувається, розрізняють зовнішнє (поза організмом) і внутрішнє (в організмі) запліднення.







Запліднення у водоростей та спорових рослин У водоростей і спорових рослин запліднення відбувається шляхом злиття гамет тільки у водному середовищі. Тому для розмноження цим рослинам потрібна крапельно-рідка вода, навіть якщо вони ростуть на











У
голонасінних спермії не мають джгутиків. До жіночої шишки вони потрапляють з пилком, який переносить вітер. Після потрапляння пилка до шишки з нього виростає пилкова трубка, яка і транспортує безджгути-
кові спермії до місця розташування яйцеклітини. У процесі запліднення у голонасінних бере участь лише один спермій (мал. 94.1).
Подвійне запліднення у квіткових рослин
Квіткові рослини, як і голонасінні, є насінними рослинами. І після запліднення у них також утворюються насінини. Але процес запліднення квіткових є більш доскона-
лим. У них утворюються квітки і має місце
подвійне запліднення. Початок процесу у квіткових дуже схо-
жий на голонасінних. Пилок теж повинен
потрапити на іншу рослину (у перехреснозапильних видів). Але він потрапляє на спеціальну структуру — приймочку маточки, і там
вже проростає, утворюючи пилкову трубку. По цій трубці два спермії (як і у голонасінних) транспортуються до зародкового мішка, у якому один зі сперміїв зливається з яйцеклітиною, утворюючи зиготу (мал. 94.2). І тут уже починаються відмінності від процесу запліднення у голонасінних. У заплідненні бере участь другий спермій. Він зливається з центральною клітиною насінного
яка утворюється шляхом злиття
у тварин
тварин запліднення буває двох видів: зовнішнє
зовнішнього запліднення є те, що воно не потребує утворення в організмі спеціалізованих структур для введення сперми в тіло самки. Але шанси на зустріч яйцеклітини зі сперматозоїдом за такого варіанта запліднення є меншими.
Багато водних мешканців також використовують внутрішнє запліднення. І це не лише вторинноводні тварини (наприклад, кити), предки яких жили на суходолі
Партеногенез за своїми особливостями займає ніби проміжне положення між нестатевим і статевим способами розмноження. З
Згадайте
• Розмноження • Нестатеве розмноження
• Статеве розмноження
Партеногенез
Партеногенез — це розвиток нового організму з незаплідненої яйцеклітини. Як і у випадку поліембріонії, за партеногенезу
дочірні організми мають ідентичний з материнським набір спадкової інформації. Є організми, в яких партеногенез — єдиний спосіб розмноження (деякі комахи — палочники та прямокрилі). В інших видів, наприклад у ящірок, існують роздільностатеві та партеногенетичні популяції. У життєвому циклі
попелиць і дафній закономірно чергуються
покоління, які розмножуються статевим способом і партеногенетично (мал. 95.1).
У бджіл з незапліднених яєць шляхом партеногенезу утворюються самці, а із запліднених виходять самки.






метеликів, двокрилих тощо).
У деяких випадках личинки,
відігравати роль ендопаразитів і
материнську особу ще до свого вилуплення. Апоміксис Апоміксис — це спосіб розмноження без статевого процесу, але зі збереженими статевими органами.


Мал. 95.3. Рослина нечуйвітер розмножується шляхом апоміксису,
Апоміксис має дві найбільш поширені
партеногенез (який було докладно описано вище) і апогамію. Апогамія — це процес утворення зародка із клітин статевого
покоління (у квіткових із гаплоїдних клітин
зародкового мішка, у папоротей — із клітин
заростка). Ще одним варіантом апогамії є ад-
вентивна ембріонія, в процесі якої зародок розвивається із соматичних клітин. Зародок, який утворюється в результаті адвентивної
ембріонії, є диплоїдним та ідентичним за генотипом материнській особині.
Апоміксис поширений серед квіткових рослин (мал. 95.3). Його знайшли у представників більш ніж сорока родин квіткових. Шляхом апоміксису розмножуються цитрусові, папороті, злаки, айстрові та інші рослини.
Неотенія
Неотенія є способом розмноження деяких тварин, за якого вони мають можливість розмножуватися не в дорослому стані, а на стадії личинки. У цьому випадку в личинки до
стадії дорослої особини розвивається лише статева система, а всі інші системи залишаються незмінними. Неотенія трапляється у представників земноводних, комах, рако-
подібних, червів, Неотенія зазвичай має пристосувальне значення. Частіше за все це явище спосте-

Мал. 95.4. Аксолотль — личинка амбістоми, здатна
рігається в тих випадках, коли личинки
Практична робота
Форми розмноження організмів
1. Приготуйте мікропрепарат цвілевого
2.
Запліднення у людини Заплідненням у людини, як і
• Розмноження
• Оогамія
• Гамети
• Зигота Згадайте
інших живих організмів, називається процес з’єднання (злиття) зрілої чоловічої (сперматозоїд) і жіночої (яйцеклітина) статевих клітин, у результаті якого утворюється одна клітина (зигота), що є початком нового організму (мал. 96.1). Люди є представниками ссавців, і тому запліднення у них внутрішнє — воно відбувається в організмі жінки. У заплідненні
етапів. Причини порушення процесів запліднення у людини Причини порушення процесів
нення може бути пов’язане із проблемами в організмі як чоловіка, так і жінки. Проблеми в організмі чоловіка, які можуть бути причиною
• ендокринні порушення, які стають причиною загибелі сперматозоїдів або перешкоджають їх утворенню;
• інфекційні захворювання (паротит, бруцельоз, захворювання, які передаються статевим шляхом);
• утворення пухлин у яєчках (як доброякісних, так і злоякісних);
• розширення кровоносних судин у яєчках (варікоцеле), через яке температура
• вроджені аномалії розвитку статевих залоз;
• розлад сексуальних функцій (часто мають психологічні причини);
• запалення простати (різної природи);
• вплив зовнішніх фізичних або хімічних факторів, які пошкоджують клітини статевих залоз (радіаційне опромінення, токсичні сполуки тощо).
Проблеми в організмі жінки, які можуть бути причиною порушення процесів запліднення:
• ендокринні порушення, які стають причиною порушення розвитку і дозрівання яйцеклітин;
• порушення прохідності маткових труб після травм, абортів або інфекційних захворювань, що перешкоджає процесу запліднення;
• вроджені аномалії розвитку статевих залоз;
• гінекологічні захворювання;
• інфекційні захворювання (бруцельоз, захворювання, які передаються статевим шляхом);
• імунологічні порушення.
Особливості репродукції людини
Існування людини, як і будь-якого іншого
біологічного виду, є можливим тільки у ви-
падку, коли буде відбуватися процес репродукції (розмноження) з появою особин нових
поколінь. Репродукція у людини є складним
процесом, на який може впливати велика
кількість факторів. Ці фактори можуть бути
небіологічними (фізичні фактори, токсичні
речовини тощо), біологічними (захворювання, травми, порушення обміну речовин) або соціальними.
Соціальна складова відіграє у репродукції
запліднення,
сунків);
• механічні (бар’єрні) методи (не допускають контакту сперматозоїдів та яйцеклітини шляхом створення механічного бар’єру за
помогою презерватива, діафрагми, маточного ковпачка тощо);
• гормональні методи (шляхом прийому гормональних препаратів перешкоджають процесу овуляції або закріпленню заплідненої яйцеклітини в матці);
• хімічні методи (за допомогою спеціальних препаратів перешкоджають потраплянню сперматозоїдів у матку);
• внутрішньоматкові засоби (розміщені в матці засоби шляхом механічної та хімічної дії перешкоджають закріпленню яйцеклітини);
• хірургічні методи (шляхом хірургічної операції роблять процес запліднення неможливим).
Поміркуйте
у людини?
• Стать • Статеві хромосоми
• Статеві залози • Статеві гормони
• Первинні та вторинні статеві ознаки Згадайте
Механізми визначення статі
Як ви вже знаєте, у людини головну роль у визначенні статі майбутньої особини
відіграють статеві хромосоми. Наша спадко-
ва інформація зосереджена головним чином у ядрі клітин нашого тіла і представлена там у вигляді 23 пар хромосом (кожна хромо-
сома представлена двома екземплярами) —
спеціальних тілець, до складу яких входять білки та ДНК. Тобто всього кожна клітина нашого організму містить 46 хромосом. Лише в гаметах хромосом не 46, а 23. У них кожна хромосома представлена лише в одному екземплярі. 22 пари хромосом у чоловіків і жінок однакові. Ці хромосоми називають аутосомами. А от хромосоми останньої пари у чоловіків і жінок відрізняються (це так звані статеві хромосоми
Матка • Вульва
Х-хромосомами, а у чоловіків є одна велика Х-хромосома й одна маленька Y-хромосома. Маленька Y-хромосома містить мало спадкової інформації, але виконує
(мал. 97.1). Втім,
складною системою, і формування первинних та вторинних статевих ознак, а також статевої ідентичності, відбувається на кількох рівнях. Важливу роль тут відіграє робота гормональної системи і вища нервова діяльність. Гермафродитизм у людини Гермафродитизмом називають наявність в однієї особини і чоловічих, і жіночих статевих залоз. У більшості випадків таке явище є характерним для безхребетних тварин, а у хребетних трапляється рідко (найчастіше у риб). У ссавців гермафродитизм виникає
внаслідок певних спадкових аномалій або порушення розвитку.
У людини розрізняють два види герма-
фродитизму — істинний та хибний. Загальна частота гермафродитизму — приблизно 1 ви-
падок на 2000 народжень. Але майже всі вони належать до хибного гермафродитизму. Істин-
ний гермафродитизм трапляється дуже рідко.
У разі істинного гермафродитизму в людини формуються і чоловіча і жіноча статеві залози, які здатні виробляти гамети, а в будові статевих органів є як жіночі, так і чоловічі риси. Такий варіант можливий, наприклад, у випадку мозаїцизму, коли одна частина клітин організму має хромосоми ХХ, а інша — XY.
У випадку хибного гермафродитизму статеві залози сформовані правильно за жіночим або чоловічим типом. Але статеві органи несуть ознаки обох статей. Це може бути наслідком дисбалансу статевих гормонів. Ґендер у людини Ґендер — це соціально-біологічна характеристика, через яку визначаються по-
Мал. 97.1.
няття «чоловік» і «жінка», психосоціальні та соціокультурні ролі чоловіка й жінки як особистостей, а також психолого-біологічні особливості, на які впливає стать. Фактично ґендер є соціальним конструктором, який визначає соціальну стать людини. Термін ґендер запропонував американський психоаналітик Роберт Столлер у кінці 1960-х років. На відміну від біологічної статі, ґендер є набором соціальних самоідентифікацій, які можуть як збігатися з біологічними особливостями людини,
У наземних рослин різноманітність варіантів онтогенезу не така велика. Найбільшою наземною групою рослин є квіткові рослини. У них виділяють чотири основні періоди онтогенезу: латентний, прегенеративний,
• Розвиток
• Характерні риси тварин
• Характерні риси рослин Згадайте
Періоди
вам відомо,
рослин
це індивіду-
розвиток організму від моменту його зародження (статевим чи нестатевим способом) до смерті. Онтогенез поділяють на кілька періодів. Хоча загальна послідовність подій в онтогенезі живих організмів є схожою, ці періоди відрізняються для різних систематичних груп. Так, дуже різноманітними є варіанти онтогенезу у водоростей. У них часто трапляються складні життєві цикли.
(ембріогенез) триває від моменту
Гриф-індичка
кит
Максимальна тривалість життя залежить від багатьох чинників. Це і певні генетичні параметри, і
(виверження
Практична робота
розвитку
терфази майже відсутній, тому клітини, що утворюються,— бластомери — мають дедалі меншу кількість цитоплазми порівняно з яйцеклітиною. Через високу швидкість дроблення синтез білка не відбувається,
Згадайте
• Зигота
Ембріон • Органели клітини
Ембріогенез. Зигота і дроблення У спорових рослин формування організму починається від моменту проростання спори без утворення зародка. У насінних рослин за-
родок формується під час утворення насінини.
Після цього він певний час перебуває у стані спокою до початку проростання (мал. 99.1). У багатоклітинних тварин розвиток зародка починається від моменту запліднення.
Після проникнення сперматозоїда в яйцеклітину і злиття їхніх ядер утворюється одноклітинний зародок — зигота,— яка починає ділитися. Подальші напрями поділу зиготи й особливості розвитку зародка значною мірою визначаються особливостями цитоплазми яйцеклітини, у певних зонах якої накопичуються відповідні комплекси білків та РНК (явище ооплазматичної сегрегації). Ряд послідовних мітотичних поділів зиготи називають дробленням (мал. 99.2). Під час дроблення передсинтетичний період ін-
(ссавці, плоскі черви), піддаються повному дробленню
Розрізняють рівномірне та нерівномірне
лення. За рівномірного дроблення бластомери однакові. За нерівномірного дроблення бластомери відрізняються за формою і розмірами.
Ооплазматична сегрегація та презумптивні зони Як було вказано вище, однакові зовні бластомери у складі бластули вже мають певну спеціалізацію, залежно
Рівномірне
Повне
Дроблення
Нерівномірне
Неповне
Целобластула (ланцетник)
Бластоциста (ссавці)
Амфібластула (амфібії)
Дискобластула (птахи)
Мал. 99.2. Формування типів бластул хордових тварин
й утворення
генетично ідентичні дочірні ядра виявляються оточеними частинами цитоплазми з різних презумптивних зон. Взаємодія генетичного матеріалу ядер з регуляторними речовинами відповідних зон цитоплазми запускає відповідні механізми регуляції активності ядерних генів. Це стає причиною формування спеціалізації зовні ідентичних бластомерів.
Тотипотентність бластомерів
Характерною рисою бластомерів, які утворюються в результаті дроблення, є їх тотипотентність. Тотипотентність — це здатність клітин багатоклітинного організму давати початок новому окремому організму.
Тотипотентними часто є клітини рослин.
Тому отримати культуру тканин рослини не дуже складно. А от з клітинами тварин складніше. Більшість клітин тварин надто спеціалізовані й не можуть дати початок новому
організму. Але тотипотентність притаманна бластомерам зародка тварин. Отже, з бластомерів тварин можна утворювати нові організми. Саме ця властивість є основою утворення монозиготних близнюків. У




тварин формуються різні типи бластул (мал. 99.2)
Практична робота
Вивчення
2. Вивчіть
мікропрепаратах, муляжах, схематичних малюнках стадії ембріогенезу
3.
4. Сформулюйте висновок.
Згадайте
• Дроблення • Бластула • Гаструла • Систематичні групи тварин
Гаструляція Наступна після утворення бластули стадія ембріонального розвитку називається гаструляцією, а зародок на цій стадії — гаструлою.
Гаструла в більшості багатоклітинних тварин формується під час вгинання (інвагінації) частини стінки бластули всередину бластоцелі. Іншими способами утворення гаструли є імміграція, епіболія та деламінація. У випадку імміграції деякі клітини бластули мігрують у бластоцель і утворюють внутрішній шар клітин. Утворення гаструли шляхом імміграції поширено серед представників губок та кишковопорожнинних. Трапляється
вона і в деяких представників голкошкірих.
Відкрив цей спосіб гаструляції наш земляк
І. І. Мечников.
У процесі епіболії дрібні клітини одного кінця зародка обростають ззовні навколо великих клітин другого кінця. У такий спосіб
утворюється гаструла у представників риб. Найбільш докладно вона досліджена на прикладі класичного лабораторного організму — рибки даніо-реріо. У процесі деламінації клітини
— бластопор (первинний рот).
Бластоцель розміщена між енто- та ектодермою. У неї проникають бластомери, що дають початок третьому зародковому листку — мезодермі.
Зародкові листки і диференціація тканин. Органогенез
Зародкові листки дають початок тканинам і органам ембріонів, що розвиваються:
• з ектодерми формуються зовнішній епітелій, шкірні залози, поверхневий шар зубів, рогових лусок, нервова система;
• похідними ентодерми є епітелій середньої кишки, епітелій дихальної системи, травні залози;
• клітини мезодерми розвиваються в м’язову й сполучну (зокрема, кісткову та хрящову) тканини, канали органів виділення, кровоносну і, частково, статеву системи. Процес формування органів з певних комплексів клітин ембріона називається органогенезом (мал. 100.1). За основними напрямами ембріонального розвитку тварин, які розвиваються з тришарових зародків, поділяють на дві великі групи — первинноротих і вторинноротих. У первинноротих (молюски, членистоногі тощо) ротовий отвір у процесі розвитку формується на місці бластопору, а у вторинноротих (голкошкірі, хордові тощо) — на іншому кінці
стовбурових, тому що розташовані біля основи стовбура уявного генеалогічного дерева клітин, яке
клітин. На відміну від звичайних клітин, призначених виконувати чітко визначені функції в організмі, стовбурові клітини в процесі розвитку мають можливість набувати спеціалізації.
Стовбурові клітини розмножуються шляхом поділу, як і всі інші клітини. Відмінність
а
клітини
обмежену кількість циклів поділу. Тому говорять, що стовбурова клітина здатна до про-
ліферації, тобто до тривалого розмноження й репродукції великої кількості клітин. Стовбурові клітини здатні до диферен-
ціювання — процесу необоротної спеціалізації. Сили, що дають поштовх початку
диференціювання, можуть бути як внутрішніми, так і зовнішніми. Внутрішні сигнали управляються генами клітини, а зовнішні —
хімічними речовинами, які виділяють інші
клітини, фізичним контактом із сусідніми клітинами, а також деякими молекулами
навколишнього середовища.
похідних зародкових листків
1. Розгляньте схеми
• Ембріональний розвиток
• Розвиток з метамофозом
• Живонародження Згадайте
Провізорні органи Провізорні органи — це органи, які виникають у зародків і личинок тваринних
організмів і функціонують тимчасово до закінчення відповідного періоду розвитку. До таких органів відносять черевні кінцівки у личинок комах, зябра, ротові придатки та
хвіст пуголовків земноводних, зародкові оболонки рептилій, птахів і ссавців (мал. 101.1).
Основне призначення провізорних органів — забезпечення життєдіяльності організму до періоду формування органів, які
функціонують у дорослих особин.
Провізорні органи часто формуються
в організмів, для яких є характерним розвиток з метаморфозом. У таких випадках місце існування дорослих особин і личинок часто різняться, що потребує різних пристосувань до життя у відповідному середовищі. Так, дорослі особини багатьох амфібій (наприклад, ропух) живуть на суходолі, а личинки — у воді. І тому органи дихання вони вико-

ристовують різні. У личинок це зябра, а у
рослих особин — легені. У метеликів
час ембріогенезу формуються так звані зародкові оболонки
оболонки відсутні. До анамній відносять круглоротих, риб і земноводних. Амніотами є рептилії, птахи й ссавці.
Виникнення зародкових оболонок в амніот було пов’язано з пристосуванням до життя на суходолі. Основною їхньою функцією стало забезпечення розвитку зародка
особини. Взаємодія частин зародка між собою є
причиною так званої ембріональної індукції. Суть цього явища полягає в тому, що у певних ділянках зародка функціонують так звані клітини-організатори. Ці клітини виді-
ляють певні сигнальні молекули, які й викликають диференціацію прилеглих клітин у відповідні органи та тканини. Якщо такі клітини-організатори вилучити або перенести в іншу частину зародка, то розвиток зви-
чайних клітин цієї зони зародка піде зовсім іншим шляхом. Прикладом організації процесів розвитку в ембріонів
пластинки і її замикання у нервову трубку. Він є одним із ключових
відповідає за специфічне зв’язування білкової молекули з ДНК. Нох-гени з’явилися у предків багатоклітинних тварин ще до їх розділення на радіально-симетричних та двобічносиметричних. Вони відповідають за формування просторової орієнтації під час розвитку зародка (формується вісь голова-хвіст), порядок формування органів і тканин у часі тощо. Ембріологічні закономірності
хаотично, а у певному порядку. Більш того, вони підпорядковуються певним
ре-
морфогени. Саме ці речовини визначають, який з кінців нервової трубки є
переднім (з нього утворюється головний мозок), а який — заднім.
Гомеозисні гени
Регуляція процесів онтогенезу здійснюється на рівні геному організму шляхом активації тих чи інших комплексів генів. Наступною ланкою регуляції є організмовий рівень, на якому вона здійснюється на рівні
обміну сигналів між клітинами й тканинами.
Сигнальні молекули можуть бути гормонами, а можуть розміщуватися на поверхні клітинної мембрани і інформувати клітини про їхнє оточення, що може спрямовувати розвиток клітин у потрібному напрямку.
Практична робота
Вивчення будови яйцеклітини птаха
1. Розгляньте вміст сирого курячого яйця. Знайдіть яйцеклітину (жовток). На його поверхні знайдіть зародок, який має вигляд диска.
2. Дослідіть білкову оболонку (білок). За допомогою лупи знайдіть білкові канатики (халази).
3. Розгляньте шкаралупу, спробуйте
5. Сформулюйте висновок.
Поміркуйте
Ембріональний період розвитку
людини
Ембріональний (зародковий) період триває від моменту утворення зиготи до народження дитини (мал. 102.1). У цей період
з однієї клітини формуються всі тканини
й системи органів організму.
Зародковий розвиток людини має декіль-
ка етапів: дроблення, утворення зародкових
листків і оболонок, утворення тканин (гістогенез) і органів (органогенез). Через чотирип’ять днів після запліднення одношаровий зародок з порожниною всередині потрапляє
до порожнини матки. Після цього він занурюється в її слизову оболонку й прикріплюється до неї. Цей процес називається імплантацією.
Починається ембріональний період внутрішньоутробного розвитку. Спочатку формуються три зародкові оболонки і три зародкові листки. Зародкові оболонки утворюються із частини клітин зародка. Зовнішня оболонка має ворсинки з капілярами, через які зародок живиться й дихає. Внутрішня оболонка тонка й прозора, вона утворює міхур, порожнина якого заповнена плідною рідиною, що захищає зародок від механічних ушкоджень.
Потім відбувається формування позазародкових структур (у тому числі хоріону). Після чого розпочинається друга фаза, протягом якої формується третій шар клітин у зародку. Плацента людини Плацента людини є органом, який забезпечує постійний зв’язок між організмами


Мал. 102.2. Плацента
утворюється хоріоном — однією із зародкових оболонок. Крім забезпечення плода поживними речовинами і виведення продуктів обміну, плацента виконує ще одну функцію.
Вона маскує плід від розпізнавання імунною
системою матері, що дозволяє уникнути іму-
нологічного конфлікту (бо клітини плоду містять 50 % генів батька, на які може реагувати імунна система матері).
Під час пологів після виходу плоду відбувається процес відторгнення плаценти від стінки матки. Зазвичай він займає 15–30 хвилин. Після відторгнення плаценти поверхня матки заживає протягом кількох тижнів.
Критичні періоди розвитку. Тератогенез
Дія шкідливих речовин під час розвитку плода становить особливу небезпеку.
Це пов’язано з тим, що за короткий період
ембріонального розвитку в організмі утворюється велика кількість нових органів та
систем. Під час їх формування навіть най-
менший негативний вплив може призвести
до порушень, що матимуть тяжкі наслідки.
Такі періоди, коли формування систем і орга-

Мал. 102.3.
то це може призвести
непередбачуваного результату.
для дорослих снодійного препарату талідоміду призвело
(мал. 102.3). Таке явище, коли у результаті порушення ембріогенезу формуються аномалії організму, називають тератогенезом. Вам уже відомо про вплив паління та алкоголю на всі
Згадайте
• Ембріогенез
• Здоров’я
Ембріотехнології.
• Стовбурові клітини
• Захворювання
Мабуть, наймолодшим напрямком сучасної медицини можна вважати клітинні технології, в яких клітини є джерелом необхідних структур, наприклад пухлинних антигенів під час вакцинотерапії. Але використовувати клітину можна не тільки як джерело будь-яких субстанцій, а й для регенеративної медицини.
Особливий інтерес викликають техно-
логії, засновані на стовбурових клітинах. Здатність до необмеженого поділу і до перетворення на різні типи клітин (так звана плюрипотентність) робить їх ідеальним матеріалом для трансплантаційних методів терапії. Найбільш доступними вважаються стовбурові клітини дорослого організму. Однак реальний потенціал їх диференціювання ще слабо вивчений.
Потрапляючи в організм під час трансплантації, стовбурові клітини продовжують ділитися й самі знаходять місце, де їхня допомога найпотрібніша. Ця здатність стовбурових клітин отримала назву хоумінга. Отже, хоумінг — це здатність клітин до міграції в «потрібне місце» — «рідний» орган і тканину (у свою стовбурову нішу)
тин людини.
Химерні організми Химерами називають організми або їхні частини, що складаються з генетично різнорідних тканин. Уперше цей термін застосував німецький ботанік Г. Вінклер (1907 р.) для форм рослин, отриманих у результаті зрощення пасльону і томату. Надалі (1909 р.) Е. Баур, вивчаючи пеларгонію ряболисту, з’ясував природу химер. Розрізняють кілька типів химерних організмів:
• мозаїчні (гіперхимери) — генетично різні тканини утворюють тонку мозаїку;
• секторіальні — різнорідні тканини розташовані великими ділянками;
• периклінальні
док порушень ембріогенезу і як результат експериментів учених (мал. 103.2).
Компоненти химер можуть відрізнятися один від одного генами ядра, числом хромо-
сом, генами пластид або мітохондрій. Химер-
ні організми досить часто використовуються в наукових дослідженнях.
Принцип одержання химер зводиться го-
ловним чином до виділення двох чи більшого числа ранніх зародків і їх злиття. У тому
випадку, коли в генотипі зародків, використаних для створення химери, є відмінності у ряді характеристик, удається простежити долю клітин обох видів. За допомогою химерних мишей було, наприклад, вирішене питання про спосіб ви-
никнення в ході розвитку багатоядерних
клітин посмугованих м’язів. Вивчення химерних тварин дозволило вирішити чимало питань, і в майбутньому завдяки застосуванню цього методу з’явиться можливість вирішувати складні питання генетики й ембріології.
Репродуктивна медицина
Небіологічними та біологічними факторами, які можуть бути причиною порушення репродукції у людини, займається репродуктивна медицина.
Репродуктивна медицина — це галузь медицини, яка займається профілактикою, діагностикою та лікуванням безпліддя у людини. Вона базується на використанні найновіших розробок з ендокринології, хірургії, генетичної
чоловіка або жінки неможливе запліднення природним шляхом (непрохідність маткових труб, пошкодження сім’яних протоків тощо). Інтракорпоральне запліднення — це процес, під час якого відбувається
• Постембріональний розвиток
вими залозами. У цьому випадку постембріональний
Постембріональний розвиток — період
після народження або виходу із зародкових оболонок до настання статевої зрілості. У цей період відбуваються ріст і розвиток організму, диференціювання тканин і органів. Регуляція постембріонального розвитку здійснюється за допомогою гормонів. Суттєво впливати на розвиток можуть умови існування (температура середовища, наявність поживних речовин тощо).
Постембріональний розвиток тварин може бути прямим або супроводжуватися перетворенням — метаморфозом (мал. 104.1). За умови прямого розвитку новонароджені тварини мають усі основні риси організації дорослої особини й відрізняються меншими розмірами і недостатньо розвиненими стате-
тинних організмів індивідуальний розвиток завершується природною смертю. Безперервність життєвого циклу
ють гамети (статеві клітини), які передають спадкову інформацію організмам дочірнього покоління.

роках життя.
Тривалі життєві цикли спостерігаються і в деяких безхребетних тварин. Наприклад, личинки одного з видів південноамериканських цикад розвиваються протягом 17 років. Тривалість життєвого циклу залежить від
кількості поколінь, які послідовно змінюють одне одного протягом одного року, або кількості років, протягом яких розвивається одне
покоління.
Прості й складні життєві цикли
Розрізняють прості й складні життєві ци-
кли. Простий життєвий цикл — це цикл, у якому всі покоління не відрізняються одне
від одного. Прості життєві цикли характерні
для гідри, річкового рака, павука-хрестовика, плазунів, птахів, ссавців.
Складні життєві цикли супроводжуються
закономірним чергуванням різних поколінь
або складними перетвореннями організму під час розвитку. Так, у деяких водоростей (бурих, червоних) чергується статеве покоління, переважно гаплоїдне, з нестатевим, переважно диплоїдним. Серед вищих рослин лише у мохоподібних переважає статеве покоління, тимчасом як в інших (папоротеподібні, хвощеподібні, плауноподібні, голонасінні, покритонасінні) — нестатеве. У тварин складні життєві цикли теж не є рідкісними. Так, у життєвому циклі багатьох
найпростіших (форамініфери, споровики) і кишковопорожнинних відбувається закономірне чергування поколінь, які розмножуються статевим і нестатевим способами. Наприклад, нестатеве покоління медузи аурелії — поліпи — розмножується брунь-
Мал.
куванням, утворюючи нові поліпи. За допомогою поперечного поділу поліпи дають початок особинам статевого покоління
поліп. В інших тварин (наприклад, у
червів — сисунів, у деяких членистоногих — попелиць, дафній) у життєвому циклі чергуються покоління, які розмножуються статевим способом і партеногенетично. Чергування поколінь, які розмножуються статевим способом і партеногенетично, має важливе біологічне значення для тих організмів, які мешкають у мінливих умовах середовища і не можуть переживати несприятливі періоди в активному стані. Статеве розмноження забезпечує безперервність існування виду, а партеногенез дає змогу повною мірою використовувати сприятливі періоди для швидкого зростання чисельності виду. Чергування поколінь, які розмножуються різними способами (статевим і
• Постембріональний розвиток
• Особливості розвитку ссавців
• Тривалість життя різних організмів Згадайте
Індивідуальний розвиток
Індивідуальний розвиток людини поділяється на ембріональний і постембріональний періоди. Ембріональний період було розглянуто в попередніх параграфах.
Постембріональний період — це період життя людини після народження (мал. 105.1). Його можна розділити на кілька
етапів, тривалість яких відрізняється у чоловіків та жінок.
У житті людини виділяють такі вікові періоди:
• Період немовляти (перші 10 днів): відбувається перебудова організму, що зумовлена адаптацією до життя поза організмом матері. Руйнуються структури, пов’язані з обміном речовин через плаценту.
• Грудний період (10 днів — 1 рік) характеризується найвищими в постембріональному періоді темпами росту й розвитку всіх систем органів, а також зміцненням опор-

но-рухового апарату, формуванням великої кількості умовних рефлексів.
• Раннє дитинство (1–3 роки): спостерігаються високі темпи росту й розвитку всіх систем органів; початок самостійних активних рухів; перехід на харчування дорослою їжею; розвиток молочних зубів; початок використання мовлення. У кінці періоду темпи росту вповільнюються. • Перше дитинство (4–7 років): уповільнюються темпи росту; відбувається активне накопичення інформації про навколишній світ; формуються вміння та навички, необхідні для самостійної життєдіяльності; розвиваються постійні зуби. • Друге дитинство (8–12 років у хлопчиків, 8–11 років у дівчаток): відносно невисокі темпи росту; продовжується активне накопичення інформації про навколишній світ та формування вмінь і навичок, необхідних для самостійної життєдіяльності. • Підлітковий період (13–16 років у хлопців, 12–15 років у дівчат): початок періоду статевого дозрівання; різке збільшення темпів росту; суттєві гормональні перебудови в організмі; початок функціонування статевих систем.
• Юнацький період (17–21 рік у хлопців, 16–20 років у дівчат): завершення періоду статевого дозрівання; зменшення темпів розвитку та закінчення росту тіла.
• Зрілий вік (перший період — 22–35 років у чоловіків, 21–35 років у жінок): найбільш продуктивний період життя; розвиток здібностей досягає найвищого рівня, робота всіх систем організму є найбільш
• Старечий вік (75–90 років): в організмі відбуваються структурні, функціональні та біохімічні зміни, які значною мірою обмежують його можливості.
• Довгожительство (більш ніж 90 років):
в організмі тривають структурні, функціональні та біохімічні зміни, які обмежують його можливості.
Особливості статевого дозрівання
людини
Статеве дозрівання людини є надзвичайно
важливим процесом. Він відбувається у ді-
вчат у період від 9 до 16 років, а у хлопців —
від 11 до 18 років. У цей період відбувається формування вторинних статевих ознак і розпочинається функціонування статевої системи. Під час статевого дозрівання в організмі
відбуваються не тільки фізіологічні зміни. Суттєво змінюється поведінка. Значною мірою на це впливає коливання рівня гормонів
внаслідок перебудови тіла. Але також важ-
ливе значення мають інстинктивні програми
поведінки. Це, наприклад, є однією з причин так званого «важкого віку», коли програми
поведінки батьків і дітей можуть змушувати їх частіше конфліктувати. Тривалий період статевого дозрівання є
важливим для людини іще з однієї причини.
За такий довгий період підліток може набути
великої кількості знань. Це пов’язано з тим, що людина значну частину потрібних нави-
чок отримує через другу сигнальну систему від інших представників свого виду.
Захворювання, що передаються статевим шляхом
тримання заходів профілактики. Захворювання, що передаються статевим шляхом, можуть спричинятися: найпростішими (трихоманоз), бактеріями (гонорея та сифіліс), вірусами (генітальний герпес, СНІД), мікроскопічними грибами (кандидоз). Статевим шляхом можуть передаватися й деякі паразитарні інфекції, наприклад педикульоз. Старість і теорії старіння
та великим значенням
передачі інформації, яка
ним поколінням. Існує кілька теорій, які пояснюють явище старіння. Молекулярні теорії старіння розглядають його як результат накопичення з віком в організмі дефектних молекул білків. Інші теорії вважають, що причиною старіння є зміни генетичного апарату клітин. А теорії аутоінтоксикації пояснюють старіння як результат руйнування імунних властивостей і боротьби тканин в
Згадайте
• Властивості живих організмів
Старіння
Ріст клітин
Ріст клітин живих організмів може відбуватися з різною швидкістю. Ця швидкість залежить від особливостей будови самої клітини (клітини прокаріотів діляться швидше) та умов зовнішнього середовища.
Межі росту клітин також можуть бути різними. У більшості випадків клітини ростуть тільки до певного розміру, і цей розмір є невеликим. Але в деяких випадках ріст клітини може бути практично необмеженим. Такий ріст часто спостерігається у грибів, які здатні утворювати гігантські багатоядерні міцелії.
У людини розмір більшості клітин не-
великий. І тільки аксони нейронів можуть досягати значних розмірів.
Наслідком росту та збільшення числа
клітин у результаті їхнього поділу в багато-
клітинних тварин є розростання їхніх тканин. Під час ембріонального розвитку таким

чином здійснюється формування нових структур організму.
Розвиток клітин
Поділ еукаріотичних клітин (у тому числі клітин людини) у більшості випадків здійснюється шляхом мітозу. Після поділу частка утворених клітин може бути різною. На ранніх стадіях ембріогенезу людини клітини після
росту організмів Безпосередньо після народження в більшості багатоклітинних організмів іде період росту. Ріст — це процес збільшення розмірів і маси особини за рахунок збільшення кількості клітин або їх
тощо) —
ріст. Так, у рослин помірних широт ріст узимку припиняється, а навесні — поновлюється. Період тимчасового фізіологічного спокою в розвитку називають діапаузою. Діапауза характеризується різким зниженням інтенсивності метаболізму клітин. Вона властива комахам, багатьом хребетним. У деяких ссавців північних широт діапауза відбувається в зимовий час (ведмеді, соні, байбаки) і називається гібернацією (сплячкою). Діапауза комах може тривати від декількох годин до декількох років.
Періодичність росту є характерною озна-
кою представників членистоногих. Це пов’язано з особливостями будови їхнього організму. Він вкритий жорстким зовнішнім скелетом і тому не може змінювати свої розміри.
Таким чином, ріст цих тварин стає можливим тільки у період линьки (мал. 106.2), коли зовнішні покриви ще не затверділи й можуть розтягуватися.
Швидкість та характер росту організмів
Швидкість росту живих організмів може бути різною. Вона визначається як особливостями біології конкретного виду, так і умовами середовища. Наприклад, швидкість росту дитинчат у ссавців є суттєво більшою, ніж швидкість росту дитинчат у рептилій такого самого
розміру. А на швидкість росту гусені суттєво
впливає середня температура повітря, яка для періоду росту може бути різною у різні роки. Характер росту у різних живих організмів також може відрізнятися. Якщо ріст усіх частин тіла здійснюється рівномірно й пропо-

дитини і дорослої людини. У новонароджених
2. Зверніть увагу на розміри й колір річних кілець. Укажіть,
Згадайте
• Регуляторні системи
• Типи росту
• Поділ клітин
Регуляція росту в рослин
Для регуляції росту свого організму рос-
лини використовують фітогормони. Фітогормони — це хімічні речовини, що виробляються в рослинах і регулюють їхній ріст і розвиток. Утворюються переважно в тка-
нинах, що активно ростуть, на верхівках коренів і стебел. До фітогормонів зазвичай відносять ауксини, гібереліни й цитокініни, а іноді й інгібітори росту, наприклад абсцизову кислоту. На відміну від тваринних гормонів, фітогормони менш специфічні й часто діють у тій самій ділянці рослини, де утворюються. Фітогормони є органічними речовина -
ми з невеликою молекулярною масою, які
утворюються в малих кількостях в одних частинах багатоклітинних рослин і діють на інші їх частини як регулятори й коор-
динатори росту і розвитку. Фітогормони
здійснюють біохімічну регуляцію — най -
важливішу систему регуляції онтогенезу
в багатоклітинних рослин. Порівняно з гор -
тварин специфічність фітогормонів
людини ендогенних і екзогенних факторів На ріст організму людини може впливати велика кількість факторів. Ці фактори поділяють на дві великі групи – екзогенні (зовнішні) та ендогенні (внутрішні). До екзогенних факторів відносять характер харчування, захворювання, рівень фізичних навантажень, дію шкідливих факторів (алкоголь, паління, споживання наркотиків) тощо. Ендогенними факторами є спадковість, стадія онтогенезу, індивідуальні особливості обміну речовин, рівень гормонів, психологічний стан тощо. Дуже важливим позитивним чинником, що впливає на ріст і розвиток людини, є правильне харчування, яке задовольняє потреби в речовинах та енергії. Ці потреби визначаються такими факторами, як маса тіла, вік, рівень рухової активності людини. Очевидно, що коли людина споживає надто багато
то
людини
порушитися обмін речовин, що призведе до погіршення стану здоров’я. Щоб запобігти цьому, слід дотримуватися норм збалансованого харчування та підтримувати енергетичний баланс організму. Значний негативний вплив на ріст і розвиток людини здійснюють паління, вживання алкоголю
діяльності залоз внутрішньої секреції. Недостатня рухова активність — одна з найпоширеніших проблем сучасності. Порушення функцій організму внаслідок обмеженої рухової активності називають гіподинамією. Вона призводить до низки не-
гативних наслідків, які впливають не тіль-
ки на опорно-рухову, але й на інші системи
органів людини.
Наслідки гіподинамії:
• дистрофія (зменшення, послаблення) скелетних м’язів;
• послаблення сили скорочень серця й то-
нусу судин;
• зниження інтенсивності обміну речовин
та енергії;
• порушення кровообігу й атеросклероз;
• погіршення перетравлення й засвоєння їжі;
• послаблення імунітету;
• емоційна нестійкість.
Порушення процесів росту клітин
в організмі людини
Найбільшою загрозою для організму людини є ситуація, коли клітина втрачає
контроль над своїми поділами і починає інтенсивно ділитися. Такі порушення стають
причиною виникнення пухлин різної природи. Такі пухлини поділяють на дві великі
групи — доброякісні й злоякісні. Доброякісні пухлини — це новоутворення в організмі, що зумовлені неконтрольованим
але обмеженим розмноженням клітин, які не
поширюються в сусідні тканини (не здатні до інвазії) та віддалені органи (не утворюють метастази).
доброякісних пухлин є високою. Їх класифікують
пухлини — це новоутворення в організмі, що зумовлені необмеженим і неконтрольованим розмноженням клітин, які
лин є такі:
• швидкий неконтрольований ріст;
• проникнення в сусідні тканини
утворенням місцевих метастазів (інвазії);
• переміщення окремих клітин пухлини лімфатичними та кровоносними судинами у віддалені органи й тканини (утворення метастазів);
• отруйна дія на весь організм завдяки виробленню клітинами пухлини токсинів;
• фізичне виснаження, зменшення маси тіла;
• наявність механізмів «уникання» уваги імунної системи організму;
• наявність великої кількості мутацій у клітинах пухлини;
• низький рівень диференціації клітин пухлини;
• втрата здатності клітин до апоптозу;
• інтенсивне утворення кровоносних судин у пухлині.
Згадайте
• Самовідтворення
• Твірні тканини
• Поділ клітин
Регенерація у живих організмів
Регенерація — це здатність живих організмів відновлювати свої пошкоджені або
втрачені структури. Вона є однією з фундаментальних властивостей живих організмів, хоча й проявляється у різних організмів різною мірою. Якщо одні організми можуть самовідновитися навіть після дуже сильних пошкоджень (гідри, планарії тощо), то інші здатні до регенерації незначною мірою (нематоди).
Регенераційні властивості різних груп живих організмів різняться між собою.
У більшості випадків підвищення рівня організації та ускладнення будови організму
погіршують його здатність до регенерації.
Так, планарія регенерує краще, ніж пуголо-
вок жаби, а пуголовок жаби — краще, ніж
людина. Але ця закономірність не є всеохоплюючою. Особливості біології деяких груп суттєво погіршують можливості регенерації
організмів, які до них належать. Наприклад, нематоди і коловертки практично неспроможні до регенерації, а більш складні за будовою ракоподібні регенерують дуже ефективно. Гарна здатність до регенерації
розвинені достатньо сильно. На рівень регенераційних властивостей впливає те, що людина є високорозвиненим видом зі складною поведінкою. А в процесі еволюції регенераційні властивості таких видів зменшувалися. Це було пов’язано з тим, що добре розвинена нервова система значно знижувала ризик
утворювати нові нейрони (хоча процес цей повільний і складний) та формувати
синоптичні з’єднання.
Форми регенерації
Розрізняють дві форми регенерації — внутрішньоклітинну та клітинну. Внутрішньоклітинна регенерація відбувається всередині клітин за рахунок молекулярних механізмів. Результатом цієї форми регенерації
тощо.
Клітинна регенерація відбувається на рівні організму за рахунок поділу клітин, що дозволяє повністю або частково відновлювати тканини й органи. Так, регенерація стає потрібною після травм, захворювань, загибелі частини клітин унаслідок отруєння тощо. Залежно від задач, які вирішує в організмі людини процес регенерації, розрізняють фізіологічну й репаративну регенерацію.
Фізіологічна регенерація
Фізіологічна регенерація призначена для відновлення структур організму, які зазнають пошкоджень у ході нормальних фізіологічних процесів. Цей тип регенерації у багатьох живих організмів (у тому чис-
й людини) відбувається протягом усього
життя. Наприклад, за рахунок фізіологіч-
ної регенерації відбувається постійна зміна
епітелію кишкового тракту та покривного
епітелію; цей самий процес є основою онов-
лення еритроцитів крові, час існування яких
досить обмежений через відсутність ядра
в клітині, тощо.
Але існують структури, у яких оновлення
шляхом клітинного поділу є неможливим.
Наприклад, вузькоспеціалізовані клітини, такі як нейрони. У цих випадках регенерація відбувається шляхом поступової заміни
органел (є внутрішньоклітинною).
Репаративна регенерація
Репаративна регенерація розпочинається у випадку пошкодження або загибелі структур організму, які не є наслідком нормальних фізіологічних процесів. Такі пошкодження виникають у результаті захворювань або травм. У цьому випадку звичайна фізі-
пригнічені імунні реакції, спостерігається гіповітаміноз тощо.
ється виникнення виразок, несправжніх суглобів, колоїдних рубців тощо. Саме наслідком патологічної регенерації є розростання щільної сполучної клітини замість нормальної шкіри на місці глибоких опіків.
Практична робота
Вивчення типів регенерації
1. Розгляньте фотографії та малюнки
2.
3.
Згадайте
•
Технологія трансплантації та її проблеми
Трансплантація
організму донора. Пересаджувані органи й тканини називають трансплантатами. Трансплантація виконується хірургічними методами.
Сучасна медицина може успішно здійснювати трансплантацію багатьох органів і тканин людини: серця, нирки, кісткового мозку, легень, печінки, волосся, шкіри тощо (мал. 109.1). У випадку, коли в організм людини поміщають не живі органи й ткани-
ни, а їхні механічні або електронні аналоги, такі штучні аналоги називають імплантами, а сам процес імплантацією. Основною
організмів. Принципи біологічної етики
Трансплантація тканин і органів робить актуальною проблему біоетики — моральних аспектів застосування цих технологій. Основні принципи біоетики, яких бажано дотримуватися для недопущення етичних проблем, запропонували американські вчені Т. Л. Бічамп і Дж. Ф. Чілдрес (1985 р.). Принципи біоетики:
• принцип автономії (індивід має право розпоряджатися своїм здоров’ям);
• принцип «не зашкодь» (вимагає мінімалізації шкоди за медичного втручання);
• принцип блага (лікар зобов’язаний здійснювати дії, спрямовані на покращення стану
пацієнта);
• принцип справедливості (вимагає рівного ставлення до всіх пацієнтів і рівного доступу до ресурсів для медичної допомоги).
Використання 3D-друку у відтворенні тканин та органів
На початку 2000-х років було розпочато створення технології 3D-біопринтингу.
Ця технологія передбачає створення об’ємних моделей органів та тканин живих організмів на клітинній основі з використанням методів 3D-друку.
Перший вдалий експеримент з 3D-друком
було проведено 2006 року, коли для кількох пацієнтів надрукували сечові міхури з клітин, утворених стовбуровими клітинами самих пацієнтів. Зараз технологія 3D-друку
людських органів проходить стадію клінічних випробувань та експериментальних досліджень. Поки що вона не впроваджена

у широку медичну практику. Успішні дослідження з 3D-друку та
нин, кожна з яких
особливих умов 3D-друку. Перший комерційний біопринтер було створено 2014 року. Він не призначений для створення органів для трансплантації. Але тканини й органи, які можна виготовити з допомогою цього приладу, використовують фармацевтичні компанії. Вони випробовують на таких надрукованих
багатоклітинних структур, що пристосовані для поширення
тинних структур
Система XY XX; XY (ссавці)
Система X0 XX; X0 (таргани)
Система ZW ZW; ZZ (птахи)
Система Z0 Z0; ZZ (молі)




Завдання до теми «Біорізноманіття»
Завдання для індивідуальної роботи
1. Класифікуйте й визначте систематичне положення в системі органічного світу одного із запропонованих видів: мухомор червоний, ведмідь бурий, пшениця тверда.
2. Складіть характеристику однієї із запропонованих груп організмів: віруси, бактерії, археї, еукаріоти.
3. Складіть характеристику за видовими критеріями одного із запропонованих видів: лось, горобець польовий, лисиця, колорадський жук, білий гриб, мукор, дуб звичайний, картопля, шипшина, сосна звичайна.
4. Поясніть, як різні види природокористування можуть вплинути на стан генетичного, видового та екосистемного біорізноманіття. Представте свою відповідь у вигляді презентації.
5. Створіть презентацію на одну з тем, вибравши вид, поширений у вашому регіоні, та зробіть доповідь з використанням цієї презентації: а) Вид-космополіт на території України; б) Реліктовий вид на території України.
Завдання для роботи в групах 6. Складіть порівняльну характеристику двох груп організмів та представте її у вигляді презентації. Групи організмів для порівняння: одноклітинні й багатоклітинні еукаріоти, археї і бактерії, голонасінні й покритонасінні, первиннороті й вториннороті. 7. Створіть презентацію «Історія інвазії», у якій опишіть інвазію кількох видів на нову
територію (кожний член групи описує інвазію окремого виду), та зробіть доповідь із використанням цієї презентації. Інвазія може бути як пов’язаною з діяльністю людини, так і відбуватися без антропогенного впливу.
Теми навчальних проектів
1. Здійснення оцінки стану місцевої водой-
4.
даної місцевості методами ліхеноіндикації.
Завдання до теми «Обмін речовин і перетворення енергії»
Завдання для індивідуальної роботи
1. До яких наслідків для людини може призвести нестача в раціоні сполук Феруму? Як можна запобігти такій нестачі? Складіть відповідні рекомендації та представте їх у
гляді презентації.
2. Складіть схеми енергетичного
рекомендації щодо вживання цих сортів
для людей з різними порушеннями обміну речовин чи захворюваннями травної або видільної систем (за вашим вибором). Представте ваші результати у вигляді презентації.
5.
6.
Завдання до теми
«Спадковість і мінливість»
Завдання для індивідуальної роботи
1. Обґрунтуйте твердження про те, що генотип людини є цілісною інтегрованою системою.
Свої висновки та їхню аргументацію представте у вигляді презентації.
2. У тропічних лісах Африки живуть дві групи пігмеїв — племен, представники яких
мають низький зріст. Аналіз геному представників однієї з цих груп виявив, що їхній низь-
кий зріст забезпечує комплекс генів, кожний з яких має мутантний варіант, відмінний від варіанта цього гена у людей нормального зросту. Аналіз геному іншої групи пігмеїв виявив, що цей комплекс генів у них точно такий, як і у людей з нормальним зростом, і мутантних варіантів генів не містить. Запропонуйте та обґрунтуйте гіпотезу, яка пояснює цей факт, та представте свою відповідь у вигляді презентації.
3. Складіть родоводи людей, які проілюструють основні типи успадкування ознак (повне та неповне домінування, кодомінування, аутосомно-рецесивне та аутосомно-домінантне, зчеплене, зчеплене зі статтю), та представте їх у вигляді схем.
4. Використовуючи конкретні приклади, порівняйте моногенне та полігенне успадкування ознак у людини. Представте свою відповідь у вигляді презентації.
5. Використовуючи конкретні приклади, складіть порівняльну характеристику різних способів визначення статі та подайте її у вигляді презентації.
Завдання для роботи у групах
6. Проаналізуйте позитивні та негативні аспекти профілактики й терапії спадкових захворювань людини, результати подайте у вигляді презентації.
7. Складіть перелік
2.
Завдання до теми «Репродукція та розвиток організмів» Завдання для індивідуальної роботи
1. Поясніть, чому після пошкоджень шкіри на ній можуть утворюватися рубці (шрами)? Чи може людина позбутися шрамів? Свої висновки та їхню аргументацію
2.
3.
зробіть та
прогноз щодо
вості їхнього застосування у профілактиці онкологічних захворювань людини. Представте свою відповідь у вигляді презентації.
4. Поясніть, як впливає спосіб життя на формування людського організму та репродуктивне здоров’я. Складіть переліки факторів, які позитивно й негативно впливають на них. Представте свою відповідь у вигляді презентації.
5. Складіть характеристику вірусів,
дів і пріонів та подайте її у вигляді презентації. Завдання для роботи у групах
6.
3D-біопринтинг 227
3D-друк 227
β-окиснення жирних кислот 86 SAR 29
X-хромосома 132, 202
Y-хромосома 132, 202
Абіотичний компонент 4
Австралійське царство 40
Автоліз 73
Автотрофи 53
Аеробне дихання 84
Акліматизація 42
Активний транспорт 54
Активний центр 80
Алантоїс 210
Алель дикого типу 124
Алель 124
Аллотрансплантація 226
Алометричний тип росту 221
Алостерична регуляція 81
Альбуміни 62
Альтернативний сплайсинг 89
Альфа-різноманіття 20
Амебозої 29
Амілоїди 160
Аміноацил-тРНК 90
Амітоз 178
Амніон 210
Амніоти 39, 210
Аморфеї 28
Ампліфікація 123
Амфібії 38
Амфібластула 207
Анаболізм 52
Анаеробне дихання 82
Аналіз результатів дослідження 12
Аналізуюче схрещування 125
Анамнії 38, 210
Анафаза 171
Анеуплоїдія 172
Анізогамія 188
Антенний комплекс 94
Антипорт 54
Антоцеротові 31
Антропогенетика 147
Антропогенно-змінене середовище 6
Апогамія 199
Апоміксис 195, 198
Апопласт 57
Апоптоз 179
Арктогея 40
Археї 24, 26
Археплатиди 29
Асгардархеї 28
Асиміляція 52
Аски 190
Аскоспори 190
Аутосоми 202
Аутотрансплантація 226
Аутофагоцитоз 73
Б
агатоклітинні тварини 36
Базидіальні гриби 34
Базидії 190
Базидіоспори 190
Бактерії 24, 26
Бактеріородопсин 98
Бактеріофаг 153
Бактеріохлорофіл 98
Безкисневий (аноксигенний) фотосинтез 98
Безпліддя 201
Безхлорофільний фотосинтез 98
Безщелепні 38
Бета-різноманіття 20
Білатеральна симетрія 36
Білки 48
Бінарний поділ 162
Біогеографія 21
Біологічна етика 227
Біологічна індикація, або
біоіндикація 22
Біологічна номенклатура 14
Біологічна система 4
Біологічна цінність продукту харчування 50
Біологічне різноманіття, або
біорізноманіття 20
Біологія 2
Біорізноманіття 20
Біотичний компонент 4
Біохімічний метод 146
Біоценоз 4
Бластомери 206
Бластоциста 207
Близнюковий метод 146
Бродіння 83
Варіаційна крива 141
Варіаційний ряд 141 Вегетативне розмноження 182, 186
Везикулярний транспорт 55
Взаємодія алелів 128
Вид 18
Види-двійники 19
Видоутворення 145
Визначення статі 194
Відділи-кандидати 25
Відсадка 187
Вікова структура популяції 142
Віріон 152
Віроїди 161
Властивості живого 3
Внутрішнє запліднення 197, 200 Внутрішньоклітинна регенерація 224
Внутрішньоклітинне травлення 72
Ворсинки 76
Вроджений імунітет 156
Вставні категорії 17
Вторинні лізосоми 73
Вторинні статеві ознаки 188
Вториннороті 37, 208
Вуглеводи 48
Гамети 165, 182
Гаметогенез 190
Гаметофіт 30
Гамма-різноманіття 20
Гаплоїдний набір хромосом 165
Гаструляція 208, 212
Гелікази 119
Гемізигота 124, 133
Гемоглобін 64
Гемолімфа 60
Гемофілія 149
Гемоціанін 65
Гемула 185
Ген 120, 124
Генеалогічний метод 146
Генеративний період 204
Генеративні мутації 138
Генетика людини 146
Генетика 122
Генетична карта хромосоми 131
Генетичне консультування 149
Генетичний код 90
Гени, зчеплені зі статтю 132
Генна терапія 181
Генні захворювання 149
Генні мутації 139
Геном 121
Геномні захворювання 148
Геномні мутації 139
Генотип 124, 134
Генофонд 143
Географічне (алопатричне) видоутворення 145
Гермафродитизм 203
Гетерогаметна стать 132
Гетерозигота 124
Гетерозис 136
Гетероплоїдія 139
Гетеротрофи 53
Гібрид 125
Гібридологічний аналіз 125
Гідатоди 109
Гідробактерії 27
Гідролімфа 60
Гінкгові 32
Гіперосмотична осморегуляція 106
Гіподинамія 223
Гіпоосмотична осморегуляція 106
Гіпотеза походження вірусів 158
Гіпотеза 8
Гістони 130
Гіфи 34
Глікогенез 102
Гліколіз 82
Глобуліни 62
Гнетові 32
Голантарктичне царство 40
Голарктичне царство 40
Голівка сперматозоїда 192
Головохордові 38
Голозойне живлення 70
Голонасінні рослини 32
Гомеозисні гени 211
Гомеостаз 6, 52
Гомогаметна стать 132
Гомозигота 124
Горизонтальне перенесення генів 159
Гормони 222
Грибоподібні організми 34
Грудний період 218
Група зчеплення 130
Гуморальна регуляція 7
Гутація 109
Ґендер 203
Давні бактерії 27
Дальтонізм 149
Дводольні 33
Дезамінування амінокислот 87
Денатурація 92
Детритофаги 70
Дигібридне схрещування 125
Дизиготні близнюки 146
Диплоїдний набір хромосом 165
Дисертація 12
Дисиміляція 52
Дискобластула 207
Диференціація клітин 220
Диференціація тканин
Дифузія 54
Дихальні пігменти 64
Діапауза 221
Діафоретики 29
ДНК-технології 143
Доброякісні пухлини 223
Довгожительство 219
Домен 24
Домінантні мутації 138
Домінування 128
Дослідження 10
Дрейф генів 144
Дроблення 206, 212
Друге дитинство 218
Екваційний поділ 175
Екзогенні фактори 222
Екзон 120
Екзоцитоз 55
Екологічне (симпатричне) видоутворення 145
Екологічне прогнозування 23
Екологія 2
Екосистема 4, 40
Екскавати 28
Екскрети 104
Екскреція 104
Експеримент 8
Екстракорпоральне запліднення 215
Ектодерма 208
Електроннотранспортний
(дихальний) ланцюг 84
Елементарні фактори еволюції 144
Елонгація 90
Ембріогенез 206
Ембріональна індукція 211
Ембріональний період 204, 212, 218
Ембріональний розвиток 212
Ембріональні стовбурові
клітини (ЕСК) 214
Ембріотехнології 214
Ембріофіти 30
Емпіричні дослідження 8
Ендеміки 41
Ендогенні фактори 222
Ендомітоз 173
Ендосперм 197
Ендоцитоз 55
Енергетична цінність продукту
харчування 50
Енергетичний обмін 52
Ентодерма 208
Епістаз 135
Еуархеї 27
Еукаріоти 24
187
70
127 Закон
144
чистоти гамет 126 Закони Г. Менделя 126 Залишкове тільце 73
Запліднення 196, 200
Зародкові листки 208
Зародкові оболонки 39
Зародок 206, 212 Захворювання, що передаються статевим шляхом 219
Збалансоване харчування 50
Зворотна транскрипція 118
Зворотне схрещування 125
Зелені залози 105
Зигота 196, 200, 206
Злоякісні пухлини 223
Зовнішнє запліднення 197
Зовнішнє травлення 75
Зрілий вік 218
Зрілість 204
Зчеплені гени 130
Зябра 66
Ізогамія 144, 188
Ізометричний тип росту 221
Ізотрансплантація 226
Імплант 226
Імплантація 226
Імунний бар’єр 226
Інвазійний вид 42
Інвазія 42
Інвентаризація 22
Індуковані мутації 138
Ініціація 90
Інкубаційний період 156
Інтервал варіювання 141
Інтерфаза 166
Інтракорпоральне запліднення 215
Інтродукований вид 42
Інтродукція 42
Інтрон 120
Істинний гермафродитизм 203
Капсид 152
Капсомер 152
Капське царство 40
Карбгемоглобін 64
Карбоксигемоглобін 64
Каріокінез 170
Каріотип 131, 164
Катаболізм 52, 82
Квітка 33
Кисневий (оксигенний) фотосинтез 98
Кладистика 16
Клітинна інженерія 181, 226
Клітинна регенерація 225
Клітинне дихання 82
Клітинний транспорт 54
Клітинні культури 180
Клонування 184
Кодомінування 128
Кодон 90
Кодуюча ділянка 120
Комбінативна мінливість 136, 176
Комплементарність 134
Кон’югація бактерій 163
Кон’югація гомологічних хромосом 174
Кон’югація 136, 194
Контрацепція 201
Конференція 13
Концепція виду 19
Копрофаги 71
Кортикальна реакція 200
Космополіти 41
Коферменти 80
Критерії життя 2
Критерій виду 19
Критичні періоди розвитку 213
Кров 60
Кровоносна система 60
Кросинговер 131, 174
Кросоверна гамета 131
Ксенотрансплантація 226
Ксилема 58
Латентний період 204
Легені 67
Листопад 109
Личинка 210
Лізосоми 72
Ліпіди 48
Ліпогенез 103
Ліпопротеїни 62
Локіархеї 28
Локус 124
Макросистематика 25
Макрофільні рослини 31
Мальпігієві трубочки 105
Математична обробка даних 9
Маточка 191
Матричний синтез 88
Мегаспора 191
Медична генетика 147
Мезодерма 208
Мейоз 174, 194
Менструальний цикл 193
Мета дослідження 10
Метаболізм 52
Метаболічна інженерія 113
Метаболічний шлях 80
Метагеномний аналіз 25
Метаморфоз 216
Метанефридії 104
Метафаза 171
Метод білкового електрофорезу 143
Методи генетики 123
Міграція 144
Мікроворсинки 77
Мікроспора 191
Мікрофільні рослини 31
Міксотрофи 53
Мінливість 123
Міоглобін 64
Мітоз 170
Міцелій 34
Множинний алелізм 128
Множинний поділ 184
Моделювання 9, 146
Модифікації 140
Модифікаційна мінливість 140
Молекулярно-генетичні
маркери 123
Моніторинг 22
Моногенна ознака 134
Моногібридне схрещування 125
Монографія 12
Монозиготні близнюки 146, 207
Моносомія 139
Монофілетичний таксон 16
Морфогени 211
Муковісцидоз 149
Мутагенні фактори 139
Мутаційна мінливість 136
Мутація 138, 144
Набутий імунітет 156
Направлений фактор 145
Насінина 32, 206
Насінні рослини 32
Наука 8
Наукова теорія 8
Науковий звіт 12
Наукові твори 12
Наукометрична база даних 13
Неалельні гени 134
Нейрула 211
Нейруляція 211
Некодуюча ділянка 120
Некроз 178
Некрофаги 70
Ненаправлений фактор 145
Необмежений ріст 220
Неогея 40
Неотенія 199
царство 40
128
Несправжні гриби 35
Нестатеве розмноження 182, 184 Нефрони 105
Нециклічний потік електронів (Z-схема) 95
Нирки 105
Норма реакції 140 Нотогея 40
Нуклеїнові кислоти 48
Нуклеосома 168
Об’єкт дослідження 10 Обмежений ріст 220
Обмін речовин 52
Однодольні 33
Окисне фосфорилювання 85
Оксигемоглобін 64 Онтогенез 204
Онтогенетична мінливість 136
Оогамія 188
Оогенез 191, 193
Оогоній 191
Ооцит 191
Оперативний моніторинг 22
Оперон 120
Опістоконти 29
Опосередкований зв’язок 4
Органогенез 208
Ортомітоз 173
Осморегуляція 106
Осмос 56
Осмотичний тиск 56
Осмотрофне живлення 71
Палеогея 40
Палеотропічне царство 40
Папороті 31
Паразитичне живлення 71
Парасексуальний процес 195
Парафілетичний таксон 16
Партеногенез 195, 198
Пасивний транспорт 54
Патент 12
Патологічна регенерація 225
Педогенез 198
Пенетрація 200
Первинні лізосоми 72
Первинні статеві ознаки 188
Первиннороті 37, 208
Період немовляти 218
Періодичний ріст 221
Перше дитинство 218
Печіночники 31
Пиляк 190
Підлітковий період 218
Піноцитоз 55
Плазма крові 62
Плазмодії 35
Планування дослідження 10
Пластичний обмін 52, 88
Плауни 31
Плацента 212
Плевромітоз 173
Плейотропія 129
Плече хромосоми 131
Плід 212
Повне домінування 128
Повне дроблення 207
Подвійне запліднення 33, 197
Поділ 184
Позаклітинне травлення 74
Позаядерна частина геному 121
Покривники 38
Покритонасінні рослини 32
Полегшена дифузія 54
Полігібридне схрещування 125
Поліембріонія 189
Полімерази 119
Полімеразно-ланцюгова реакція (ПЛР) 123
Полімерія 135
Полімерні гени 135
Поліплоїдія 139, 172
Полірибосоми (полісоми) 91
Поліфілетичний таксон 16
Популяційна генетика 143
Популяційні хвилі 144
Популяційно-статистичний метод 146
Популяція 142
Порожнинне травлення 76
Порушення запліднення 200
Порушення ко’югації хромосом 177
Постгенеративний період 204
Постембріональний період 204, 218
Постембріональний розвиток 216
Посттрансляційні модифікації 93
Похилий вік 218
Пребіотики 79
Прегенеративний період 204
Предмет дослідження 10
Представлення результатів дослідження 12
Препринт 12
Природжені вади 148
Природна система живого світу 14
Природне запліднення 196
Природне середовище 6
Природний добір 144
Пристінкове травлення 76
Пріони 160
Пробанд 147
Пробіотики 79
Проблема дослідження 10
Провізорні органи 210
Продукт реакції 80
Прокаріоти 26
Промотор 120
Пропорції тіла 221
Простий життєвий цикл 217
Протеоархеї 27
Протеосоми 73
Противірусні вакцини 157
Противірусні препарати 157
Протонефридії 104
Профаза 171
Процесинг РНК 88
Прямий зв’язок 4
Прямий розвиток 216
Псевдоплазмодії 35
Псилоти 31
Птахи 39
Пуповина 212
Радіальна симетрія 36
Радіальний (близький) транспорт 57
Раннє дитинство 218
Реакційний центр 94
Регенерація 224
Регуляторна ділянка 120
Регуляторний центр 81
Регуляція 222
Редукційний поділ 175
Реінтродукція 43
Рекомбінація 194
Ренатурація 92
Репаративна регенерація 225
Реплікація 118
Репродуктивна медицина 215
Репродукція 182
Рептилії 39
Рецензовані твори 12
Рецесивні мутації 138
Риби 38
Рибосоми 91
Рибулозобісфосфаткарбоксилаза (RuBisCo) 97
Рівні організації життя 5
Ріст 220
Родовід 147
Розвиток з метаморфозом 210
Розвиток з неповним перетворенням 216
Розвиток з перетворенням 216
Розвиток з повним перетворенням 216
Розвиток 220
Розмноження бульбами 186 Розмноження виводковими
186
186
Серповидноклітинна анемія 149
Сестринські хроматиди 170 Симбіотрофне живлення 71
Симпласт 57
Симпорт 54
Синдром Дауна 148
Синдром Едвардса 148
Синдром Кляйнфельтера 148
Синдром Лежена (синдром котячого крику) 148
Синдром Патау 148
Синдром Шерешевського — Тернера 148
Система 4
Систематика 14
Ситоподібні клітини 59
Ситоподібні трубки 59
Сібси 147
Сім’яник 191
Складний життєвий цикл 217
Слизовики 35
Соматичні клітини 165
Соматичні мутації 138
Спадкова мінливість вірусів 137
Спадкова мінливість 136
Спадкові захворювання 148
Спадковість 123
Сперматогенез 191, 192
Сперматогоній 191
Сперматозоїд 191, 192, 196, 200
Сперматоцит 191
Сплайсинг 89
Спонтанні мутації 138
Спорогенез 190
Спороутворення 163
Спорофіт 30
Спостереження 8
Справжні гриби 34
Справжні мохи 31
Справжні тварини 36
Ссавці 39
Старечий вік 219
Старіння 204
Старість 219
Статева структура популяції 142
Статеве дозрівання 219
Статеве розмноження 182, 188, 194
Статевий процес 182, 189
Статеві залози 192
Статеві клітини 189
Статеві хромосоми 132, 194, 202
Статобласт 185
Стаття 12
Стать 188
Стовбурові клітини 209, 214
Стрес 7
Субстрат реакції 80
Субстрати метаболізму 52
Субстратне фосфорилювання 82
Судини ксилеми 58
Судинні рослини 31
Сумчасті гриби 34
Суперкапсид 152
Таксон 16
Таксономічна ієрархія 17
Таксономія 14
Тези 13
Телофаза 171
Темнова фаза фотосинтезу 96
Темп росту 220
Теоретичні дослідження 8
Теорія мутацій 138
Теорія старіння 219
Тератогенез 213
Термінатор 120
Термінація 91
Терробактерії 27
Тільце Барра 148
Тільце 73
Топоізомерази 119
Тотипотентність 207
Трансдукція 137, 194
Транскрипція 88, 118
Трансляція 90, 118
Транспірація 58, 108
Трансплантація 226
Трансформація 137, 194
Трахеї 66
Трахеїди ксилеми 58
Трисомія 139
Тургорний тиск 56
Уніпорт 54
Успадкування, залежне від статі 133
Фаготрофи 36
Фаготрофне живлення 71
Фагоцитоз 55
Факт 8
Фактори еволюції 144
Фауна 21
Фауністичні царства 40
Фенілкетонурія 149
Фенотип 124
Ферментативний каталіз 80
Ферменти 80
Фізіологічна регенерація 225
Філогенетика 17
Філогенетичне дерево 17
Фітогормони 222
Флоема 58
Флора 21
Флористичні царства 40
Фолдінг 92
Фоновий моніторинг 22
Форми життя 3
Фотоліз води 94
Фотосинтез 94
Фотосистеми І і ІІ 94
Фототрофи 53
Фотофосфорилювання 95
Фрагментація 184
Харчова цінність продукту харчування 50
Харчовий раціон 50
Хвіст сперматозоїда 192
Хвойні 32
Хвощі 31
Хемосинтез 100
Хемотрофи 53
Хибний гермафродитизм 203
Химерні організми (химери) 214
Хлорофіл 94
Хорда 38
Хордові 38
Хорея Гантінгтона 148
Хоріон 210
Хоумінг 214
Хребетні 38
Хроматида 131
Хроматин 168

Хромосома 130
Хромосомна теорія спадковості 130
Хромосомні захворювання 148
Хромосомні мутації 139
Царства 40
Целобластула 207
Центральна догма
молекулярної біології 118
Центромера 131
Цикл Кальвіна 96 Цикл Кребса 84
Цикл трикарбонових кислот 84
Циклічний потік електронів 95
Цитогенетичний метод 146
Цитокінез 170, 172 Цитоплазматичні мутації 138
Частота алеля 145
Чергування поколінь 217 Чисельність популяції 142
Шаперони 92
Шийка сперматозоїда 192
Штучна система
живого світу 14
Штучне запліднення 196
Штучне середовище 6
Щ
еплення 187
Щільність популяції 142
Ювенільний етап 204
Юнацький період 218
Ядерна частина геному 121
Ядерні мутації 138
Яєчка 192
Яєчник 191, 192
Яйце 39
Яйцеклітина 191, 192, 196, 200
Анья, Спанг 28
Аристотель 14
Бетсон, Вільям 122
Бовері, Теодор 130
Вайнберг, Вільгельм 143, 144 Виноградський, Сергій Миколайович 100
Вілсон, Едвард Осборн 20
Гайдузек, Карлтон 161 Геккель, Ернст 2, 14, 211 Гершензон, Сергій Михайлович 119
Жакоб, Франсуа 81
Івановський, Дмитро Йосипович 152
Кальвін, Мелвін 96 Копленд, Герберт 15
Коренс, Карл 122
Коржинський, Сергій Іванович 138
Кребс, Ханс Адольф 84 Крік, Френсіс 118
Лавджой, Томас 20 Ламарк, Жан Батист 2
Лінней, Карл 14
Мендель, Грегор 122, 126
Мітчелл, Пітер 85
Моно, Жак 81
Морган, Томас Хант 130
Мюлер, Фріц 211
Мюнхгаузен, Отто фон 14
Неккер, Ноель Жозеф де 14
Понтекорво, Гвідо 195
Райт, Сьюал 143
Сайна, Едл 28
Саттон, Волтер 130
Столлер, Роберт 203
Уайттейкер Роберт 15
Уголєв, Олександр Михайлович 77
Фішер, Рональд 143
Фріз, Хуго де 122, 138
Харді, Голфрі 143, 144 Холдейн, Джон 143
Чермак, Еріх 122 Четвериков, Сергій Сергійович 143
Знайомство з підручником ........................... 3
Тема 1. Вступ
§ 1. Біологія та екологія. Форми життя ...... 4
§ 2. Біологічні системи.
Рівні організації життя ....................... 6
§ 3. Середовище життя. Поняття гомеостазу ............................. 8
§ 4. Наука та науковий метод пізнання ...... 10
§ 5. Принципи планування біологічного та екологічного дослідження та науковий метод пізнання ................ 12
§ 6. Аналіз та представлення результатів наукових досліджень ......... 14
Тема 2. Біорізноманіття
§ 7. Біологічна систематика ....................... 16
§ 8. Створення систем живих організмів..... 18
§ 9. Вид як базовий таксон сучасної систематики .......................... 20
§ 10. Біорізноманіття 22
§ 11. Дослідження біорізноманіття 24
§ 12. Сучасна система живого світу ............. 26
§ 13. Прокаріотичні організми ..................... 28
§ 14. Сучасна систематика еукаріотів ........... 30
§ 15. Наземні рослини ................................ 32
§ 16. Різноманітність насінних рослин ......... 34
§ 17. Гриби та грибоподібні організми ......... 36
§ 18. Тварини............................................. 38
§ 19. Анамнії та амніоти ............................. 40
§ 20. Екосистемне біорізноманіття ............... 42
§ 21. Зміни біорізноманіття ......................... 44
Основні положення теми «Біорізноманіття» .. 47
Тема 3. Обмін речовин
і перетворення енергії
§ 22. Органічні та неорганічні сполуки, необхідні для організмів 48
§ 23. Потреба людини в речовинах і хімічних елементах
§ 31. Надходження
§ 32. Надходження газів та поживних речовин до організмів рослин і грибів .................................. 68
§ 33. Типи гетеротрофного живлення ........... 70
§ 34. Внутрішньоклітинне травлення ........... 72
§ 35. Позаклітинне і зовнішнє травлення ..... 74
§ 36. Порожнинне та пристінкове травлення
44. Посттрансляційне
§ 45. Фотосинтез. Світлова фаза .................. 94
§ 46. Фотосинтез. Темнова фаза ................... 96
§ 47. Фотосинтез у прокаріотів. Планетарне значення фотосинтезу ....... 98
§ 48. Хемосинтез ...................................... 100
§ 49. Утворення глікогену. Біосинтез ліпідів .............................. 102
§ 50. Виділення у тварин .......................... 104
§ 51. Осморегуляція.................................. 106
§ 52. Виділення у рослин .......................... 108
§ 53. Роль виділення у підтриманні гомеостазу ....................................... 110
§ 54. Взаємозв’язок метаболічних шляхів ............................................ 112
§
положення теми
речовин і перетворення енергії»..... 117
Тема 4. Спадковість
§ 61. Взаємодія алелів. Множинний алелізм ......................... 128
§ 62. Хромосомна теорія спадковості.
Кросинговер 130
§ 63. Генетика статі .................................. 132
§ 64. Генотип і взаємодія генів .................. 134
§ 65. Мінливість ознак.............................. 136
§ 66. Мутації ........................................... 138
§ 67. Модифікаційна мінливість ................ 140
§ 68. Популяційна генетика ...................... 142
§ 69. Елементарні процеси еволюції.
Видоутворення ................................. 144
§ 70. Генетика людини ............................. 146
§ 71. Спадкові захворювання та їх профілактика ........................... 148 Основні положення теми «Cпадковість і мінливість» ....................... 151
Тема 5. Репродукція та розвиток організмів
§ 72. Будова вірусів 152
§ 73. Життєдіяльність вірусів .................... 154
§ 74. Вірусні інфекції ............................... 156
§ 75. Віруси й еволюція ............................ 158
§ 76. Пріони й віроїди .............................. 160
§ 77. Репродукція прокаріотичних клітин .. 162
§ 78. Репродукція еукаріотичних клітин .... 164
§ 79. Життєвий цикл клітин. Інтерфаза ..... 166
§ 80. Структурна організація хроматину .... 168
§ 81. Мітотичний поділ ............................. 170
§ 82. Цитокінез. Регуляція
і порушення процесу мітозу .............. 172
§ 83. Мейоз .............................................. 174
§ 84. Біологічне значення мейозу. Порушення мейозу ........................... 176
§ 85. Амітоз. Старіння і загибель клітин .... 178
§ 86. Клітинні технології в біології
та медицині ..................................... 180
§ 87. Репродукція організмів ..................... 182
§ 88. Нестатеве розмноження ................... 184
§ 89. Вегетативне розмноження та його використання 186
§ 90. Статеве розмноження і статевий процес............................ 188
§ 91. Гаметогенез .................................... 190
§ 92. Статеві залози. Гаметогенез у людини ..................... 192
§ 93. Еволюція статевого розмноження ..... 194
§ 94. Запліднення ................................... 196
§ 95. Особливі форми розмноження .......... 198
§ 96. Запліднення у людини .................... 200
§ 97. Стать у людини .............................. 202
§ 98. Онтогенез багатоклітинних організмів ......................................
100. Гаструла.

І. Г. Шахова
Пліско. Макет Кожанова І. А. Комп’ютерна верстка А. О. Цибань. Коректор Н. В. Красна. Художнє оформлення В. І. Труфен, А. О. Цибань. В оформленні підручника використано ілюстрації Д. В. Леонтьєва (7.1–7.5, 12.1, 14.2, 15.1, 18.2, с. 47, 25.1–25.3, 26.3, 27.2, с. 61, 32.1, 34.2, 34.3, 36.1, 36.2, 37.2, 40.2, 42.3, 44.2, 45.1, 47.3, 50.1, 51.1–53.1, с. 116, с. 117, 61.1, 62.2, 64.2, 67.1, 69.1, 69.2, 80.2, 80.3, 86.2, 89.1, 90.1, 91.1, 95.2, 99.2, 106.1, с. 229), а також зображення, розміщені в мережі Інтернет для вільного використання
Підписано до друку 23.07.2018. Формат 84×108/16.
Папір офсетний. Гарнітура Шкільна. Друк офсетний. Ум. друк. арк. 25,2. Обл.-вид. арк. 24,2. Тираж 58726. прим. Зам. № 6007-2018.
ТОВ Видавництво «Ранок», вул. Кібальчича, 27, к. 135, Харків, 61071. Свідоцтво суб’єкта видавничої справи ДК № 5215 від 22.09.2016. Адреса редакції: вул. Космічна, 21а, Харків, 61145. E-mail: office@ranok.com.ua. Тел. (057) 719-48-65. Тел./факс (057) 719-58-67.